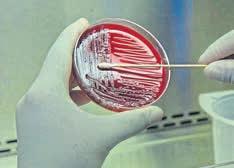

Alles für die Gesundheit
Körperliche Fitness und inneres Wohlbe�nden, auch in Bezug auf Ernährung und P�ege.

„Mit der Krankheit umgehen lernen“
Endometriose ist eine der häufigsten gynäkologischen Erkrankungen und mit starken Schmerzen verbunden. Influencerin Anna Adamyan kennt diese leider zu gut.


13


16 APR



Zwischen Angst und Zuversicht
Wie der Hautkrebs das Leben von Moderatorin Susanne Klehn verändert hat, was sie Betroffenen rät und warum Aufklärung im Kindesalter so wichtig ist.




Mit Sicherheit groß werden

Die Tasse Kaffee kann für Krabbelkinder schnell lebensgefährlich werden. Worauf Eltern sonst noch achten sollten
„Ich esse mit Emotionen“



Kochen kann jeder und der Zeitaufwand in der Küche wird überschätzt, sagt TV-Koch Alexander Herrmann. Sein Tipp für Anfänger: Einfach mal anfangen.
Homeoffice: Locker bleiben statt steif sitzen

Der Rückenspezialist Prof. Dr. Dietrich Grönemeyer spricht im Interview darüber, wie man im Homeoffice Rückenschmerzen vermeiden kann.
 Großes Interview | Anna Adamyan
Großes Interview | Susanne Klehn
Großes Interview | Anna Adamyan
Großes Interview | Susanne Klehn
12 44 8 32 54
Eine unabhängige Kampagne von Contentway
Lesen Sie weitere interessante Artikel auf contentway.de
Welt | März 2023
For a strong and healthy society. –
Get your ticket fibo.com 23 Exhibition Centre Cologne
WEITERE INHALTE
Familiengesundheit
6. Schwangerschaft
10. Babynahrung
14. Frauenkrankheiten
18. Menstruation
Lebensmittel
29. Clubkultur
30. Teegenuss
31. Gesunde Snacks
33. Grillen
Hautgesundheit
36. Dr. Emi Arpa
38. Hauttypen
42. Hautkrankheiten
47. Dr. med. Miriam Rehbein
ALLES FÜR DIE GESUNDHEIT
Contentway präsentiert Ihnen die neue Kampagne „Alles für die Gesundheit“.
Unser Körper und unsere Seele sind das höchste Gut, was wir haben. Darum sollten wir ein Leben lang gut auf ihn aufpassen und lernen, auf ihn zu hören –egal in welchem Alter. Bereits mit Beginn der Schwangerschaft steht die Gesundheit von Mutter und Kind an erster Stelle.
Dabei gibt es viele Dinge, auf die geachtet werden sollte, wie bspw. die Ernährung und sportliche Aktivitäten der Mutter. Die Sorge um das Wohlbefinden des Kindes ist ein stetiger Begleiter im Leben der Eltern. Doch auch sie sind Menschen mit Bedürfnissen und einer eigenen physischen und psychischen Gesundheit, die es aufrecht zu erhalten gilt.
Vorsorge ist hier ein wichtiges Thema, dessen Bedeutung man nicht unterschätzen sollte. Je früher man lernt auf seinen Körper zu hören, desto höher sind die
Chancen auf eine frühzeitige Diagnose und einen milden Krankheitsverlauf. Auch der Lebensstil spielt eine erhebliche Rolle im Hinblick auf die Ernährung, Fitness, Körperpflege, Entspannung u.v.m. Bei all der körperlichen Betätigung und Anspannung im Alltag sollte man nicht vergessen, sich auch mal bewusst Zeit für sich zu nehmen und den Fokus auf mentale Gesundheit legen. Dies kann auf verschiedenste Weise passieren – ob ein wohltuendes Bad, eine entspannende Gesichtsbehandlung, eine meditative YogaStunde oder einfach nur ein spannendes Buch auf der Couch lesen.
Auf den folgenden Seiten erfahren Sie mehr rund um die Themen Familienleben, Ernährung sowie Haut- und Rückengesundheit und lassen Sie sich von spannenden Interviews und interessanten Artikeln inspirieren.
Wir wünschen Ihnen viel Spaß beim Lesen!
Campaign Manager: Antonia Blunck, Merle Tölke, Merve Bayram, Pajam Klünder
Geschäftsführung: Nicole Bitkin
Head of Content & Production: Aileen Reese
Lektorat: Famke Lohmann, Nadine Wagner
AUSGABE #119
Alles für die Gesundheit
Text: Katja Deutsch, Jenny Brania, Christiane Meyer-Spittler, Silja Ahlemeyer, Jacob Bratsch, Kristen Schwieger, Julia Butz, Armin Fuhrer, Kerstin Kloss, Chan Sidki-Lundius, Theo Hoffmann, Nadine Wagner

Coverfoto: shutterstock/Ground Picture, Anna-Lena Kreutz, Pressefoto
Distribution&Druck: Die Welt, 2023, Axel Springer SE


Rückengesundheit
52. Bewegung
56. Ergonomie
57. Exoskelette
58. Ingo Froböse
AUCH IN DIESER AUSGABE:
CONTENTWAY.DE
Vorsorge rettet Leben
Bei der Gesundheitsvorsorge sollte man such Facharztpraxen konsultieren.
FOLGE UNS!
Bleiben Sie mit unseren neuesten Kampagnen auf dem Laufenden auf unseren sozialen Kanälen.
EXKLUSIVE ONLINE INHALTE
Sehen Sie sich exklusive Filme und Videos auf unserer Website an.
Seite 39
Dr. med. Yael Adler, Dermatologin, Ernährungsmedizinerin und Autorin

Auf unserer Website finden Sie viele weitere interessante Artikel und Interviews.
Seite 58
Ingo Froböse, Universitätsprofessor an der Deutschen Sporthochschule Köln

Contentway Wir erstellen Online- und Printkampagnen mit wertvollen und interessanten Inhalten, die an relevante Zielgruppen verteilt werden. Unser Partner Content und Native Advertising stellt Ihre Geschichte in den Vordergrund.
Die Inhalte des „Partner Content“ in dieser Kampagne wurden in Zusammenarbeit mit unseren Kunden erstellt und sind Anzeigen. Für die Lesbarkeit verwenden wir das generische Maskulinum. Die Formulierungen sprechen alle Geschlechter gleichberechtigt an.
DIE LEITMESSE | THE LEADING TR ADE FAIR 31.3. – 2.4.2023
JetztTicketsichern: beauty.de/tickets
Herausgegeben von:
Contentway GmbH
Rödingsmarkt 20
DE-20459 Hamburg
Tel.: +49 40 87 407 400
E-Mail: info@contentway.com
Web: www.contentway.de
ANZEIGE
FAMILIENGESUNDHEIT Eine unabhängige Kampagne von Contentway 2
bin2301_01045_Anzeige Image 248 x 121_DE.indd 1 13.02.23 17:42
Der führende Branchentreff für Kosmetik, Nail, Fuß, Wellness & Spa.
Frank Schübel, Vorsitzender des Deutschen Teeverbandes
ALLES FÜR DIE GESUNDHEIT
Seite 30
ut verpackt steht das Bett des schwedischen Möbelherstellers in der kleinen Gießener Dachgeschosswohnung von Azai. Gleich nach der Klausurenphase an der Uni wollte er es aufbauen. Seine Mama sollte es bequem haben. Jetzt, nach acht langen Jahren, wäre endlich ein Besuch und ein Wiedersehen möglich gewesen. Der Bürgerkrieg in Syrien löschte fast Azais gesamte Familie aus. 2015 kam er als 19-jähriger allein in Deutschland an, lernte die Sprache und begann zu studieren. Zuhause in Syrien lebte nur noch seine Mutter. Bis sie dem Beben zum Opfer fiel. Unter Tränen fragt sich Azai nun:
Azai hofft, dass dieser Krieg endlich aufhört und dass jetzt Hilfe bei seinem Volk ankommt. Das Bett wird er zurückgeben. Gerade in Syrien trifft es die, die schon seit Jahren alles verloren haben. Es sind überwiegend Frauen und Kinder, die in den Flüchtlingscamps leben. Der Ausbruch einer Cholera-Epidemie dort verschärft die Lage. Menschen in Not erhalten in Syrien keinerlei staatliche Hilfe. Aber auch in der Türkei hat das Beben vielen ihr gesamtes Hab und Gut genommen. Ihnen blieb nur das nackte Leben.

JETZT HOFFNUNG SPENDEN!


INFOS Info@GAiN-Germany.org Tel. 0641-975 18-50 GAiN-Germany.org SPENDENKONTO Volksbank Mittelhessen IBAN DE88 5139 0000 0051 5551 55 „23ERDBEBEN““
„Wie oft kann man alles verlieren, bevor man endgültig am Ende ist?“
Bewusstsein für Frauenund Familiengesundheit







einleitung
„Gesundheit ist ein Zustand des vollständigen körperlichen, geistigen und sozialen Wohlergehens und nicht nur das Fehlen von Krankheit.“
So lautet die Definition von Gesundheit in der Verfassung der WHO aus dem Jahre 1946.
Foto: Presse

Als Geburtshelfer und Gynäkologe weiß ich, dass Frauengesundheit Voraussetzung ist für die Gesundheit der gesamten Familie, denn trotz aller Veränderungen der gesellschaftlichen Strukturen tragen Frauen weiterhin die Hauptlast der Familienarbeit. Deshalb ist dieses Heft nicht nur für Frauen interessant.

Schwangerschaft z. B. ist zwar biologisch ein „normaler“ Zustand der Frau, aber dennoch eine immense körperliche und psychische Belastung für die Schwangeren. Nicht nur für soziale Aktivitäten und die Berufstätigkeit, auch in anderen Bereichen wie Ernährung, Hygiene, Sport und Partnerschaft sind die „anderen Umstände“ eine Herausforderung. Das Glück einer erfolgreichen Schwangerschaft ist aber nicht für jedes Paar problemlos zu erreichen. Unerfüllter Kinderwunsch ist sowohl für die Betroffenen, als auch für die Gesellschaft eine Last, die nicht nur medizinischer und psychosozialer Behandlung, sondern auch finanzieller Unterstützung der Gesellschaft bedarf und diese auch verdient. Das ist ein wichtiger und leider etwas vernachlässigter Aspekt der reproduktiven Selbstbestimmung, die an anderer Stelle vehement eingefordert wird. Mit Erfüllung des Kinderwunsches kommen auf das Paar weitere Aufgaben zu, wie Stillen, Eltern-Kind-Bindung oder eine gesunde Kinderernährung. Aber auch die Vereinbarkeit von Elternsein und Beruf.
In anderen Aspekten der Frauengesundheit zeigt sich, wie viel politischer Wille erreichen kann, z. B. bei der Behandlung von Brustkrebs. Die Neuorganisation von Brustkrebsfrüherkennung und -behandlung wurde in den letzten 20 Jahren von den onkologischen Fachgesellschaften mit Nachdruck gefordert und initiiert. Ohne politische Entschlossenheit wäre es nicht gelungen, dies umzusetzen. Das Ergebnis: Jedes Jahr wird die Heilungsrate dieser Erkrankung in Deutschland um einen Prozentpunkt besser. Impfung, Früherkennung und bessere Organisation der Therapie in interdisziplinären Zentren sind ferner auch beim Gebärmutterhalskrebs wichtig, ein weiteres in diesem Heft behandeltes Thema.

Diese Aufmerksamkeit verdienen auch andere Frauenkrankheiten, die noch nicht so sehr im Bewusstsein der Allgemeinheit angekommen sind. Dazu gehört zum Beispiel das PCO-Syndrom, das Syndrom der polyzystischen Ovarien. Als komplexe Stoffwechselstörung verursacht es vielfältige Beschwerden und beeinträchtigt die Lebensqualität der betroffenen Frauen. Nicht mindere Bedeutung hat ein anderes Krankheitsbild, die Endometriose. Dies betrifft sehr viele Frauen im geschlechtsreifen Alter und behindert nicht nur die Fähigkeit, schwanger zu werden, sondern kann auch komplexe Schmerzsyndrome auslösen. Letztere stören Sexualität und Partnerschaft, Berufsausübung und Lebensqualität und können sogar zur Depression führen. In der Vergangenheit häufig als Befindlichkeitsstörung abgetan, scheint nun langsam anerkannt zu werden, dass die Endometriose ein gesundheitspolitisches Problem von hoher Bedeutung ist. Der Bericht einer Betroffenen in diesem Heft schildert eindrücklich den Leidensweg.








Die Lektüre dieses Heftes lohnt also!
WOMEN-ON-FIRE.DE

























FAMILIENGESUNDHEIT Eine unabhängige Kampagne von Contentway 4
Prof. Dr. Anton J. Scharl, Past-Präsident der Deutschen Gesellschaft für Gynäkologie und Geburtshilfe (DGGG)
„Trotz aller Veränderungen der gesellschaftlichen Strukturen tragen Frauen weiterhin die Hauptlast der Familienarbeit.“
Rabatt HIER BESTELLEN UND RABATT SICHERN ANZEIGE
JetztRabattKennenlernsichern JETZT NEU FÜR FRAUEN IN DER LEBENSMITTE
App-Hilfe fürs „Chamäleon der Gynäkologie“

Dr. med. Nadine Rohloff über den Nutzen multimodaler Schmerztherapie bei Endometriose und die große Bedeutung des Selbstmanagements.

Eine von zehn Frauen in Deutschland leidet an Endometriose –nicht selten, ohne es zu wissen. Bei dieser gynäkologischen Erkrankung wachsen gebärmutterschleimhautähnliche Zellen an Stellen, wo sie nicht hingehören. Zum Beispiel an den Eierstöcken, Beckenwänden, im Darm oder gar in der Lunge. Solche Endometrioseherde können zu unterschiedlich starken Beschwerden führen. Da die Palette unterschiedlichster Symptome sehr vielfältig ist, vergehen bis zur Diagnose oft viele Jahre. Viele Frauen ordnen die Schmerzen als normale Begleiterscheinungen ihres Zyklus ein, obwohl die Beschwerden weitaus stärker sind. Nicht selten wird die Erkrankung erst bei unerfülltem Kinderwunsch diagnostiziert. Dabei existieren neben der operativen und hormonellen Therapie auch symptomlindernde Möglichkeiten wie Ernährung, Physiotherapie oder Stressreduktion. Sämtliche Behandlungsmöglichkeiten ermöglichen
Foto:Presse
zwar keine vollständige Heilung, wohl aber eine Verbesserung der Lebensqualität und Linderung der Symptome, teilweise bis hin zu Schmerzfreiheit.
Frau Dr. Rohloff, warum haben Sie eine App für Endometriose entwickelt?
Weil ich im Rahmen meiner Tätigkeit am Endometriosezentrum der Universitätsklinik Münster gesehen habe, dass sie notwendig ist. Denn das Behandlungsangebot dieser chronischen Erkrankung ist begrenzt. Neben Operation und Hormontherapie müsste man noch mehr tun, allerdings ist für die vielen verschiedenen Aspekte der multimodale Schmerztherapie im Klinikalltag nicht genügend Zeit und die Wartelisten für die wenigen Therapieplätze sind lang.
Welchen Nutzen bietet die App?
Die Anwendung bietet eine kontinuierliche Unterstützung der Betroffenen durch Selbstmanagement. Betroffene können mit der App quasi zuhause ihr eigenes Reha-Programm in den Alltag integrieren. In einer wissenschaft lichen Studie konnten wir nachweisen, dass die
Nutzung der App zu einer Steigerung der Lebensqualität führen kann.
Welche Funktionen beinhaltet sie?
Das Herzstück der App ist ein Symptomtagebuch, in dem die Nutzerinnen ihre Beschwerden als auch Behandlungen dokumentieren können. Dies ermöglicht ihnen herauszufi nden, was langfristig hilft . Zudem sind viele Übungen und Lernkurse enthalten, durch welche sich Betroffene interaktiv einen besseren Umgang mit ihrer Erkrankung aneignen können. Die Inhalte decken zahlreiche Bereiche der multimodalen Schmerztherapie ab, unter anderem Physiotherapie, Ernährungsberatung, Psychologie sowie Stressreduktion und sozialrechtliche Aspekte.
Warum ist Selbstmanagement bei diesem Krankheitsbild so wichtig?
Die Krankheit ist sehr komplex und deren Ursache nach wie vor nicht geklärt. Es gibt bis dato also keine Heilung, sondern lediglich Behandlungsoptionen zur Linderung von Beschwerden. Das heißt, die Betroffenen müssen ihr Leben so gestalten, dass die chronische Erkrankung ihren Lebensalltags möglichst wenig einschränkt. Hilfreiche Aktionen sollten möglichst einfach zu erreichen sein und in den Alltag integriert werden, um nachhaltig wirken zu können. Das ermöglicht den betroffenen Frauen ein Stück Kontrolle und Selbstwirksamkeit und gibt ihnen das Gefühl, der Krankheit nicht hilflos ausgeliefert zu sein.
Übernimmt die Krankenkasse die Kosten für die Endo-App?
Ja, alle gesetzlichen Krankenkassen übernehmen die Kosten. Um die App
bei seiner Krankenkasse zu beantragen, muss dort entweder eine gesicherte Diagnose für Endometriose oder ein ärztliches Rezept für die Endo-App eingereicht werden. Die Krankenkasse verschickt daraufh in einen Freischaltcode. Das Rezept kann vom Hausarzt oder der behandelnden Gynäkologin oder Psychotherapeutin verschrieben werden.
„Das Herzstück der App ist ein Symptomtagebuch, in dem die Nutzerinnen ihre Beschwerden als auch Behandlungen dokumentieren können. Dies ermöglicht ihnen herauszu�nden, was langfristig hilft.“
Was sind ihrer Erfahrung nach die aussichtsreichsten Therapien?
Das lässt sich nicht pauschal sagen. Jede Behandlungsoption hat ihre Vor- und Nachteile. Wichtig ist, dass die Therapie individuell auf die Symptome und Lebensumstände der Patientinnen zugeschnitten ist und ganzheitlich greift . Der Gang in ein Endometriezentrum ist sicherlich ein guter Startpunkt. In der App und auf unserer Webseite gibt es zudem eine Liste mit spezialisierten Ärzten.
Noch einen abschließenden Tipp für Betroff ene?
Ja, bitte nicht entmutigen lassen! Linderung ist möglich und auch die Endometrioseforschung schreitet immer weiter voran.
Endo Health
Die digitale Gesundheitsanwendung Endo-App unterstützt Endometriose-Betroff ene durch evidenzbasierte und leitlinienkonforme Inhalte, Methoden und Übungen der multimodalen Schmerztherapie und Endometriose-Therapie. Neben wissenschaftlich fundierten Informationen zu Therapieoptionen und chronischen Schmerzen erhalten die Endo-App-Nutzerinnen ein detailliertes Symptomtagebuch für eine individuelle Dokumentation. diga.endometriose.app


5 FAMILIENGESUNDHEIT Eine unabhängige Kampagne von Contentway
ENDO HEALTH – PARTNER CONTENT «
«
„Neben der operativen und hormonellen Therapie existieren auch symptomlindernde Möglichkeiten wie Ernährung, Physiotherapie oder Stressreduktion.“
Dr. med. Nadine Rohloff, Gründerin der Endo-App
Gemüse statt Sushi
schwangerschaft Gesunde Ernährung in der Schwangerschaft tut Mutter und Kind gut. Besser beginnt man bereits vor der Schwangerschaft damit.
Text: Katja Deutsch
Foto: Amina Filkins/pexels
Man kann es gar nicht oft genug wiederholen: Eine gesunde und ausgewogene Ernährung ist nicht nur während der Schwangerschaft wichtig, sondern auch schon davor. Denn normalgewichtige Frauen werden viel leichter schwanger als solche mit starkem Über- oder Untergewicht. Wenn man den Wunsch nach einem Baby verspürt und sich eine Schwangerschaft vorstellen kann, kommt der gesunden Ernährung eine noch wichtigere Rolle zu. Süßigkeiten werden jetzt am besten reduziert, morgens eine Folsäuretablette, Jod und Eisen eingenommen. Da es öfter vorkommt, dass eine Schwangerschaft anfangs unerkannt bleibt, verzichtet man bei nicht vorhandener Verhütung auf Alkohol.
Wenig Zucker, dafür viel Gemüse, Obst, Vollkornprodukte, Hülsenfrüchte und auch Milchprodukte sollte die Schwangere zu sich nehmen. Die zusätzlichen Vitamine und Mineralstoffe sind wichtig für Mutter und Kind, auch ein bis zweimal wöchentlich Fisch
Wenig Zucker, dafür viel Gemüse, Obst, Vollkornprodukte, Hülsenfrüchte und auch Milchprodukte sollte die Schwangere zu sich nehmen.
mit viel Liebe gemacht H keine

sowie fettarmes Fleisch werden empfohlen. Wichtig ist dabei die Qualität der Ernährung, nicht die Quantität. Wer das doppelte isst, erhöht die Gefahr von Schwangerschaftsdiabetes bei sich und Übergewicht und Diabetes bei seinem Kind. Eine ovo-lacto-vegetarische Ernährung ist möglich, von einer rein veganen wird dagegen abgeraten, denn sie schadet der Entwicklung des kindlichen Nervensystems. Veganer sollten neben anderen Zusatzmitteln besonders auf eine ausreichende Versorgung mit Vitamin B 12 achten.

„Komplett gemieden sollten in der Schwangerschaft rohe Lebensmittel vom Tier, insbesondere Rohmilch und ihre Produkte, wie Rohmilchkäse“, sagt
Markus Haist, zweiter Vorsitzender des Berufsverbands der Frauenärzte e. V. (BVF). „Ebenso sollte kein rohes Fleisch und kein roher Fisch verzehrt werden.
Hintergrund dieser Sicherheitsmaßnahmen ist, dass diese Lebensmittel manchmal Erreger enthalten, welche die Infektionen Toxoplasmose oder Listeriose auslösen können.“ Also leider weder Sushi noch französischer Rohmilchkäse.
Die werdende Mutter kann ihren gewohnten Sport weiterhin (moderat!) betreiben, dabei versteht es sich jedoch von selbst, dass riskante Sportarten wie Reiten, Mountainbiken und Skifahren und alles, was Sprünge beinhaltet, vermieden werden. Besser tun jetzt Spaziergänge an der frischen Luft, denn sie sorgen für
eine gute Sauerstoffversorgung von Mutter und ihrem wachsenden Kind.
Auch wenn nach drei Jahren Pandemie mit Maskentragen die meisten Menschen aufatmen, diesen Zwang jetzt los zu sein – für Schwangere ist ein festsitzender Mund-Nasenschutz in der Öffentlichkeit zumindest in der kalten Jahrezeit nicht das dümmste. Da man tunlichst auf die Einnahme von Antibiotika und Schmerzmitteln verzichten sollte, kann eine Maske gut vor Grippe und Bronchitis schützen. Hat es die baldige Mutter dennoch erwischt, sollte sie mit täglicher Inhalation, Ruhe und Wärme versuchen, den Infekt loszuwerden. Thymianaufgüsse helfen gut gegen Reizhusten, Salbei und Honig beruhigen den Hals.
für Mama & Baby
Du erhältst 10 % RABATT mit demRabattcode*:exklusiven WELT23
Markenprodukte
















geschlechtsneutrale
Bald Mama?
Schwangerschaft ist die schönste Form der Vorfreude
Freu Dich auf 24 wunderschöne zusätzliche Momente in Deiner Schwangerschaft!
Die 24 liebevoll gestalteten Boxen in unserem Schwangerschaftskalender beinhalten sorgfältig ausgewählte Geschenke für Dein Baby und Dich und läuten den Countdown bis zur Geburt ein.

Das absolute Highlight ist unsere Premium-Edition –individuell, noch hochwertiger und viel Handarbeit.










* Einlösbar in unserem Webshop – www.vortageins.de www.vortageins.de

FAMILIENGESUNDHEIT Eine unabhängige Kampagne von Contentway 6
Die Ernährung in der Schwangerschaft hat Auswirkungen auf die Gesundheit und Entwicklung des Babys.
Was ist wichtig, wenn Kinder krank sind





















kindergesundheit

Wenn die eigenen Kinder krank sind, wünschen sich Eltern nichts dringender als eine schnelle Genesung. Doch was können Eltern konkret tun?

Text: Jenny Brania










Foto: Andrea Piacquadio/pexels
Eltern kennen die Situation: Das Kind fühlt sich unwohl oder weint vermehrt, hat keinen Appetit und verhält sich anders als sonst. Infekte jeglicher Art sind keine Seltenheit, da sich das Immunsystem der Kleinen erst entwickeln muss. Vor allem bei Säuglingen und Kleinkindern kann es den Eltern schwerfallen, die Anzeichen klar zu deuten und entsprechend zu reagieren. Kinderärztliche Vorsorgeuntersuchungen und der Austausch mit anderen oder den eigenen Eltern können dabei hilfreiche Anhaltspunkte sein, um sich Rat einzuholen und sicherer im Umgang zu werden. Eine ausgewogene und nährstoff reiche Ernährung ist aber ebenso wichtig, um eine grundlegende Basis für die Gesundheit des Kindes zu schaffen und die Entwicklung des Immunsystems optimal zu fördern. Nichtsdestotrotz sind Infekte nicht unvermeidbar und da stellen sich Eltern berechtigterweise die Frage, wie sie für ihren Sprössling da sein und was sie konkret tun können.
















































































































Was zum einen hilft, ist sich daran zu erinnern, was einem selbst als Kind gutgetan hat, wenn man mal wieder mit einem aus dem Kindergarten mitgebrachten

Aufmerksamkeit und Geborgenheit sind besonders förderlich für die Genesung.




Infekt zu Hause lag. Denn oftmals waren es nicht nur Fiebersaft und Hühnersuppe, sondern vermutlich auch die Nähe der eigenen Eltern. Und so können Eltern sich ebenso daran orientieren, wenn ihre eigenen Schützlinge am Kränkeln sind. Denn mit einer Extraportion Fürsorge können Eltern den Genesungsprozess beschleunigen und dazu beitragen, dass die Krankheitstage für die Kleinen weniger negativ behaftet und angstbesetzt sind.
Neben genügend elterlicher Geborgenheit, Zuwendung und Aufmerksamkeit sind zum anderen ausreichendes Trinken sowie nährstoff reiche Kost wichtig, um den Körper bestmöglich bei der Genesung zu unterstützen. Ebenso sollten Eltern auf Stoßlüften setzen, um das bettlägerige Kind mit Frischluft zu versorgen. Anders als vielleicht die meisten Erwachsenen können Kinder allerdings trotz Fieber energiegeladen sein und
0 en treuer n g ei


durch die Wohnung toben, weswegen Ruhepausen enorm wichtig sind. Eltern können hierfür entspannende Aktivitäten wie Kuscheln, Geschichten vorlesen oder progressive Muskelentspannung einbauen, um den kindlichen Körper und Geist zu beruhigen und zu schonen. Ergänzend dazu empfiehlt sich ein Repertoire an leichten Aktivitäten, die das Kind beschäftigen, aber nicht allzu kraftraubend sind. Den ganzen Tag zu Hause zu sein und nicht den alltäglichen Erkundungen der großen weiten Welt nachgehen zu können, kann sehr ernüchternd und belastend für die Kleinen sein. Dafür eignen sich Beschäftigungen wie Malen, Hörbücher hören oder auch festgelegte Zeiten zum Schauen der Lieblingsserie. Schlussendlich sollten Eltern das Kind nicht zu voreilig wieder in den Kindergarten oder die Schule schicken und lieber ein oder zwei Tage mehr für die Genesung einplanen.

















fakten


Das Immunsystem von Kleinkindern ist besonders anfällig für Erreger, da sich die Grundimmunität erst mit der Zeit entwickelt. Daher sind bis zu zehn fi eberhafte Infekte pro Jahr nicht ungewöhnlich. Doch der häufi ge Kontakt mit Krankheitserregern hilft beim Stärken der natürlichen Abwehrreaktion.
Darüber hinaus dürfen sich Eltern diese Geduld selbst entgegenbringen, denn Krankentage können äußerst fordernd und kräftezehrend sein. Daher sollte nicht gezögert werden, sich ärztlichen Rat einzuholen oder Familie und Freunde um Unterstützung zu bitten. Denn so wie das Kind mehr Zuwendung braucht, braucht es ebenfalls Ruhe, die die Eltern auf ihren Schützling ausstrahlen können. ANZEIGE
Jetzt mitmachen und 1 VON 10 FELIX-PAKETEN gewinnen*.
7 FAMILIENGESUNDHEIT Eine unabhängige Kampagne von Contentway
KINDER EM-EUKAL® PRODUKTPAKET
RZ01_KEE-25326-001_AZ_KEE_DIE WELT_248x121mm_0323.indd 1 06.03.23 16:27
FELIX KUSCHELKISSEN
SCANNEN, MITMACHEN UND
GEWINNEN!
*QR-Code scannen oder auf kinder.em-eukal.de vorbeischauen und gewinnen. Zeitraum: 15.03.–15.06.2023.
Mit Sicherheit groß werden
sicheres zuhause
Die Tasse Kaffee kann für Krabbelkinder schnell lebensgefährlich werden. Worauf Eltern sonst noch achten sollten.
Die Freude übers Baby ist riesig, gleichzeitig entstehen Sorgen über die vielen möglichen Gefahren. Worauf sollte geachtet werden, welche Gefahren drohen?
Steckdosen sind in der Tat lebensgefährlich – aber in erster Linie dann, wenn die Kabel in Bodennähe ungesichert aus der Wand ragen. Sind sie mit den üblichen Plastikumkleidungen versehen, ist es dagegen sehr unwahrscheinlich, dass sich ein Krabbelkind daran verletzen kann, denn es müsste mit zwei Metallstäben gleichzeitig in die Löcher stechen. Ein
Eine große Gefahr im Hause liegt in etwas vermeintlich Banalem: Der Tasse Kaffee.
drei- oder vierjähriges Kind ist dazu jedoch durchaus in der Lage, deshalb: Kindersicherungen anbringen!
Eine große Gefahr im Hause liegt in etwas vermeintlich Banalem: Der Tasse Kaffee. Wenn ein Kind im Alter von etwa neun bis etwa 18 Monaten zu laufen beginnt, hält es sich an allem fest, was Stabilität verspricht, wie beispielsweise Tische, Küchenarbeitsplatten und Sideboards – also alles, wo man schnell mal seine Tasse Kaffee oder Tee abstellt. Erwischt das Kind beim Festhalten die Tasse, kann es sich das kochend heiße Getränk auf Kopf und Bauch schütten und schwere Verbrühungen erleiden. Ist ein Drittel der Hautoberfläche verbrüht, wird das Überleben zum Glücksfall. Es ist deshalb lebenswichtig, seine heißen Getränke für Kinderhände unerreichbar abzustellen, und auch seine Gäste dazu zu sensibilisieren. Auch der Herd sollte gesichert werden.
Bei Küchengeräten wie Rührmixer, Pürierstab und Ähnlichem sollte man darauf achten, das Kabel nach Benutzung keinesfalls über die Kante der Arbeitsplatte hängen zu lassen. Für ein Krabbelkind ist es zu verführerisch, danach zu greifen und zu ziehen. Fällt der
Mixer auf den Kopf, droht eine schlimme Kopfverletzung.
Kleinkinder erfahren ihre Umgebung mit Vorliebe dadurch, dass sie Dinge in den Mund nehmen. Geschmäcker sind für ein Krabbel- und Kleinkind neu und aufregend, es kann noch nicht schmecken, ob etwas giftig ist und probiert deshalb auch gerne Waschpulver und ähnliches. Verätzungen der Speiseröhre mit lebenslangen Folgen können das Resultat sein. Sämtliche Wasch- Putzund Reinigungsmittel müssen deswegen kindersicher verstaut werden, am besten oben im Regal.
Auch an Dingen, die so schön knistern, wie eine Packung Taschentücher, lutschen und nuckeln Kleinkinder gerne herum. Es gibt nicht wenige Fälle, bei denen sich hierbei der Klebeverschluss gelöst und an der Luftröhre festgeklebt hat. Das kann unentdeckt zum langsamen Erstickungstod führen.
Mittlerweile ist ausreichend bekannt, dass sich Säuglinge und kleine Kinder in einen Babyschlafsack kuscheln sollten anstatt in Decken, um einen nächtlichen Erstickungstod zu vermeiden. Auch dass man seine Fenster abschließt und niemals
Mittlerweile ist ausreichend bekannt, dass sich Säuglinge und kleine Kinder in einen Babyschlafsack kuscheln sollten anstatt in Decken, um einen nächtlichen Erstickungstod zu vermeiden.
lüftet, wenn sich ein Kleinkind im Raum befindet, sollte klar sein. Fenstergriffe lassen sich problemlos und mit wenig finanziellen Aufwand durch abschließbare Griffe ersetzen. Treppen im Haus sollten durch Treppengitter geschützt werden. Auf der Straße und an Bahnhöfen müssen Kleinkinder in den Kinderwagen oder fest an die Hand. Jede Art von Schütteln ist absolut zu vermeiden, denn sie kann zum Tode führen, auch sofort nach der Geburt. Sollten die Wehen nämlich weit vor dem errechneten Geburtstermin einsetzen, so ist es existentiell wichtig, dass das Frühgeborene ohne jede Erschütterung transportiert wird, um sein Gehirn nicht zu schädigen.

FAMILIENGESUNDHEIT Eine unabhängige Kampagne von Contentway 8
Text: Katja Deutsch
Foto: Brina Blum/unsplash
Die meisten Kinder sind geborene Kletterkünstler. Regale und Schränke sollten deshalb am besten fest an der dahinterliegenden Wand befestigt werden.
Schnell und einfach Hilfe finden, wenn die Eltern nicht guttun
Ob Narzissmus oder Depressionen: Eltern mit psychischen Erkrankungen oder problematischen Verhaltensmustern können das auslösen, was man eine dysfunktionale Familiensituation nennt. Darunter leiden besonders die Kinder. Da kann es vorkommen, dass der Mutter ihr Friseurtermin wichtiger ist als der Auftritt des Kindes, dass der Vater aus dem geringsten Anlass Wutanfälle bekommt oder auch, dass man von den Eltern ständig nur hört, was man alles nicht kann und warum man einfach niemals gut genug ist. Die betroffenen Kinder und Jugendlichen leiden oft unerkannt, dabei brauchen sie schnell und unkompliziert professionelle Hilfe.
Mit einem umfassenden Informations- und Unterstützungsangebot hilft die Münchner GOLDKIND-Stift ung Kindern aus dysfunktionalen Beziehungen. Die Website www.goldkind-stift ung.de ermöglicht als digitale Plattform im Mental-Health-Bereich betroffenen Kindern und Jugendlichen kostenfrei und niederschwellig Kontakt zu einem erfahrenen Team von Psychologinnen – per Live-Chat, E-Mail und Videosprechstunde – und den Austausch mit anderen im Forum.
Foto:Presse
Jan Fischer, Gründer
Denn diese Kinder und Familien werden von den klassischen Hilfen wie dem Jugendamt oft gar nicht gesehen, so Gründer Jan Fischer. „Für diese Kinder sind wir mit GOLDKIND da, helfen unmittelbar und lindern ihr Leid. Dazu gehen wir völlig neue Wege mit zeitgemäßen, digitalen Angeboten, die direkt erreichbar sind.“ Bis zu vier Millionen Kinder und Jugendliche wachsen hierzulande mit einem psychisch kranken Elternteil auf. Das bedeutet meistens, dass sie selbst nicht die nötige Unterstützung und Aufmerksamkeit erfahren – und dass sie teilweise sogar in die Elternrolle gezwungen werden und daheim die Versorgung schultern. Später haben Kinder psychisch kranker Eltern ein drei- bis vierfach

GOLDKIND – Stiftung für Kinder aus dysfunktionalen Familien gGmbH

Foto:Presse
Carolina Pougin, Geschäftsführerin

erhöhtes Risiko, selbst psychisch krank zu werden. Verheerende Muster dysfunktionaler Familien werden nicht selten ins eigene Erwachsenenleben übernommen und so immer weitergegeben.
„Die Gründe für eine Schieflage in der Familie können vielfältig sein: Schon vermeintlich kleinere Verhaltensauff älligkeiten, wie sie stark narzisstische Persönlichkeiten aufweisen, aber natürlich auch alle anderen psychischen Störungen haben massive Auswirkungen auf die Kleinsten“, erklärt Geschäftsführerin Carolina Pougin.
Die vor eineinhalb Jahren gegründete Stift ung wird auf zwei Ebenen in Anspruch genommen: Zum einen direkt
Goldkind fördert sowohl Forschung als auch direkte Hilfen seitens Dritter wie Therapien, Coachings für Lehrkräfte und Kita-Personal, Empowerment-Camps für Kinder (und Eltern). www.goldkind-stiftung.de

von den betroffenen Kindern und Jugendlichen, die konkrete Hilfe erhalten und kindgerechte Tipps zur Selbsthilfe bekommen, beispielsweise auf dem GOLDKIND-Youtube-Kanal mit Erklärvideos von Casy Dinsing. Darin zeigt die psychologische Beraterin, ab wann das Verhalten der eigenen Eltern ungesund wird und wie man als Kind damit am besten umgehen kann. Die (Hör-)Bücher der Kinderbuchautorin Anja Janotta mit dem Maskottchen GOLDIE können helfen, die eigene Lage besser wahrzunehmen und zu verstehen. Zum anderen will die GOLDKIND-Stift ung erwachsene Bezugspersonen sensibilisieren und befähigen, mit der Situation besser umzugehen.
„Egal ob Nachbarin, Opa, Kinderpflegerin oder Freund der Familie: Wir versuchen, diejenigen aufzuklären, die die betroffenen Kinder gut kennen und als Erste bemerken, wenn etwas nicht stimmt“, sagt Carolina Pougin. „Sie sollten in die Lage kommen, den Punkt zu erkennen, an dem die Probleme so existenziell sind, dass Hilfe von außen nötig ist.“ Dieses Ziel verfolgt GOLDKIND mit seinem Info-Angebot. Und mit kostenlosen Fortbildungsangeboten für Fachkräfte und Interessierte.
Die smarte Evolution des Babyphones
Smarte Helfer steigern Babys Wohlbefinden und sorgen auch bei Eltern für ein Gefühl der Sicherheit und mehr Entspannung im Alltag.
Es ist nicht immer einfach, richtig einzuschätzen, was ein Baby gerade braucht. So finden fürsorgliche Eltern oftmals keine Ruhe, da sie die Angst plagt, in der Nacht das Weinen zu überhören oder befürchten, ihrem Schützling könnte während des Schlafes etwas passieren. Eine neue Generation genialer High Tech Helfer überwacht in Form tragbarer Accessoires oder als stationäres Gerät den Schlaf und die Körperfunktionen des Babys mittels modernster Sensortechnik. Die neuen technischen Hilfsmittel bieten großen Komfort und ein enormes Gefühl der Sicherheit. Erste Errungenschaften für eine sichere Schlafüberwachung wie die Sensormatte unter der Matratze des Bettchens oder herkömmliche Babyphones mit begrenzten Akkuleistungen und Reichweiten, sehen daneben ganz schön oldschool aus.
Die Smart Sock ist zahlreich ausgezeichnet und wird von Hebammen empfohlen. Als Owlet Monitor Duo, der idealen Kombination der intelligenten Smart Sock 3 und
Owlet Baby Care



Kamera können Eltern stets und von überall aus im Blick zu behalten, ob es ihrem Baby gut geht. Die durchdachte Weiterentwicklung eines Babyphones besteht aus einer HD Nachtsichtkamera mit Weitwinkel und der Smart Sock – einem weichen Stoffband, welches um den Fuß des Babys gewickelt wird. Das Duo verbindet die Smart Sock 3 nahtlos mit der Cam 2 – ein Rundumsorglospaket für lückenlose Informationen zum Wohlbefinden des Babys, während es schläft.

Über die sogenannte Pulsoximetrie-Technologie werden mithilfe eines Infrarotsensors
Die Smart Sock benutz die Pulsoximetrie um die Herzfrequenz und die Sauerstoff werte Ihres Babys zu messen. Diese Informationen werden dann an Ihre Basistation übermittelt, welche diese dann in Echtzeit an Ihr Smarphone sendet. www.owletcare.de

am digitalen Fußsöckchen Körpertemperatur, Herzfrequenz, Atem und Sauerstoffsättigung beständig erfasst, aufgezeichnet und an die Basisstation gesendet. Die Smart Sock schränkt den Schlaf oder die Bewegungsfreiheit des Babys nicht ein und die verschiedenen Größen in hübschen Farben von Rainbow, Himmelblau bis Salbeigrün sorgen dafür, dass das stylische Wearable auch wachstumsbegleitend eingesetzt werden kann. Bei zu langer Bewegungspause oder sollte sich einer der Werte nicht im Normalbereich befinden, erhalten die Eltern eine Push-Nachricht auf das Smartphone. Auch die Basisstation reagiert und sendet akustische und visuelle Signale. Wer also sein Handy nicht gern am Nachttisch liegen hat, kann die Basisstation in der Nähe platzieren und dadurch im Ernstfall geweckt werden.
Alle Live-Messwerte werden in der Owlet Care App jederzeit und überall angezeigt und sind 30 Tage lang als Schlaftrend aufrufbar. Die gesammelten Daten der geschlafenen Stunden, Wachphasen und Alarme helfen dabei, die allgemeine Schlafqualität zu bewerten und eine erholsamere Schlafroutine zu entwickeln. Die Live-Videoclips in HD-Qualität sorgen als Stream über die App auch bei Dunkelheit für den besten Überblick, fast so, als wäre man selbst im Raum. Durch die Akkulaufzeit von bis zu 16 Stunden ist es möglich, die Überwachung über einen langen Zeitraum ununterbrochen verfolgen zu können, die kürzeren Wachphasen können für eine schnelle Aufladung genutzt. So sind bereits innerhalb von nur 20 Minuten wieder acht Akkustunden für die rundum erleichterte Fürsorge geladen.
9 FAMILIENGESUNDHEIT Eine unabhängige Kampagne von Contentway GOLDKIND – PARTNER CONTENT
OWLET – PARTNER CONTENT
Genießen Sie gelassen alle Entwicklungsschritte Ihres Kindes.
Das Owlet 2-in-1 Babyphone Duo erfasst die wichtigsten Parameter für das Wohlbefinden Ihres Babys.
Essen will gelernt sein
ernährung
Von der Muttermilch über die Beikost hin zur Familienkost: In den ersten zwölf Lebensmonaten benötigen Babys viele verschiedene Nährstoffe.
Text: Christiane Meyer-Spittler
Foto: Hui Sang/unsplash
Da das Verdauungssystem eines Neugeborenen noch nicht voll ausgereift ist, wird es mindestens die ersten fünf Lebensmonate ausschließlich flüssig ernährt. Auch wenn dafür die Muttermilch in ihrer Zusammensetzung unübertroffen bleibt, ist das sogenannte Flaschenkind mit Babynahrung aus dem Regal auch gut versorgt. Diese Pre-Milch-Produkte sind inzwischen alle mit langkettigen, mehrfach ungesättigten Fettsäuren versetzt, die die Entwicklung von Gehirn- und Nervenzellen und die Sehfähigkeit fördern. Auch Prä- und Probiotika für eine gesunde Verdauung sind inzwischen in vielen Babynahrungen zu finden. Beim Fläschchen-Stillen ist Nähe des Babys zu seiner Bezugsperson ebenfalls wichtig. Kann es sich beim Trinken ankuscheln und viel Wärme erfahren, fühlt es sich geborgen und verdaut in Ruhe seine Nahrung.
Ab dem fünften Monat kann der erste Brei eine der Milchmahlzeiten ersetzen. Dabei sollte noch mindestens das erste Lebensjahr auf Kuhmilch und deren Produkte verzichtet werden, um keine Unverträglichkeiten oder Allergien zu entwickeln.
Um den ersten Geburtstag herum kann die Gewöhnung an die sogenannte Beikost beginnen. Dabei kann gerne weiter gestillt werden, solange Mutter und Kind dies möchten. Denn die Muttermilch passt sich ganz von allein den veränderten
Ernährungsbedürfnissen des Babys an. Durch die natürliche Süße der Muttermilch fühlen sich Kinder beim Übergang zu fester Nahrung dem Süßen hingezogen. Wichtig ist jetzt, ihnen gesunde Alternativen, wie frisches Obst oder Gemüse anzubieten, um gar nicht erst in die Zuckerfalle zu geraten. Zudem braucht es Zeit und Geduld bis sich ein Kleinkind auf fremden Geschmack und unterschiedliche Beschaffenheiten einlässt. Es entwickelt ganz unterschiedliche Vorlieben und Abneigungen. Auch die Menge ist von Kind zu Kind und je nach Situation ganz verschieden. Daher gilt, dass das Essen immer in einer angenehmen Atmosphäre stattfindet, denn negative Emotionen schlagen bekanntlich auf den Magen.

Nicht zu früh auf den Speiseplan gehören kleine und harte Lebensmittel wie Nüsse oder Beeren, da hier Erstickungsgefahr droht. Auch blähende Lebensmittel wie Kohl, Zwiebeln oder Hülsenfrüchte sind zu meiden. Rohe tierische Lebensmittel, wie Wurst- und Fleischzubereitungen, Rohmilchkäse oder rohe Eier können durch Krankheitserreger zu lebensbedrohlichen Magen-Darm-Erkrankungen führen. Selbst unverarbeitetes Getreide oder reiner Bienenhonig können Keime eines bestimmten Bakteriums enthalten, die sich bei Kindern im Darm ansiedeln und ein gefährliches Gift bilden.
Nach dem Abstillen sollte ein Kind zusätzlich trinken: Am Ende der Übergangsphase zur Familienkost täglich bis zu 700 ml Flüssigkeit. Dazu eignen sich stille Wasser und ungesüßter Früchteoder Kräutertee. Wenn dann die Familienernährung ausgewogen und abwechslungsreich ist, deckt sie – in altersgerechten Mengen und Zubereitungen –den Bedarf des Kleinkindes.
Die Milch macht’s
stillen Muttermilch ist ideal an die Bedürfnisse des Babys angepasst: Sie ist praktisch immer verfügbar, optimal temperiert und hygienisch unbedenklich.

Text: Christiane Meyer-Spittler Foto: Wendy Wie/pexels
Mütter sind von Natur aus perfekt mit ihrer eigenen Milch ausgestattet. Diese ist dynamisch, denn im Laufe der Stillzeit passt sie sich dem verändernden Proteinbedarf des Kindes an. Ein Früh- und Neugeborenes braucht beispielsweise deutlich mehr Proteine als ein Baby im Alter von sechs Monaten. Zudem enthält Muttermilch Antikörper und immunwirksame Inhaltsstoffe. Es lassen sich sogar lebendige Zellen darin finden, die der Organentwicklung des Kindes und Reparaturleistungen zugutekommen. Ebenso dient sie der Allergieprophylaxe.
Wenn es mit dem Stillen nicht einfach so klappt, lohnt es sich über Milchpumpen nachzudenken. Ganz gleich ob Handmilchpumpe oder elektrische Milchpumpe, beide lösen den Milchstau, regen die Milchbildung an oder gönnen wunden Brustwarzen eine Pause. Sie sind vor allem in Apotheken erhältlich und können dort auch ausgeliehen werden.
Gleichzeitig gilt auch, nicht zu viele verschiedene Stillhilfen – zu früh, zu häufig
oder in Kombination – zu verwenden. Mütter sollten, insbesondere in den ersten sechs Wochen nach der Geburt, darauf verzichten, zwischen Flaschensauger, Schnuller, Beruhigungssauger, Stillhütchen und Brust hin und her zu wechseln. Bekommt ein Säugling in der ersten Zeit zu oft verschiedene Saughilfen angeboten, wird sein angeborener Saugreflex schnell „verwirrt“. Denn an der Flasche ist kaum Arbeit nötig. Dadurch verkümmert der natürliche Saugreflex, noch bevor das Baby das Trinken an der Brust richtig gelernt hat. Es kommt zu einer sogenannten Saugverwirrung. Diese lässt sich aber durch fachliche Anleitung leicht beheben und ist vorerst kein Grund, mit dem Stillen aufzuhören.
Muttermilch enthält Antikörper und immunwirksame Inhaltsstoffe.
In ganz besonderen Fällen – wenn Muttermilch überlebenswichtig wird – kann man diese von einer Frauenmilchbank erhalten. Eine Anlaufstelle hierfür ist die Frauenmilchbank-Initiative (FMBI), die sich dafür einsetzt, dass alle bedürftigen Frühgeborenen oder kranken Neugeborenen in Deutschland einen sicheren Zugang zu Muttermilch erhalten.
FAMILIENGESUNDHEIT Eine unabhängige Kampagne von Contentway 10
Ab dem fünften Monat kann der erste Brei eine der Milchmahlzeiten ersetzen.
Stillen stärkt die natürliche Bindung zwischen Mutter und Kind.
Babynahrung auf Knopfdruck zubereiten
Moderne Alltagshelfer helfen dabei, Zeit zu sparen und den Familienalltag stressfrei zu gestalten. Und damit mehr Zeit fürs Baby zu haben.
Die Geburt eines Babys stellt die ganze Welt auf den Kopf und der neue Alltag als Familie kann eine echte Herausforderung sein. Wie gut, dass es dank technischer Innovationen heute möglich ist, ein wenig zeitintensive Arbeit abgenommen zu bekommen. Vor allem wenn die Kleinsten Hunger haben und es plötzlich ganz schnell gehen muss. Denn ein Babyfläschchen richtig zuzubereiten, ist gar nicht so leicht. Die Milch darf weder zu kalt noch zu heiß sein, 37 Grad gelten als ideale Trinktemperatur. Wer kaum Erfahrung hat, ist dabei oftmals unsicher, die richtige Temperatur korrekt einzuschätzen. Viele Eltern
kennen den bewährten Trick, bei dem man einen kleinen Tropfen der erwärmten Milch auf den Handrücken gibt, um sicherzustellen, dass die Nahrung nicht zu heiß ist und keine wichtigen Nährstoffe verloren gehen. Neben dem langdauernden Erwärmen im Wasserbad können aber auch die richtige Dosierung des Milchpulvers und das Abmessen mühsam und zeitaufwendig sein.
Der Baby Brezza Formula Pro Advanced ist ein automatischer Flaschenzubereiter, der speziell für Babymilch entworfen wurde und für eine zuverlässige Zubereitung sorgt.
Innerhalb von 30 Sekunden werden Milchpulver und Wasser voll automatisch dosiert und vermixt und je nach Bedarf schonend auf die Raumtemperatur von 22 °C, 37 °C Körpertemperatur oder auf 40 °C erwärmt. Die sichere und hygienische Nahrungszubereitung ist für alle Babynahrungsmarken und alle Arten von Fläschchen geeignet. Der transparente Milchpulver-Behälter muss durch das extra große Fassungsvermögen nicht für jedes Fläschchen neu aufgefüllt werden und lässt sich für die hygienische Aufbewahrung luftdicht verschließen.
von Baby Brezza viel Unterstützung. Der Food Maker Deluxe kann auf Knopfdruck zerkleinern, mischen und dampfgaren und so in weniger als zehn Minuten eine gesunde Mahlzeit in einem platzsparenden Gerät vor- und zubereiten. Dank der wiederverwendbaren Lebensmittelbeutel mit praktischem Einfülltrichter können die Gerichte ganz leicht portioniert, eingefroren oder im Kühlschrank aufbewahrt werden.
Über den Safe & Smart Bottle Warmer ist auch das Erwärmen von Fläschchen mit zwei Heizfunktionen kinderleicht. Und der Baby Brezza Instant Warmer ist ein intelligenter Wasserspender, der jederzeit warmes Wasser mit der idealen Temperatur für die Zubereitung des Babyfläschchens bereitstellt.

Wer auch feste Nahrung fürs Baby aus frischen Zutaten selbst zubereiten und nicht nur auf fertige Gläschen zurückgreifen möchte, findet mit dem Multifunktionsgerät
Alle Brezza Geräte zeichnen sich über das digitale Display durch eine besonders hohe Bedienerfreundlichkeit aus. Da ein Großteil des Materials in direktem Kontakt mit der Nahrung gelangt, wird besonders viel Wert auf höchste Standards bei Qualität und Hygiene gelegt. Die praktischen Alltagshelfer bestehen aus beständigem, langlebigem Material wie Silikon, Polyprophylen und ABS und enthalten kein BPA. So ist zu jeder Zeit die bestmögliche Versorgung des Babys gewährleistet.
BabyBrezza

Im Jahr 2010 brachte Steven Betesh Baby Brezza auf den Markt, um die Art und Weise zu revolutionieren, wie Eltern ihre Babys füttern. Mit BabyBrezza spart man Zeit bei der Zubereitung der Mahlzeiten, damit Sie mehr Zeit für Ihr Baby haben! babybrezza.de
PETA– PARTNER CONTENT

Grünes Licht für kleine Veganer?

Vegane Ernährung ist auch für Babys und Kinder geeignet – sofern bestimmte Aspekte berücksichtigt werden. Eine Ernährungs-Expertin beantwortet häufige Fragen.
Über 1,5 Millionen Menschen in Deutschland ernähren sich vegan – der eigenen Gesundheit zuliebe und zum Wohl von Tieren und Umwelt. So ist die landwirtschaft liche Tierhaltung eine der Hauptursachen der größten Umweltprobleme unserer Zeit. Durch die globale Tierwirtschaft entstehen mehr Treibhausgase als durch den gesamten
Verkehrssektor. Butter beispielsweise gilt als klimaschädlichstes Nahrungsmittel überhaupt, danach kommt Rindfleisch und Käse und Sahne belegen den dritten Platz. Und der Widerspruch zwischen Tierliebe und Fleischkonsum stößt insbesondere bei Kindern bitter auf. Da sich die Ernährungsgewohnheiten eines Menschen bereits in frühester Kindheit festigen, kann eine vegane Ernährungsweise in diesem Alter die Weichen für eine tierleidfreie und umweltfreundliche Zukunft stellen. Doch ist sie auch für die Jüngsten gesund?
Warum haben manche Menschen beim Thema vegane Ernährung für Babys und Kinder Bedenken?
Können Kinder mit veganer Kost ihren wachstumsbedingt erhöhten Nährstoff bedarf komplett decken?
Bettina Eick, Biologin und Fachreferentin für Ernährung bei der Tierschutzorganisation

PETA Deutschland
Viele Menschen sind besonders vorsichtig, wenn es um ihre Babys geht. Oft sind Ärztinnen und Ärzte außerdem nicht auf dem neuesten wissenschaft lichen Stand, insbesondere, was die vegane Ernährung angeht. Daher raten sie Eltern oft zu Mischkost. Klar ist aber: Eltern müssen sich bei jeder Ernährungsform mit deren Besonderheiten auseinandersetzen. Ist das gegeben, spricht jedoch nichts gegen eine ausgewogene rein pflanzliche Ernährung für Babys und Kinder. Sie kann im Gegenteil gesundheitliche Vorteile haben und das Risiko für Krebs, Diabetes Typ 2 und Herz-Kreislauf-Erkrankungen reduzieren.
PETA Deutschland e.V. ist mit über 1,5 Millionen Unterstützenden landesweit die größte Tierschutzorganisation, die sich für die Rechte aller Tiere einsetzt. Durch Aufdecken von Tierquälerei, Aufklärung der Öff entlichkeit und Veränderung der Lebensweise soll jedem Tier zu einem besseren Leben verholfen werden. www.peta.de
Ja, eine ausgewogene vegane Ernährung ist auch für Babys und Kinder uneingeschränkt geeignet. Die American Academy of Nutrition and Dietetics hat bereits 2016 festgestellt, dass eine „gut geplante vegane Ernährung für alle Phasen des Lebens geeignet ist, einschließlich der frühen Kindheit und Jugend“. Kinder brauchen bestimmte Nährstoffe, um gesund zu sein und sich normal zu entwickeln. Beispielsweise brauchen sie Proteine. Diese müssen aber keineswegs vom Fleisch stammen – auch viele pflanzliche Lebensmittel enthalten jede Menge Eiweiß. Laut der VeChi-Youth-Studie der Deutschen Gesellschaft für Ernährung von 2020 nehmen vegane Kinder sogar mehr gesunde Lebensmittel wie Gemüse und Hülsenfrüchte zu sich. Auch die Versorgung mit Vitamin B12, das bei der veganen Ernährung supplementiert werden muss, war bei den veganen Kindern gut und sogar besser als bei Vegetarischen.

Was hat es mit den sogenannten kritischen Nährstoff en auf sich? Ernährungsgesellschaften geben für die vegane Ernährung sogenannte kritische Nährstoffe an, auf deren ausreichende
Deckung besonders geachtet werden sollte. „Kritisch“ bedeutet hierbei aber nicht, dass wer sich vegan ernährt, diese Stoffe wahrscheinlich oder zwangsläufig zu wenig zuführt. Kritische Nährstoffe gibt es in allen Ernährungsformen. Alle potenziell kritischen Nährstoffe können außerdem mit einer ausgewogenen veganen Ernährung – diese beinhaltet eine Vitamin B12-Supplementierung – problemlos gedeckt werden.
Hilfe zum Umstieg auf eine vegane Ernährung: www.veganstart.de
Weitere Infos: www.peta.de/veganleben/ vegane-ernaehrung
Foto : P E T A D e u t hcs l dna
11 FAMILIENGESUNDHEIT Eine unabhängige Kampagne
BABYBREZZA – PARTNER CONTENT
von Contentway
«
«
„Die Milch darf weder zu kalt noch zu heiß sein, 37 Grad gelten als ideale Trinktemperatur.“
„Die sichere und hygienische Nahrungszubereitung ist für alle Babynahrungsmarken und alle Arten von Fläschchen geeignet.“
fakten Autorin, Model und Infl uencerin Anna Adamyan (geborene Wilken, 26) ist seit 2014 mit dem Profi -Fußballer Sargis Adamyan zusammen. 2021 heirateten die beiden und leben gemeinsam mit Zwergspitz Oskar in Köln. Anna liebt Süßigkeiten und TrashTV. Zudem hat sie ihrer Endometriose einen eigenen Namen gegeben: Sie heißt Frieda.

Endo-App
Deineindividuelle
Unterstützungbei
Endometriose
www.endometriose.app







Scanneden QR-Code...

...underfahre,wie
dudieEndo-App erhaltenkannst:

Beobachten. Symptome undEinflussfaktoren protokollieren.
EndometrioseundangeleiteteÜbungenfürdenAlltag.
Therapieren. Auswertungen fürdeinenindividuellen Therapieansatz.

FAMILIENGESUNDHEIT Eine unabhängige Kampagne von Contentway 12
ANZEIGE
umgehen
Anna Adamyan:
Mit der Krankheit
lernen
großes interview
Endometriose ist eine der häufi gsten gynäkologischen Erkrankungen und mit starken Schmerzen verbunden. Infl uencerin Anna Adamyan kennt diese leider zu gut.
Text: Silja Ahlemeyer Foto: Anna-Lena Kreutz
Etwa jede zehnte Frau in Deutschland ist von Endometriose betroffen. Dabei kommt es zu schmerzhaften Wucherungen aus gebärmutterschleimhautähnlichem Gewebe, die etwa in den Eierstöcken, im Darm oder Bauch, aber auch in Zwerchfell und Lunge auftreten können. Auch Sie sind betroffen.
Ja, ich habe Endometriose und zugleich auch Adenomyose. Bei der Adenomyose tritt die gebärmutterähnliche Schleimhaut im Gebärmuttermuskel und in der Gebärmutterwand auf.
Wie hat sich Ihre Erkrankung anfangs bei Ihnen bemerkbar gemacht?
Schon mit elf Jahren hatte ich meine Periode, jedes Mal begleitet von starken Schmerzen. Als ich 13 war, äußerte meine Frauenärztin erstmals den Verdacht auf Endometriose, meinte aber, dass ich dafür eigentlich viel zu jung sei.
Wie lange hat es gedauert, bis der Befund vorlag?
Die Diagnose erhielt ich erst sechs Jahre später. Vorher standen mehrere
„EndometrioseBetroffene sind stark, denn sie halten viel aus – trotz immenser Schmerzen. Es ist wichtig, das auch selbst zu erkennen.“
Verdachtsmomente im Raum, wie „Das ist etwas Psychosomatisches“. Erst, als ich mit 18 nach Berlin ging, kam ich an die Charité zu Prof. Mechsner, die mich richtig ernst nahm. Sie leitet das Endometriose-Zentrum.
Was war der Auslöser, durch den diese Ärztin die genaue Diagnose stellen konnte?
Frau Mechsner ist sehr erfahren. Sie ließ mich beim ersten Termin fast einen fast 30-seitigen Schmerzbogen ausfüllen. Das ist dort eine ganz andere Diagnostik, als ich sie bisher kannte. Zudem ging der Termin über 60 Minuten, was bei herkömmlichen Gynäkologen und Gynäkologinnen zeitlich gar nicht möglich ist.
Wie hat die Krankheit Ihr Leben seitdem beeinfl usst?
Kurz nach der Diagnose hatte ich die erste von drei OPs. Leider habe ich jedoch davon nicht so profitieren können, dass ich heute schmerzfrei bin. Die Entzündungsherde treten immer wieder auf. Für mich bedeutet das, dass ich tatsächlich sehr oft richtig starke Schmerzen habe. Mit 19 war ich zum Beispiel zum Modeln in New York. Ich konnte das aber nicht genießen, da ich mindestens einmal in der Woche in die Gynäkologie-Notaufnahme fahren musste. Mein Sozialleben hat unter der Krankheit ebenfalls gelitten. Und ich musste mich viel rechtfertigen. Aber ich will mich nicht beschweren: Ich bin in einer privilegierten Situation, und ich habe gelernt, mit der Endometriose umzugehen.
Wie wichtig ist bei all dem die mentale Gesundheit?
Meiner Meinung nach sehr wichtig! Das richtige Mindset schützt zwar nicht vor Schmerzen, aber man kann anders mit ihnen umgehen. Wenn ich heute zum Beispiel ausgehen möchte, dann mache ich das, auch, wenn ich mit einem
Schmerzschub rechne. Ich bleibe so lange, wie es möglich ist und gehe dann nach Hause. Aber ich bin unterwegs gewesen, das ist ein wichtiger Punkt.
Welche Ratschläge geben Sie Frauen, die von unerklärlichen Schmerzen betroff en sind?
Jede Frau ist individuell. Was mir sehr geholfen hat, war, darüber zu sprechen und mein Umfeld zu integrieren. Man muss sich für sich selbst einsetzen und darf sich nicht abstempeln lassen nach dem Motto: „Ist doch nicht so schlimm“. Endometriose-Betroffene sind stark, denn sie halten viel aus trotz immenser Schmerzen. Es ist wichtig, das auch selbst zu erkennen.
Sie sind aktuell schwanger und erwarten demnächst einen kleinen Jungen. Bis Sie Ihren Mutterpass in den Händen halten konnten, haben Sie allerdings zehn erfolglose künstliche Befruchtungen und mehrere Fehlgeburten durchgestanden. Wie kam es, dass Sie nicht aufgegeben haben?
Ich habe ein sehr verständnisvolles Umfeld und einen tollen Mann, mit dem ich alles intensiv besprechen kann. Man muss auch sagen, wir haben den fi nanziellen Druck nicht – wie viele andere Betroffene, leider. Ich hatte immer die Möglichkeit, Hoff nung aufzubauen und zuzulassen. Und ich wurde bislang von wirklich tollen Ärztinnen begleitet.
Welche Tipps haben Sie speziell zum Umgang mit Endometriose bei gleichzeitigem Kinderwunsch?

Es ist wichtig zu wissen: Man ist mit der Krankheit nicht allein. Ich rate jeder Betroffenen, sich ausführlich über Endometriose zu informieren und dann zu entscheiden, welchen Weg sie gehen will. Und: Es gibt durchaus auch Betroffene, die auf natürlichem Weg schwanger geworden sind.
Ferti-Lily Kinderwunsch Empfängnishilfe –

Natürlich, sanft, hormonfrei, für zuhause

keit auf eine Schwangerschaft um 48% erhöht! Zahlreiche Paare haben schon bestätigt, dass sie nach Anwendung der Ferti-Lily ganz überraschend schwanger geworden sind, nach vielen erfolglosen Versuchen vorher.
Ferti-Lily wird nach dem Samenerguss eingeführt, sodass so viele Spermien wie möglich zum Muttermund und damit mehr Spermien in die Gebärmutter schwimmen können.
Gemeinsam Lesezeit gestalten
Wenn Eltern ihren Kindern regelmäßig vorlesen, fördert das nicht nur die Sprachkompetenz der Kleinen, sondern es stärkt auch die sozialen Bindungen in der Familie. Denn was ist schöner, als zusammen auf dem Sofa zu kuscheln und so miteinander ins Gespräch zu kommen? Für die gemeinsame Lesezeit mögen viele Kinder Geschichten, bei denen sie sich mit den Hauptfi guren identifizieren können. Im „großen Vorlesebuch von Lenny und Luka“ von Silja Ahlemeyer lernen zwei Brüder in drei bunt illustrierten Geschichten, warum Kompostwürmer Dünger pupsen, wie man sich aus einer Seenot rettet und wie es doch noch gelingt, sich nach dem großen Geschwisterstreit wieder zu vertragen. Das Buch ist gefördert von der Beauftragten der Bundesregierung für Kultur und Medien.
„Das große Vorlesebuch von Lenny und Luka“, Hardcover 18,50 € (ISBN 978-3-347- 86219-7); Softcover 12,50 € (ISBN 978-3-347-86218-0), erhältlich in allen gängigen Buchhandlungen oder auf www.kinderbuch-zum-vorlesen.de.

Text: Jakob Bratsch, Foto: Presse
ANZEIGE – ADVERTORIAL
Mutter zu werden ist für viele Frauen das größte Glück der Welt. Doch nicht immer klappt es auf Anhieb schwanger zu werden und die Erfüllung des Kinderwunsches dauert länger als erwartet.
Ferti-Lily verbessert die Chancen auf eine Schwangerschaft, ohne die Intimität zu
beeinträchtigen – ohne Hormone, Ärzte oder invasive Eingriffe.

Ferti-Lily wird nach dem Geschlechtsverkehr eingeführt und bringt mehr Spermien zum Gebärmutterhals. In einer klinischen Studie wurde erwiesen, dass die Verwendung von Ferti-Lily die Wahrscheinlich-
Ferti-Lily ist bequem und einfach anzuwenden, sie hält die Spermien am richtigen Ort fest, sogar beim Wasserlassen oder beim Duschen – für freie Bewegung nach dem Sex. Die Empfängnishilfe bietet hohen Komfort beim Einführen, Tragen und Entfernen, sie kann bis zu 6 Monate oder 6 Monatszyklen lang verwendet und dabei 20 bis 60 Minuten nach dem Verkehr getragen werden.

10 % Rabatt
Sichere Dir 10 % Rabatt auf Deine Erstbestellung* auf
www.ardoshop.de
Code: Ardo-Kinderwunsch2023

13 FAMILIENGESUNDHEIT Eine unabhängige Kampagne von Contentway
*Nur online einlösbar bis 30.04.2023, gilt nur für die Erstbestellung. Im Retourenfall verfällt der Rabatt. Änderungen vorbehalten. Nicht kombinierbar mit anderen Rabattaktionen.
SCHON NACH EINEM ZYKLUS HAT ES GEKLAPPT, SCHWANGER ZU WERDEN
www.ardo.de
“
PCOS steht für ‚Polyzystisches Ovar-Syndrom‘ und betriff t vor allem junge Frauen im gebärfähigen Alter. Hierbei treten kleine wassergefüllte Bläschen an den Eierstöcken auf, die den hormonellen Zyklus stören. Männliche Hormone werden überproduziert, worunter der Menstruationszyklus leidet. Haare fallen aus, wachsen dafür an unliebsamen Stellen, die Körperstatur wird männlicher, Akne kommt hinzu und der Kinderwunsch bleibt häufi g unerfüllt. So ist diese Hormonerkrankung für Betroff ene auch eine psychische Belastung. Ungefähr eine Millionen Frauen in Deutschlandsind sind davon betroff en.
Was die Krankheit hervorruft, ist nicht geklärt. Lediglich ein Zusammenhang zwischen Syndrom und Übergewicht ist festzustellen. Aber auch normalgewichtige Betroff ene können an einer Insulinresistenz leiden. Ihre Zellen reagieren dann nicht mehr auf das hormonelle Signal des Insulins, Zucker aus dem Blut aufzunehmen. Ihr Blutzuckerspiegel steigt, woraufhin der Körper immer mehr Insulin produziert. So haben Frauen mit PCO-Syndrom ein erhöhtes Risiko, an Typ-2-Diabetes zu erkranken. Auch wenn die Krankheit nicht heilbar ist, können die Symptome medikamentös gemildert werden.
Lipödem ist eine Fettverteilungsstörung, wobei sich vermehrtes Unterhautfettgewebe an Po, Hüften und Oberschenkel ansetzt. Diese Erkrankung kommt fast ausschließlich bei Frauen vor. Zusätzlich lagert sich dort Wasser ins Gewebe ein, wodurch ein Spannungsgefühl und Schmerzen in den betroffenen Körperregionen entstehen. Erst, wenn die Gewebeveränderungen diese Beschwerden hervorrufen, wird das Lipödem als Krankheit eingestuft. Doch die Diagnose ist nicht leicht, da es viele andere Erkrankungen gibt, die ähnliche Beschwerden verursachen. Deshalb wird das Lipödem bei manchen Menschen gar nicht oder erst in einem fortgeschrittenen Stadium diagnostiziert.
Wenn sich trotz konsequenter Lipödem-Therapie, wie zum Beispiel Kompression, Lymphdrainage und Bewegung, das Unterhautfettgewebe weiter vermehrt, wird eine Fettabsaugung empfohlen. Durch die sogenannte Liposuktion wird übermäßiges Unterhautfettgewebe chirurgisch entfernt. Die Liposuktion verbessert das Beschwerdebild der meisten Patientinnen über viele Jahre. Vor allem Schmerzen und die Bluterguss-Neigung lassen sich durch den Eingriff verringern. Oft entfallen nach der Fettabsaugung zudem konservative Maßnahmen oder sind nur noch in geringem Umfang nötig.



Mit dem Begriff ‚Zervixkarzinom‘ werden jene Tumore im unteren Bereich der Gebärmutter bezeichnet, die die Schleimhaut des Gebärmutterhalses (Zervix) bösartig verändern. Gebärmutterhalskrebs zählt zu den drei häufi gsten Krebserkrankungen bei Frauen unter 45 Jahren und verursacht in frühen Stadien meist keine Symptome.
Erst mit der Zeit machen sich die bösartigen Zellveränderungen mit Beschwerden, wie beispielsweise unangenehmen Scheidenausfl uss oder Blutungen nach körperlichen Anstrengungen wie Radfahren, Geschlechtsverkehr oder hartem Stuhlgang, bemerkbar. Frühe Stadien dieser Krebsart sind in der Regel heilbar. Selbst wenn der Tumor schon etwas weiter fortgeschritten ist – sich aber komplett operativ entfernen lässt – ist die Prognose noch günstig. Da das Zervixkarzinom in aller Regel durch eine chronische Infektion mit dem humanen Papillom-Virus (HPV) ausgelöst wird, senkt eine Impfung dagegen das Risiko an Gebärmutterhalskrebs zu erkranken erheblich. Sie ist eine von der Ständigen Impfkommission (STIKO) am Robert-Koch-Institut für alle Mädchen zwischen neun und 14 Jahren vor dem ersten Geschlechtsverkehr empfohlene Impfung.
Schlaf Dich gesund – Erdungsprodukte®

Unsere moderne Lebensweise hat uns von der Erde entfremdet. Wir tragen Schuhe mit Kunststoffsohlen und leben in Häusern. Dadurch haben wir den natürlichen Kontakt zur Erde verloren.
„Earthing“ bezeichnet den Vorgang sich physikalisch mit der Erdoberfläche zu verbinden und sich so mit negativ geladenen Elektronen aufzuladen. Studien zeigen, dass diese Elektronen eine positive Wirkung auf den Körper haben.

Durch den Einsatz von Erdungsprodukten® ist es auch zu Hause möglich, die Vorteile des Erdens in den Alltag zu integrieren, wie diese Kundin auf „Trusted Shops“ mit uns teilt:
„Vor ca. 3 Wochen haben mein Mann und ich angefangen auf dem Erdungslaken zu schlafen. Unser Schlaf verbesserte sich nach ein paar Tagen kontinuierlich, wir sind morgens nach dem Aufstehen deutlich ausgeruhter und haben tagsüber mehr Energie. Den stärksten Effekt haben wir aber nach der ersten Woche in Bezug auf chronische Schmerzen und Entzündungen bemerkt. Ich leide seit 22 Jahren an Fibromyalgie und habe besonders bei kaltem Wetter starke Schmerzen. Nach der 8. Nacht auf dem Laken waren meine Schmerzen so gut wie nicht mehr spürbar und es geht mir mit jedem Tag besser. Ich hätte es nie für möglich gehalten! Mein Mann leidet an einer chronischen Sehnenscheidenentzündungen welche seit 2 Jahren alle paar Wochen bei Überbelastung von vorne beginnt. Die Entzündung ging innerhalb von 3 Tagen komplett zurück und ist seitdem - ‚toi toi toi‘ - nicht wieder gekommen... Ich kann jedem nur wärmstens ans Herz legen sich mit dem Thema Erdung ernsthaft zu beschäftigen. “
(einsehbar unter: https://www.trustedshops.de/bewertung/info_XC092AF8E74A6F5F9622F895E72A0DC0E.html)

Diese Krebsart wird auch ‚Mamma-Karzinom‘ genannt und ist eine bösartige Geschwulst in der Brust. Bestimmte Zellen der Brust-Drüse verändern dabei ihre Gene und vermehren sich unkontrolliert. Sie wuchern in gesundes Gewebe und zerstören es dabei. Brustkrebs ist die häufi gste Krebserkrankung bei Frauen und verläuft in einigen Fällen sogar tödlich. Da Brustkrebs jedoch nicht gleich Brustkrebs ist, gibt es unterschiedliche Behandlungsmöglichkeiten, bei denen fast immer die Operation am Anfang steht.
Wie bei vielen anderen Krebsarten auch, ist die eigentliche Ursache unbekannt. Rechtzeitig erkannt und behandelt aber meist heilbar. Deshalb spielen hier Vorsorgeuntersuchungen und Früherkennung eine bedeutende Rolle: Knoten und Verhärtungen in der Brust oder jegliche Veränderung von Form, Größe oder Farbe können Anzeichen von Brustkrebs sein. Auch bei Einziehung der Brusthaut oder Brustwarze, Rötung und Schuppung der Brusthaut oder gar Austritt von Sekret aus einer Brustwarze sollte der Gang zum Arzt oder zur Ärztin selbstverständlich sein. Wie bei allen Frauenleiden gilt: Vorbeugen durch eine gesunde Lebensweise ist die beste Medizin.
ANZEIGE – ADVERTORIAL
Als Hersteller der Original Erdungsprodukte® bietet tz-gesundheit.de eine große Auswahl an hochwertigen Produkten, die dich optimal mit der Erde verbinden.
Besuche www.tz-gesundheit.de und entdecke die Welt der Original Erdungsprodukte®
Nutze jetzt den Rabattcode „welt23“ und erhalte 10% Rabatt!

FAMILIENGESUNDHEIT Eine unabhängige Kampagne von Contentway 14
PCO-Syndrom Gebärmutterhalskrebs
Texte: Christiane Meyer-Spittler
Lipödem
Brustkrebs
Foto: Mart Production/Pexels
Foto: Lucrezia Carnelos/unsplash
Foto: Wren Meinberg/unsplash
Foto: Michelle Leman/pexels
Lebensentscheidung Chemotherapie
Interview mit dem Geschäftsführer von Exact Sciences in Deutschland über die Fortschritte der Krebsdiagnostik und personalisierte Brustkrebstherapien.
Über 70.000 Frauen erkranken in Deutschland jährlich an Brustkrebs. Die Diagnose zieht den meisten Frauen den Boden unter den Füßen weg. Sowohl die Angst vor dem Tod als auch die Angst vor den Nebenwirkungen einer Chemotherapie schüren oft mals ein Gefühl von Kontrollverlust. Obwohl immer mehr Frauen an Brustkrebs erkranken, sinkt glücklicherweise die Zahl der Sterbefälle seit Jahrzehnten kontinuierlich. Denn rechtzeitig erkannt und leitliniengerecht behandelt, sind die meisten dieser Erkrankungen heilbar. So sind 88 Prozent der Patientinnen fünf Jahre nach der traumatischen Diagnose noch am Leben1. Allerdings bleibt die Angst vor einem Rückfall ein ständiger Begleiter im Leben der Betroffenen.
Herr Morawski, können Sie betroffenen Frauen ein wenig die Angst nehmen?
Brustkrebs ist heutzutage meistens gut heilbar. Wir haben in Deutschland ausgezeichnete Ärzte und Brustzentren, der medizinische Fortschritt entwickelt sich rasant. Beispielsweise kann man durch molekulare Diagnostik die Genaktivität eines Tumors analysieren und hat eine ganz neue Ebene an Informationen, auf deren Basis personalisierte Therapie-Ent-
scheidungen getroffen werden können. Für Patientinnen ist es sehr wichtig, zusammen mit dem Arzt, partizipative und fundierte Entscheidungen zu treffen, wie die Behandlung weitergeht. Nicht jede Brustkrebspatientin braucht eine Chemotherapie. Wenn die Entscheidung für oder gegen Chemo nur auf der Basis von „traditionellen“, also klinisch-pathologischen, Faktoren getroffen wird, kann es zu möglichen Fehleinschätzungen kommen, sodass Patientinnen zu viel oder zu wenig Chemo bekommen. Das könnte also zu „Über-“ oder „Untertherapie“ führen.
Wie kann dies verhindert werden?
Bei jeder Patientin ist der Tumor individuell und hat seinen eigenen „genetischen Fingerabdruck“. Das bedeutet, dass die Genaktivität in jedem Tumor unterschiedlich ist. Mittels umfassender Forschung hat Exact Sciences festgestellt, dass man an der Aktivität von 21 Genen im Tumor mit großer Wahrscheinlichkeit vorhersagen kann, ob eine rein anti-hormonelle Therapie ausreicht, oder ob Chemotherapie einen zusätzlichen Nutzen bringt2. Die Informationen, die wir aus der Genaktivität im Tumor erhalten, kann somit den Ärzten und den Patienten noch mehr Sicherheit in der Therapieentscheidung geben.
Was ist das Besondere an Ihrem Oncotype DX Breast Recurrence Score® Test und für wen kommt er in Frage? Der Oncotype DX® Test ist der einzige Test auf dem Markt, der den Nutzen

von Chemotherapie bei Hormonrezeptor-postivem, HER2-negativem Brustkrebs im Frühstadium vorhersagen kann 3. Zudem ist der Test in der Lage, die Rückfallwahrscheinlichkeit der Patientin zu bestimmen.
Wie wurde die Zuverlässigkeit des Tests geprüft?
Die Zuverlässigkeit des Tests ist mit sehr vielen wissenschaft lichen Studien belegt. Mehr als 20.000 Patientinnen haben an den prospektiven, randomisierten Studien teilgenommen, deren Daten in der realen klinischen Praxis mit vielen nationalen Studien eindeutig bestätigt wurden. Es ist bisher in der molekularen Diagnostik unerreicht, eine solche Datenbasis aufzeigen zu können. Auf Basis dieser Daten konnten bereits mehr als eine Million Patienten mit dem Oncotype DX® Test getestet werden.
„Bei jeder Patientin ist der Tumor individuell und hat seinen eigenen ‚genetischen Fingerabdruck‘.“
bedeutet, dass für sehr viele Patientinnen keine Kosten entstehen, wenn sie sich die zusätzliche Sicherheit in der Therapieentscheidung wünschen.
Was raten Sie Frauen generell und Betroff enen im Besonderen?
Jede Frau sollte sich selbst regelmäßig abtasten und defi nitiv zur Früherkennung gehen. Es ist auch wichtig, sich über gesundheitliche Themen zu informieren und mit Bekannten auszutauschen, denn informierte Frauen haben die Wahl.
Erwin Morawski, Geschäftsführer Exact Sciences Deutschland GmbH
„Die Informationen, die wir aus der Genaktivität im Tumor erhalten, kann somit den Ärzten und den Patienten noch mehr Sicherheit in der Therapieentscheidung geben.“
Wird der Test von der Krankenkasse übernommen?
Ja, der Test wird für Patienten mit Hormonrezeptor-positivem, HER2-negativem Brustkrebs im Frühstadium erstattet, wenn diese keine betroffenen Lymphknoten aufweisen4. Der Test ist außerdem für Patientinnen mit bis zu drei befallenen Lymphknoten validiert und kann auch für diese Patientinnen guten Gewissens eingesetzt werden5. Diese Patientengruppe bekommt den Test von den privaten Krankenkassen bereits erstattet. Das
Karin K erhielt im November 2012 die Diagnose „Brustkrebs im Frühstadium“. Heute erzählt sie von ihrer Erfahrung:
„Natürlich war die Diagnose ein Schock. Aber fast noch mehr Angst hatte ich vor der Chemotherapie und den vielen möglichen Nebenwirkungen. Einen möglichen Rückfall wollte ich natürlich auch nicht riskieren.“

Mit ihren Ärzten off en über diese Ängste zu sprechen, war der erste Schritt zu einer gemeinsamen Therapieentscheidung. Karin K. ist heute froh darüber, dass ihre behandelnde Ärztin sie ausführlich über den Oncotype DX® Test und die damit verbundene Hilfe bei der Therapieentscheidung aufgeklärt hat.
1Robert Koch Institut: Zentrum für Krebsregisterdaten: Brustkrebs (Mammakarzinom). 2019.
URL: https://www.krebsdaten.de/Krebs/DE/ Content/Krebsarten/Brustkrebs/brustkrebs_node. html;jsessionid=F2CF153C887BE0BFA5E677CFA784EDF1. internet051

2Sparano J. A. et al., New Engl J Med, 2018
3IQWIG: Rapid Report: [ D19-01] Biomarkerbasierte Tests zur Entscheidung für oder gegen eine adjuvante systemische Chemotherapie beim primären Mammakarzinom – Wissensstand, 2020. URL: https:// www.iqwig.de/de/projekte-ergebnisse/projekte/ nichtmedikamentoese-verfahren/d-projekte/d19-01biomarkerbasierte-tests-zur-entscheidung-fuer-odergegen-eine-adjuvante-systemische-chemotherapie-beimprimaeren-mammakarzinom-wissensstand.12356.html
4G-BA Beschluss: Banz AT 22.08.2019 B5. https://www.bundesanzeiger.de/pub/de/suchergebnis?6)
5Kalinsky K. et al., New Engl J Med, 2021
„Der genetische Fingerabdruck meines Tumors sprach für eine rein antihormonelle Therapie. Damit war meine Entscheidung gegen die Chemotherapie durch den Test ‚abgesichert‘ und viel einfacher. So war ich mir sicher, dass ich die richtige Wahl treffe.“
Für die Zukunft wünscht sie sich, dass mehr Frauen über die Möglichkeiten eines solchen Tests informiert werden und diese Informationen weitergeben. „Jede Patientin, die für den Test infrage kommt, sollte ihn beanspruchen. Und vor allem: Es ist wichtig, dass alle Frauen wissen, dass es ein solcher Test existiert. Denn nur, wenn das Wissen geteilt wird, kann vielen Betroff enen geholfen werden.“

15 FAMILIENGESUNDHEIT Eine unabhängige Kampagne von Contentway Oncotype
Exact
© 2023
Alle
www.exactsciences.com EXACT SCIENCES DEUTSCHLAND GMBH – PARTNER CONTENT «
DX und Recurrence Score sind eingetragene Warenzeichen von Genomic Health, Inc.
Sciences ist ein eingetragenes Warenzeichen der Exact Sciences Corporation.
Genomic Health, Inc.
Rechte vorbehalten
«
Foto E w n MkswaroE/isecneicStcax
„Es ist wichtig, dass alle Frauen wissen, dass ein solcher Test existiert, denn nur wenn Wissen geteilt wird, kann vielen Betro�enen geholfen werden.“
Wohltuende Entstauung
fettverteilungsstörung
Obwohl Lipödem und Lymphödem zwei unterschiedliche Erkrankungen sind, gibt es bei der Behandlung Überschneidungen.
Text: Kirsten Schwieger
Foto: Nothing Ahead/Pexels
Geschwollene Beine oder Arme – auf den ersten Blick scheinen Lip- und Lymphödem dieselben Symptome zu haben. Doch während beim Lipödem symmetrische Fettschwellungen an beiden Beinen oder Armen für Schmerzen sorgen, staut sich Lymphflüssigkeit im Gewebe von Armen oder Beinen beim Lymphödem meist nur auf einer Körperseite an – im Anfangsstadium auch schmerzfrei.

Die Ursachen der krankhaften Fettverteilungsstörung Lipödem sind vermutlich genetisch und hormonell bedingt. Nur Frauen erkranken daran, meist im Alter zwischen 20 und 30 Jahren. Rund
3,8 Millionen Frauen sind es offiziell in Deutschland, gut jede Zweite davon ist adipös. Allerdings basiert das vermehrte Unterhautfettgewebe nicht auf übermäßiger Gewichtszunahme und lässt sich auch nicht durch Diäten beseitigen. Auch ungefähr 90 Prozent der rund 80.000 Lymphödem-Betroffenen in Deutschland sind Frauen. Beim Großteil von ihnen ist
die Gewebeschwellung aufgrund von gestauter Lymphflüssigkeit nicht angeboren, sondern erworben. So wird das sekundäre Lymphödem in der Regel durch Operationen und Bestrahlungen im Rahmen einer Krebsbehandlung verursacht – oder durch den Tumor selbst. Dabei kann die Flüssigkeit aus den Zellzwischenräumen nicht mehr ausreichend über die Lymphbahnen abtransportiert werden und staut sich im Gewebe. Lymph- und Lipödem sind also zwei unterschiedliche Krankheiten, die erst in späten Stadien gemeinsam auftreten können. So kann sich aus einem Lipödem durch die vermehrte Ablagerung von Bindegewebe (Fibrosierung) zusätzlich ein Lymphödem entwickeln. Die Rede ist dann von einem Lipolymphödem.
Obwohl die beiden Krankheiten verschiedene Ursachen haben, gibt es Überschneidungen in der Behandlung. So werden Ödeme klassischerweise mit einer sogenannten Komplexen Physikalischen Entstauungstherapie (KPE) behandelt. Die KPE besteht aus mehreren aufeinander abgestimmten Komponenten. Ein wesentlicher Bestandteil sind physiotherapeutische Maßnahmen wie die manuelle Lymphdrainage (MLD). Durch diese spezielle Art der medizinischen Massage wird der Transport der Lymphflüssigkeit in den Lymphgefäßen durch sanfte Grifftechniken angeregt. Anschließend folgt eine Kompressionsbehandlung des betroffenen Areals mit speziellen komprimierenden Wechselverbänden und Kompressionsstrümpfen oder -bandagen. Die Kompression erleichtert den Abtransport gestauter Gewebeflüssigkeit. Auch entstauungsfördernde Bewegungstherapie ist Bestandteil einer KPE – idealerweise ergänzt durch entstauende Sportarten wie Nordic Walking oder Schwimmen. Eine KPE erstreckt
sich über mehrere Wochen – sowohl stationär als auch ambulant. Manche Betroffene begleitet sie ein Leben lang. Ziel der Behandlung ist, die krankhaften Schwellungen und etwaige begleitende Schmerzen zu reduzieren.
Lymphödem-Patienten wird zudem noch eine spezielle Hautpflege mit feuchtigkeitsspendenden Lotionen zuteil, falls erforderlich auch eine Hautsanierung. Übergewichtigen Lipödem-Betroffenen wird zusätzlich eine Gewichtsreduktion empfohlen. Auch operative Verfahren wie Fettabsaugung (Liposuktion) können Bestandteil der Lipödem-Behandlung sein und werden teilweise von den Krankenkassen übernommen.
Inklusion als Baustein für nachhaltige Familiengesundheit
Ein wesentlicher Bestandteil sind physiotherapeutische Maßnahmen wie die manuelle Lymphdrainage (MLD). Durch diese spezielle Art der medizinischen Massage wird der Transport der Lymphflüssigkeit in den Lymphgefäßen durch sanfte Grifftechniken angeregt.

Neue Software-App Harmody lindert Tinnitus
Harmonisierender Musikplayer verspricht mehr
Lebensqualität für Betroffene
Ab sofort spielt Musik auch eine Schlüsselrolle bei der Linderung von Tinnitus. Nach fast vier Jahren Entwicklungszeit steht die APP Harmody seit Ende 2022 in den gängigen APP-Stores zum Download zur Verfügung. Der Musikplayer harmonisiert den tonalen Tinnitus und bietet so eine nachhaltige Hilfe im Alltag von Betroffenen.

Die Harmody APP funktioniert dabei als klassischer Musikplayer, in den fast jegliche Wunschmusik integrierbar ist. Durch den patentierten Algorithmus gleicht Harmody die Tonalität des Musikstücks an den jeweiligen Tinnituston an. Dadurch wird der störende Ton direkt umspielt und verschwindet für den Nutzer. Die Verwendung von Harmody ist dabei denkbar einfach. Der betroffene Nutzer stimmt nur den in der APP integrierten Tonfinder auf seinen eigenen Tinnituston ab und kann die Musikstücke direkt abspielen. In Echtzeit
wird die Tonalität dann automatisch immer bestmöglich auf den Tinnituston angepasst.
Erfolgreiche HNO-Patiententests haben gezeigt, dass bei einer Verwendung von Harmody von 15 Minuten in den meisten Fällen ein Sofort-Effekt einsetzt und die Linderung einige Zeit anhält. Probanden konnten ihre Schlafund Konzentrationsstörungen deutlich minimieren.
Als Medizinprodukt ist die Harmody APP in die Risikoklasse I eingestuft und besitzt eine entsprechende CEZertifizierung. Die Entwicklung der APP mit all ihren Funktionen ist während der gesamten Entwicklungszeit eng mit Betroffenen erfolgt.
Man kann die App probeweise eine Woche vollumfänglich kostenlos testen.
www.harmody.de
Familie kann einen enormen Rückhalt bieten und als wertvolle Ressource dienen. Insbesondere die gemeinsame Bewältigung schwieriger Situationen kann nicht nur Stress reduzieren, sondern auch zur langfristigen Zufriedenheit aller Familienmitglieder beitragen. Da die Familie oftmals einen großen Platz im Leben einnimmt und uns von Kind auf prägt, sind die Familiengesundheit und eben ihr Erhalt besonders relevant. Dabei spielt die Inklusion von Familienmitgliedern mit z. B. körperlichen oder psychischen Beeinträchtigungen eine wichtige Rolle, wobei Inklusion statt Integration hier den wesentlichen Unterschied macht. Denn Krankheiten innerhalb der eigenen Familie können äußerst belastend sein, nicht nur für Betroffene selbst, sondern auch für die Angehörigen. Daher sind gegenseitiges Verständnis und Unterstützung umso wichtiger, um den Familienzusammenhalt zu stärken, was wiederum einen positiven Einfluss auf das Familienleben und die kollektive Gesundheit haben kann.
Text: Jenny Brania, Foto: Nathan Anderson/unsplash
FAMILIENGESUNDHEIT Eine unabhängige Kampagne von Contentway 16
Die Ursachen der krankhaften Fettverteilungsstörung Lipödem sind vermutlich genetisch und hormonell bedingt.
ANZEIGE – ADVERTORIAL
Weitere Infos zur effektiven Ödemtherapie unter: medi.biz/lipoedem und medi.biz/lymphoedem
Modisch und selbstbewusst mit mediven® Kompressionsstrümpfen




Flachgestrickte Versorgungen von medi in starken Farben und attraktiven Mustern – Ihre perfekten Therapiebegleiter!
besser.
medi. ich fühl mich
Bleiben Sie immer auf dem Laufenden auf unseren Social-Media-Kanälen:
In der Regel lohnt ein grüner Fußabdruck
nachhaltige menstruation

Jede Frau hat im Schnitt über vierzig Jahre ihre Periode. Rechnet man in Tagen den Bedarf an Hygieneartikeln hoch, kommen Unsummen von belastetem Müll zustande.
Text: Christiane Meyer-Spittler

Foto: Monika Kozub/unsplash
Umso mehr gilt es, gewohnte Produkte zu überdenken, die uns besonders nahe kommen. Herkömmliche Tampons enthalten zum Beispiel Polyethylen (PE) und Polypropylen (PP), giftige Erdöl-Produkte. Sie können durch die dünne Schleimhaut im Intimbereich direkt in den Blutkreislauf gelangen und sind biologisch nicht abbaubar. Bio-Tampons hingegen bestehen gänzlich aus biologischer Baumwolle und sind frei von Pestiziden, synthetischen Fasern, Zusatzstoffen oder Plastikrückständen. Zudem wird bei ihnen auf das Chlor beim Bleichen und anderen Chemikalien verzichtet.
Wer es noch natürlicher haben möchte, kann feine weiche Naturschwämme, sogenannte Menstruationsschwämmchen ausprobieren. Diese sind auf jeden Fall nachhaltig, da sie nachwachsen und wiederverwendbar sind. Feucht passen sie sich in Form und Größe individuell der Vagina an und trocknen sie weder aus noch stören sie die Intimflora. Nach Gebrauch werden diese Vulvi Pads einfach ausgewaschen und wieder eingeführt.
Auch Stoff-Slipeinlagen oder -Binden bestehen aus nachwachsenden Rohstoffen, wie Bio-Baumwolle, Hanf oder Bambusfasern, und kommen ebenfalls ohne Kunststoffe oder Chemikalien aus. Sie lassen sich in der Waschmaschine bis 60° waschen und sind laut Hersteller bis zu fünf Jahren wiederverwendbar. Öko-Bin-
den sind sogar bis zu drei Mal saugfähiger als herkömmliche Binden. Das kommt durch mehrere Schichten Mikrofasern, die kein Nässegefühl oder Geruch hinterlassen. Stoffbinden oder -einlagen reduzieren erheblich den Plastikmüll und die eigenen Ausgaben.
Öko-Binden sind sogar bis zu drei Mal saugfähiger als herkömmliche Binden.
Vielleicht ist auch Menstruationsunterwäsche eine passende Option. Die sogenannte Menstruations-Panty sieht aus wie ein normaler Slip, ist jedoch mit einer besonderen Einlage ausgestattet. Die erste Schicht leitet Flüssigkeiten schnell weiter und sorgt für Trockenheit. Darunter steckt die Sauglage, deren spezielle Technologie macht sie absorbierend und

antibakteriell. Sie kann zwischen zehn und 30 ml Flüssigkeit aufnehmen und unangenehme Gerüche verhindern. Die äußerste Hülle ist wasserdicht und lässt keine Flüssigkeit nach außen. Moderne Periodenunterwäsche lässt sich in der Waschmaschine hygienisch waschen und hält bei guter Pflege mehrere Jahre. So lohnt sich langfristig ihr höherer Einstiegspreis.
Eine größere Umgewöhnung bedarf es bei der sogenannten Menstruationstasse. Ihr flexibles Silikon trocknet die Schleimhaut nicht aus, womit die Vaginalflora im Gleichgewicht bleibt. Ihre Trichterform hat ein größeres Fassungsvermögen als ein Tampon und kann bis zu zwölf Stunden getragen werden. Nach Gebrauch wird sie einfach geleert, heiß ausgespült und gleich wieder verwendet. Sie kann bis zu zehn Jahre im Einsatz sein und damit enorm viel Hygienemüll und verstopfte Toiletten vermeiden.
Bei einer ökologischen Umstellung lohnt auch ein Blick auf die Intimpflege. Laut Experten reicht klares Wasser ohne spezielle Duschgels oder Seifen für die tägliche Reinigung völlig aus. Der Intimbereich ist mit seinem pH-Wert von 3,8 bis 4,4 deutlich saurer als die restliche Haut. Mit diesem niedrigen pH-Wert schützt sich die Vagina vor Infektionen, denn das saure Milieu behindert das infektionsauslösenden Bakterienwachstum und die Vermehrung von potenziell schädlichen Pilzsporen.
Moderne Periodenunterwäsche lässt sich in der Waschmaschine hygienisch waschen und hält bei guter Pflege mehrere Jahre.
Warum uns die Periode im Alltag nicht mehr einschränken sollte
Wir schreiben das Jahr 2023 und noch immer ist das Thema Periode ein Tabu für viele Frauen und Männer. Snuggs hat es sich zur Aufgabe gemacht, dies zu ändern. Mit der Periodenunterwäsche von snuggs tut man nicht nur seinem Körper etwas Gutes, sondern auch der Umwelt. Wer hier denkt, dass sich dies doch mit Sicherheit wie eine Windel anfühlen muss, der liegt falsch. Das Unternehmen von Linda Sejdova (CEO, CMO) und Tomas Zahradnik (COO) bietet acht verschiedene Schnitte in unterschiedlichen Saugstärken in den Größen XXS bis 4XL an. Die Höschen sind neben Deutschland, Tschechien, der Slowakei, Österreich und den Niederlanden auch in England im Online-Shop erhältlich.
Was macht snuggs so besonders?
In Zusammenarbeit mit Textilingenieur:innen und Gynäkolg:innen hat snuggs die fortschrittlichste Technologie entwickelt. Mit 1,5mm ist die antibakterielle Schicht die Dünnste auf dem Markt. Der Tragekomfort gleicht hier der einer normalen Unterwäsche und durch die antibakterielle Beschichtung werden 99% der Bakterien vernichtet. Dabei greift snuggs auf HighTech-Materialien mit Öko-Text-Zertifizierung zurück.
Kund:innen schätzen Nachhaltigkeit, Sicherheit und Tragekomfort „Unsere Periodenunterwäsche gibt menstruierenden Menschen ein bequemes, natürliches Gefühl und verbindet so körperliches und emotionales Wohlbefinden mit Materialtechnik und Mode-Trends“, so Linda Sejdova, Co-Gründerin von snuggs. Im Gegensatz zu anderen Periodenprodukten entstehen dabei keine Unmengen von Plastikmüll. Die Träger:innen unterstützen nachweislich die Umwelt durch die Reduktion von CO2, Wasser und Abfall. Um dieses Vorhaben noch weiter zu unterstützen, wurde vor wenigen Wochen ein weiterer Schritt in Richtung Nachhaltigkeit gemacht: Statt des bisher verwendeten Nylons, setzt das Unternehmen fortan auf recyceltes Nylon und reduziert somit die Kohlenstoffemissionen um 80 % und den Wasserverbrauch um 99 %.

Zukunftspläne
Das Potential von snuggs haben auch namenhafte Investor:innen erkannt und erst kürzlich 5 Millionen Euro in das Unternehmen investiert.Snuggs arbeitet außerdem stetig daran, das Produktportfolio zu erweitern. So können sich die Kund:innen dieses Jahr auf viele weitere Modelle, Schnitte und Farben freuen. www.snuggs.de
FAMILIENGESUNDHEIT Eine unabhängige Kampagne von Contentway 18
Das flexible Silikon der Menstruationstasse trocknet die Schleimhaut nicht aus, womit die Vaginalflora im Gleichgewicht bleibt.
ANZEIGE – ADVERTORIAL
Tomas Zahradnik (links) und Linda Sejdova, Gründer:innen
Die Menstruation – das natürlichste der Welt! Mit HERA organics Menstruationsschwämmen wird die Periode wieder zu einem 100% natürlichen Erlebnis ohne Plastik und künstliche Zusatzstoffe. Ganz nach unserem Motto: Gut für deinen Körper, gut für die Umwelt. Aber was genau ist ein HERA organics Menstruationsschwamm und was sind seine Vorteile?


Herkömmliche Menstruationsprodukte bestehen bis zu 90 % aus synthetischen Stoffen wie Plastik. Im Gegensatz dazu entspricht der HERA organics Menstruationsschwamm zu 100% einem Naturprodukt aus dem Meer. Die Schwämme stammen aus einer nachhaltigen Ernte in Griechenland und wachsen innerhalb weniger Monate in kontrollierten Gewässern nach, ohne dass die Meeresfauna beeinträchtigt wird. Der HERA organics Menstru-
ationsschwamm ist das einzige Zero-Waste Menstruationsprodukt auf dem Markt, das wiederverwendbar und biologisch abbaubar ist. Nach einer Anwendungsdauer von 2-3 Monaten wird der Schwamm im Bio-Müll entsorgt und somit komplett der Natur zurückgegeben. Auf diese Weise produziert man keinen Müll für die Umwelt und das Badezimmer bleibt frei von (Plastik-)Müll. Der HERA Menstruationsschwamm zeichnet sich durch seine weiche und feinporige Struktur aus, die sich beim Tragen jedem Körper anpasst. Er ist niemals spürbar und kann die Flüssigkeit von bis zu 3 Tampons aufnehmen. Der HERA Menstruationsschwamm kann in jeder Lebenssituation, sei es im Alltag, beim Sport oder im Spa getragen werden. Auch während des Geschlechtsverkehrs kann er verwendet werden, ohne dass es zu Blutfl ecken oder Beeinträchtigungen beim Tragen kommt.
Warum HERA organics?























































HERA organics ist eine Schweizer Marke, die für höchste Qualität und Nachhaltigkeit steht. Die HERA Menstruationsschwämme werden in mehreren Laboren geprüft und sind zugelassen. Die Lieferanten unterliegen kontinuierlichen Qualitätskontrollen und das Team wird von einer Schweizer Frauenärztin fachlich unterstützt. Die HERA organics Menstruationsschwämme sind in mehreren Frauenarztpraxen vertreten. HERA organics repräsentiert einen nachhaltigen Lebensstil, der einen bewussten Umgang mit unserem Körper und der Umwelt fördert.


Speziell für DIE WELT-Leserinnen bieten wir die Schwämme für € 21,95 während 1 Woche an. Einfach QR Code scannen und sparen!














ANZEIGE
ADVERTORIAL
Eine Nachhaltige Menstruation mit HERA organics aus der Schweiz durch den Einsatz von natürlichen Menstruationsschwämmen
Gegründet wurde HERA organics von den beiden besten Freundinnen und Jungunternehmerinnen Valentina (24) und Naomi (26).
Good food, bad food
ernährungstipps
Die Wechseljahre haben oft Beschwerden, Gewichtszunahme und ein erhöhtes Krankheitsrisiko im Gepäck. Mit gesunder Ernährung lässt sich gut dagegen steuern.
Text: Kirsten Schwieger
Foto: Piero Istrice/unsplash
In den Wechseljahren verändert sich der weibliche Hormonhaushalt stark. Die Gelbkörperhormone sinken, die Östrogene spielen verrückt bis sie dauerhaft zurückgehen. Diese Umstellungsphase wird bei nicht wenigen Frauen von Beschwerden wie Hitzewallungen, Schweißausbrüchen sowie Schlaf- und Verdauungsstörungen begleitet. Manche Frauen nehmen in der Zeit auch an Gewicht zu, was allerdings nicht nur der hormonellen Umstellung, sondern generell dem Älterwerden geschuldet ist. So senkt der ausbleibende Eisprung zwar den Energieverbrauch des weiblichen Körpers, doch auch der altersbedingte Verlust von Muskelmasse führt zu einem niedrigeren Grundumsatz. Altersbedingt weniger Bewegung und ein langsamerer Stoff wechsel verstärken oftmals eine Gewichtszunahme. So benötigt eine 50-jährige Frau täglich um die 400 Kalorien weniger als eine 25-Jährige.
Doch die Wechseljahre können nicht nur Gewichtszunahme und Wechseljahresbeschwerden im Gepäck haben,
sondern auch ein erhöhtes Risiko für Krankheiten. So kann sich die Veränderung des Hormonspiegels auch auf die Körperfettverteilung auswirken, welche sich dann auf den Bauchbereich verlagert. Bauchfett aber setzt entzündungsfördernde Botenstoffe frei, schwächt das Immunsystem und erhöht das Risiko für Herzkrankheiten, Typ-2-Diabetes und Krebs. Auch der Wegfall der positiven Wirkung von Östrogen auf Blutdruck und Cholesterinspiegel steigert das Herzinfarkt-Risiko – genauso wie eine sinkende Konzentration des „guten“ Cholesterins HDL im Blut. Darüber hinaus führt fehlendes Östrogen zu Abbauprozessen in den Knochen.

Aus diesen Gründen ist eine ausgewogene, protein- und ballaststoff reiche Ernährung mit gesunden Fettsäuren und wenig leeren Kohlenhydraten ab den Wechseljahren für Frauen noch wichtiger als vorher. Vollwertprodukte und die gemüsereiche „Mittelmeerdiät“ versorgen den Körper mit vielen unverzichtbaren Makro- und Mikronährstoffen. Tierisches und pfl anzliches Eiweiß sorgen für den Muskelerhalt – idealerweise aus hellem Fleisch, Fisch, mageren Milchprodukten oder Hülsenfrüchten. Während das Fleisch eher mager sein sollte, darf der Fisch gerne fettreich sein, denn Lachs, Makrele und Hering schützen mit gesunden Omega-3-Fettsäuren Herz und Gefäße. Auch hochwertige Öle wie Oliven-, Walnuss-, Lein- oder Weizenkeimöl bein-
halten mehrfach ungesättigte Fettsäuren und wertvolle Pfl anzenstoffe. Hartkäse, Nüsse und Naturjoghurt sorgen für eine ausreichende Kalziumzufuhr, welche den Knochenabbau verlangsamt. Auch Vitamin D ist wichtig, da es die Aufnahme von Kalzium im Körper fördert.
Die Finger lassen sollten Best Agerinnen dagegen von leeren Kohlenhydraten wie Weißmehl und Zucker sowie von Fertigessen und Fast Food, die per se viel Zucker, Salz und ungesunde, gesättigte Fette enthalten. Diese haben, neben der Gewichtszunahme mit ihren Folgeerkrankungen, auch direkte negative Auswirkungen auf den Blutzuckerspiegel und die Cholesterinwerte. Auch mit scharfen Gewürzen und Alkohol sollten Frauen in den Wechseljahren sparsam sein, da sie typische Wechseljahresbeschwerden verstärken können.
fakten
In den Wechseljahren (Klimakterium) neigt sich die Reserve der Eizellen dem Ende zu und die Eierstöcke verringern allmählich ihre Hormonproduktion. Der Eisprung wird unregelmäßig. Mit dem letzten Eisprung setzt die Menopause ein. 12 Monate später beginnt dann die Postmenopause. Bis zum kompletten Abschluss der hormonellen Umstellung vergehen in der Regel dann noch einige weitere Jahre.
Warum Mikronährsto�e im Alter besonders wichtig sind
Verminderter Appetit und Geschmackssinn sowie Kaubeschwerden führen dazu, dass viele ältere Menschen zu wenig essen. Zwar sinkt im Alter der Kalorienbedarf, nicht aber der Bedarf an Mikronährstoff en. Lange Lagerzeiten von Gemüse, Weichkochen und Wiederaufwärmen reduzieren darüber hinaus die Nährstoff dichte vieler Mahlzeiten. Hinzu kommt, dass mit zunehmendem Alter auch die Fähigkeit des Magen-Darm-Trakts zur Aufnahme von Nährstoff en abnimmt, wodurch deren Bioverfügbarkeit sinkt. Hoher Medikamentenkonsum kann die Nährstoff aufnahme weiter vermindern. So ist zu erklären, dass nicht wenige Senioren einen Mangel an Vitaminen, Mineralstoff en, Spurenelementen oder sekundären Pfl anzenstoff en aufweisen. Dabei bedürfen zahlreiche Krankheiten einer erhöhten Nährstoff zufuhr. Doch auch gesunde Best Ager haben altersbedingt einen höheren Bedarf an wasserlöslichen Vitaminen wie Vitamin C, B6, B12 und Folsäure. Ohne ausreichende Versorgung mit Vitaminen, Mineralstoff en und Spurenelementen wird das Immunsystem geschwächt und der Mensch anfälliger für Infektionen und Krankheiten. Ist eine bedarfsgerechte Versorgung mit Mikronährstoff en nicht gewährleistet, sollten in Absprache mit dem Arzt Nahrungsergänzung auf den Tisch kommen.

FAMILIENGESUNDHEIT Eine unabhängige Kampagne von Contentway 20
Die ideale Ernährung in den Wechseljahren basiert auf Obst, Gemüse und Vollkornlebensmitteln.
Text: Kirsten Schwieger Foto: Polina Tankilevitch/pexels
Ohne ausreichende Versorgung mit Vitaminen, Mineralstoffen und Spurenelementen wird das Immunsystem geschwächt und der Mensch anfälliger für Infektionen und Krankheiten.
Nahrungsergänzung?
Würden Sie jeden Tag eine rohe Leber essen, um Ihren Nukleotid-Haushalt zu versorgen? Vermutlich nicht. Nukleotide sind ein Beispiel von vielen für Nährstoffe, die unser Körper benötigt. Für die DNA, für die Energiegewinnung oder für das Wachstum. Unser Körper kann zwar grundsätzlich Nukleotide selbst herstellen, allerdings nur bis zu einer bestimmten Menge. Häufig reicht die Eigenproduktion nicht aus und wir brauchen zusätzliche Nukleotide. Hier helfen Nahrungsergänzungsmittel.
Der Markt für Nahrungsergänzung ist aber vielfältig und unübersichtlich. Man kann nur schwer einschätzen, welche Produkte für einen richtig sind. Konsumenten können Qualitätsunterschiede oft nicht erkennen.
Neben den Versprechungen auf der Packung und dem Preis-Leistungs-Verhältnis ist aber vor allem ein Punkt ent-
Ein Monopräparat ist ein Nahrungsergänzungsmittel, das nur einen einzelnen Wirkstoff enthält und meist hoch dosiert angeboten wird.
scheidend bei der Auswahl des richtigen Produkts: Der Nutzen für den Körper. Und dabei gibt es einen sehr entscheidenden Unterschied zwischen Komplexprodukt und Monopräparat.
Mono- oder Komplexprodukt?
Das kommt darauf an!
Ein Monopräparat ist ein Nahrungsergänzungsmittel, das nur einen einzelnen Wirkstoff enthält und meist hoch dosiert angeboten wird. Typische Beispiele sind Magnesium-Tabletten, Omega-3-Kapseln oder Vitamin-C aus der Drogerie. Hier fehlt dem Menschen oft nur ein spezieller Mikronährstoff und er muss diesen ergänzen.
Komplexprodukte hingegen enthalten – wie der Name schon sagt – mehr als einen Nährstoff. Die Produkte zielen entweder darauf ab, alle Stoffe einer Gruppe (zum Beispiel alle B-Vitamine) zuzuführen oder Mängel auszugleichen (beispielsweise ernährungs-, sport- oder krankheitsbedingt). Bei Nahrungsergänzung mit mehreren aufeinander abgestimmten Nährstoffen ist der Gehalt der einzelnen Inhaltsstoffe meist etwas niedriger als im Monopräparat.
Mehr Inhaltsstoffe haben klare Vorteile Sowohl Mono- als auch Komplexprodukte haben ihre Berechtigung. Aber um Nahrungsergänzung sinnvoll zu verwenden und einen möglichst großen
Ja, aber richtig!
Nutzen aus ihr zu ziehen, stellen Komplexprodukte die bessere Alternative dar. Das lässt sich am besten anhand der Mitochondrien veranschaulichen.
Mit jedem Atemzug, jeder Bewegung und jedem Gedanken verbrauchen wir Energie. Allein das Gehirn benötigt im Schnitt 500 Kilokalorien am Tag. Fast jeder biochemische Prozess des Körpers benötigt Energie, um ablaufen zu können. Genau diese Energie liefern uns die Mitochondrien. Das sind winzig kleine Zellorganellen, die gerne auch als „Energiekraftwerke unseres Körpers“ bezeichnet werden.
Damit sie optimal arbeiten können, benötigen sie viele verschiedene Stoffe, wie die bereits erwähnten Nukleotide oder auch Vitamine, Mineralstoffe, Spurenelemente und Aminosäuren.

Zur Veranschaulichung stellen Sie sich einmal vor, sie steigen in ein Flugzeug, um in den Urlaub zu fliegen. Nur leider ist der Flieger nicht betankt, das Gepäck liegt noch auf dem Rollfeld und der Pilot steht im Stau. Dann wird es erstmal nichts mit Urlaub. Und es bringt auch nichts, wenn das Gepäck schnell verladen wird. Pilot und Treibstoff fehlen immer noch.
Genauso ist es, wenn den Mitochondrien einzelne Komponenten fehlen. Kein Pilot, kein Flug – keine Nährstoffe, keine Energie.
Sie möchten mehr über MITOcare erfahren und unsere Produkte selbst ausprobieren? Dann folgen Sie dem QR-Code oder gehen Sie auf www.mitocare.de/pages/welt. Dort finden Sie viele weitere Informationen, wissenschaftliche Artikel und natürlich unsere MitochondrienProdukte – mit dem speziellen 15 %-Rabattcode (WELT15), exklusiv für die Leser der WELT.
Um Nahrungsergänzung sinnvoll zu verwenden und einen möglichst großen Nutzen aus ihr zu ziehen, stellen Komplexprodukte die bessere Alternative dar.
Spezielle Nährstoffkombinationen, also Komplexprodukte, sind hier die Lösung. Denn sie sind auf die verschiedenen Bedürfnisse des Körpers, wie zum Beispiel den Mitochondrien abgestimmt.
Woher wir das wissen?
MITOcare engagiert sich seit 10 Jahren in der Forschung und Entwicklung von Mikro- und Makronährstoffen. MITOcare Produkte sind gemeinsam mit Medizinern entwickelt und geeignet für den Alltag, den Sport und ein besseres Leben. Mit einem großen Netzwerk an Ärzten und Therapeuten, einer eigenen Akademie und vielen Partnern, wie der Kölner Liste® für Doping-freie Nahrungsergänzung, dem Olympiastützpunkt Bayern oder den Weltmeistern des Deutschen Hockey-Bundes, gehört MITOcare zu den führenden Anbietern von komplexen, innovativen Nährstoffen.
21 FAMILIENGESUNDHEIT Eine unabhängige Kampagne von Contentway
MITOCARE – PARTNER CONTENT «
«
Fasten – eine Lösung zur Heilung
heilfasten
Fasten in der Nacht, kennt jeder: Auf Englisch heißt das Frühstück ‚breakfast‘, fastenbrechen. Doch durch Nichts zu heilen, fällt uns schwer vorzustellen.
Text: Christiane
Foto:
Kammholz
Meyer-Spittler
Andrea Piacquadio/pexels
Das Fasten wird häufig als Verzicht auf Essen wahrgenommen und ist damit negativ besetzt. Darum ist das Wissen und Vertrauen in diese Heilmethode Grundvoraussetzung für den Heilerfolg einer Fastenkur.
Fasten ist ein Urprinzip der Natur. Das Energie-Lieferprogramm wird von außen nach innen umgeschaltet. Statt Zucker aus der Nahrung wandelt die Leber Fettsäuren in Energie um, und zwar aus körpereigenem Speicherfett. Man nennt das auch Ketose. Das Umschalten auf dieses Energie-Programm läuft beim Fasten automatisch ab. Ungefähr 30% spart ein Organismus hierbei an Energieaufwand ein. Diese Energie kann er nun für Reparaturmechanismen verwenden. Jede einzelne Zelle befreit sich dabei von ihrem aufgestauten orga-
nischen Müll. Das setzt Regenerationsprozesse in Gang für die sonst keine Zeit ist. Dadurch purzeln nicht nur Kilos, sondern auch alle schädlichen Stoffe, die im Fettgewebe eingelagert sind. Diese körperlichen Prozesse spüren wir auch psychisch, fühlen uns leichter, freier und kraftvoller. Es können sogar psychische Belastungen besser verarbeiten werden, womit die Bereitschaft auf Neues steigt.
Setzt man diese Erneuerungsprozesse gezielt ein, spricht man vom sogenannten Heilfasten. Während gesunde Menschen zur Gewichtsabnahme oder Entgiftung unbedenklich selbstständig zu Hause fasten können, sollte das gezielte Heilfasten zur Therapie einer speziellen Krankheit nur in Absprache mit einem Facharzt geschehen. Bestimmte Beschwerden oder Erkrankungen lassen sich auf diese Art verbessern oder gar heilen. In dem der Körper seine Energie für die Verdauung spart, können die Selbstheilungskräfte einsetzen. Als Therapie wirkt das Heilfasten besonders gut bei ernährungsbedingten Stoff wechselerkrankungen, wie Diabetes, Gicht oder Fettleber, allergischen oder rheumatischen Beschweren, bei Bluthochdruck oder chronischen Hauterkrankungen.
Im „Fasten in guter Atmosphäre und unter ärztlicher Aufsicht“ sah schon einer der Begründer Dr. Otto Buchinger den „Königsweg der Heilkunst“. Die Ausweglosigkeit seiner Rheuma-Behandlung durch die damalige Schulmedizin brachte ihn zum Studium alternativer Heilmethoden. 1920 gründete er das „Kurheim Dr. Otto Buchinger“ aus dem weitere Buchinger-Kliniken hervorgingen.
Unter dem Heilfasten nach Buchinger versteht man eine „niederkalorische Trinkkur“ von der der Körper etwa 250 Kalorien erhält. Es werden nur Mineralwässer, Kräutertees, Obst- und Gemüsesäfte so wie Gemüsebrühe zu sich genommen. Der Körper erhält so weder Fett noch Eiweiß, was Verdauung und Stoff wechsel schont, aber alle notwendigen Vitamine, Mineralien und Pfl anzenstoffe. Entscheidend dabei ist, dass diese Getränke sehr langsam getrunken, fast wie eine Suppe gelöffelt werden.
Dabei wird jeder Schluck gekaut, damit die Speichel- und Verdauungsdrüsen angeregt werden, um die konzentrierten Nährstoffe bestmöglich zu verwerten. Auf diese Weise wird ein Getränk zu einer Mahlzeit und sättigt auch so. Hungergefühle kommen sehr selten auf, dagegen überwiegen die einsetzenden positiven Gefühle.
fakten
Beim Fasten fi ndet durch die veränderte Darmfl ora eine hormonelle Umstellung im Körper statt. Nach den ersten drei Tagen steigt der Serotoninspiegel, das Glückshormon, dauerhaft an. Das führt dazu, dass Fastende ausgeglichener und entspannter werden. Sie fühlen sich im Einklang mit sich selbst und ihrem Körper.
Warum gibt es immer noch weniger Unternehmerinnen als Unternehmer?
Ich glaube, noch trauen sich Frauen einfach zu wenig zu. Vor allem spielt da natürlich die historisch bedingte Rollen- und Aufgabenverteilung noch immer eine große Rolle. Wir sehen jedoch in unserer täglichen Arbeit, dass der Trend in die richtige Richtung zu mehr Balance geht und wir sind überzeugt: The Future is female.
Wieso Female Empowerment?
Wirklich die sein, die wir schon immer sind. Das machen, was wir wollen, und das: „No matter what“ ist etwas, das vor allem wir Frauen wieder lernen dürfen. Uns in allen Farben und Facetten akzeptieren und lieben: Das braucht Power und Mut.

Wie können Frauen ihr Potenzial voll entfalten?
Indem wir für unsere eigenen Wünsche, Werte und Bedürfnisse und vor allem füreinander einstehen. Härte und Ellbogen-Mentalität war gestern. Indem wir uns gegenseitig mit Herz und Hirn supporten, erschaff en wir ein Umfeld, in dem jede Frau die sein kann, die sie wahrhaftig sein will.
Text: Kirsten Schwieger, Foto: Presse
ANZEIGE

HÖHER, SCHNELLER, WEITER. TIEFER, LANGSAMER, NÄHER.
FAMILIENGESUNDHEIT Eine unabhängige Kampagne von Contentway 22
Veronika Kammholz, Geschäftsführende Gesellschafterin der a bit of color & FRIENDS GmbH
3Fragen an Veronika
TANNERHOF Mein Versteck in den Bergen www.tannerhof.de
Die hormonelle Umstellung im Körper spüren wir auch psychisch, wir fühlen uns leichter, freier und kraftvoller.
Richtig regenerieren
fitness
Genauso wichtig wie Sport sind die Ruhephasen zwischen den Trainingseinheiten. Eine gute Mischung aus aktiver und passiver Entspannung ist dabei zielführend.
Text: Kirsten Schwieger
Foto: Cottonbro/pexels
Sport hält länger jung, gesund und erhöht die Lebenserwartung. So beugt Bewegung vielen Krankheiten vor, reduziert den Abbau von Muskelmasse und stärkt die Körperkontrolle. Der Stoffwechsel kommt in Schwung und die Fettverbrennung wird angekurbelt. Eine Kombination aus Ausdauer, Kraft und Beweglichkeit deckt viele Gesundheitsaspekte ab und erzielt die besten Trainingseffekte. Es gibt also keinen Grund, im Alter mit dem Sport aufzuhören. Beziehungsweise viele Gründe, auch noch als Best Ager damit anzufangen – auch trotz kleinerer Zipperlein, Gelenkbeschwerden, Herzprobleme oder Krankheiten wie Diabetes. So eignen sich viele Sportarten für die Generation 50Plus. Zu deren beliebtesten zählen Nordic Walking, Schwimmen, Radfahren, Wandern und Joggen. Aber auch Tanzen, Trampolinspringen, Rudern und
moderates Krafttraining erfreuen sich großer Beliebtheit. Grundsätzlich sollte dem Sporttraining eine ärztliche Untersuchung vorangehen.
Ist man erst einmal dabei, ist kontinuierliches Training wichtig – mindestens drei Sporteinheiten pro Woche werden empfohlen. Doch genauso bedeutsam wie moderate Trainingseinheiten sind Pausen für die Regeneration. Während dieser Erholungsphasen werden verbrauchte Stoffwechselprodukte abtransportiert und Energiereserven aufgefüllt. Abgesehen davon stellt sich erst in der Regenerationsphase ein Trainingserfolg ein – sowohl in puncto Ausdauer als auch Muskelwachstum. Wie lange diese Ruhephasen dauern sollten, lässt sich nicht pauschalisieren. Es hängt vom Alter, dem persönlichen Trainingszustand sowie der Intensität der Belastung ab, wie lange der Körper zur Erholung braucht. Die generellen Empfehlungen variieren zwischen 24 und 72 Stunden.
Für die Regeneration empfiehlt sich ein Mix aus aktiver und passiver Entspannung. Den Anfang der Regeneration macht bereits das Cool-down zum Abschluss der Trainingseinheit. Dieses
Stress-Auszeit: Wie muss sie sein, damit sie wirkt?
Eine gezielte Auszeit kann die chronische Stressbelastung signifikant reduzieren – WENN sie richtig gestaltet wird.
Bad Reichenhall – Über 70% der Erwerbstätigen fühlen sich gestresst, 33% erschöpft und ausgelaugt. Ein chronisch erhöhter Stresslevel ist das Problem unserer Zeit. Wir können an der hohen Belastung in vielen Fällen wenig ändern – also ist es an uns, damit besser umgehen zu lernen. Und doch kann in nur einer Woche Auszeit tatsächlich eine nachhaltige Trendwende erzielt werden – eine große Chance für jeden. Nichtstun oder Aktivität?
Wichtig zu wissen: Weder das „süße Nichtstun“ noch Bewegung alleine führen zum gewünschten Erfolg. Entscheidend ist die richtige Kombination der Aktivitäten, damit eine Auszeit auch nachhaltig und langanhaltend wirkt. Hauptbestandteil ist der Aufenthalt in der Natur, dazu Entspannungstechniken und Bewegungseinheiten und Ruhephasen. Als besonders wirksam hat sich das Bad Reichenhaller Naturheilmittel AlpenSole erwiesen – es wird für Bäder, Inhalationen und weitere entspannende Behandlungen erfolgreich eingesetzt.
Aktive Auszeit in der Alpenstadt
Ein Ortswechsel ist für eine erfolgreiche Auszeit entscheidend und deshalb besonders empfehlenswert. Bad Reichenhall als renommierte Kurstadt bietet Erholungssuchenden besten Service, Know-How und Qualität.

Weitere Infos gibt es unter: www.bad-reichenhall.de

kann leichtes Stretching beinhalten – intensivere Dehnung ist allerdings erst am Folgetag sinnvoll, beispielsweise in Form einer Yoga-Session. Direkt nach dem Training ist zudem auf eine erhöhte Flüssigkeitszufuhr zu achten, beispielsweise mit magnesium- und natriumreichem Mineralwasser. Denn über den Schweiß verliert der Körper nicht nur Flüssigkeit, sondern auch wichtige Vitamine, Spurenelemente und Mineralstoffe. Insbesondere die Elektrolyte Kalium, Natrium, Magnesium, Kalzium und Chlorid haben eine große Bedeutung für den Muskelstoffwechsel. Bei schweißtreibender sportlicher Belastung ist eine leistungsgerechte Elektrolytversorgung, beispielsweise mit elektrolytehaltigen Getränken, angeraten.


Auch der Ernährung kommt nach körperlicher Belastung eine bedeutsame Rolle zu. Komplexe Kohlenhydrate füllen die Energiespeicher wieder auf. Proteine, wie in Fleisch, Eiern oder Milchprodukten, sowie Omega-3-Fettsäuren fördern das Muskelwachstum.

Ausserdem sollte auf ausreichend Schlaf geachtet werden zur Regeneration nach sportlicher Belastung. Darüber hinaus beschleunigen Entspannungsbäder die
Regeneration der Muskeln, ebenso wie Massagen. Spaziergänge an der frischen Luft am Folgetag der Sporteinheit regen ebenfalls die Regeneration des Körpers an. Genauso wie entspanntes Radfahren oder leichtes Walking. Auf diese Weise wird zudem Muskelkater vorgebeugt.
Ist man erst einmal dabei, ist kontinuierliches Training wichtig – mindestens drei Sporteinheiten pro Woche werden empfohlen.
23 FAMILIENGESUNDHEIT Eine unabhängige Kampagne von Contentway ADVERTORIAL
All you need is...

Die 3 Tages Saftkur ist der Klassiker der Kur-Varianten! Der kurze Zeitraum ist gut durchzuhalten und leicht in jeden Alltag integrierbar. Mit sechs leckeren kaltgepressten Säften pro Tag eignet sich die Kur perfekt für alle Fasten-Anfänger und bereits Geübte.
UVP: 89,00 EUR www.thefrankjuice.com

...kleine Helfer für den Alltag. Egal in welcher Lebenslage, der Alltag kann oft herausfordernd sein – sowohl für Eltern als auch für die Kinder. Diese sieben Produkte unterstützen Sie, tragen zum Wohlbefi nden bei und lassen Sie strahlen.
Federwiegen Komplettset von HOBEA-Germany. Vollautomatische Wiege aus Baumwolle mit klappbarem Ständer plus individuell einstellbarem Motor. So finden Babys sanft zur Beruhigung.

UVP: 499 EUR www.hobea.de






Pflanzliche Extrakte im Mama Cooling Gel von Womatics tragen zur Pflege schmerzender und geschwollener Brüste bei. Seine angenehm kühlende Wirkung beruhigt die strapazierte Brust und verhilft Müttern zu einer unbeschwerten Stillzeit.

UVP: 15,90 EUR www.womatics.de


Die vegane Hand- und Körperseife von Jean&Len im nachfüllbaren Glasspender sieht edel aus, duftet angenehm würzig nach Ingwer und Rosmarin und ist frei von Mikroplastik, Parabenen und Silikonen.
UVP für 500 ml: 11,98 EUR www.jeanlen.de

HERA organics Menstruationsschwämme: Die 100% natürliche & nachhaltige Alternative zu herkömmlichen Periodenprodukten. Das Zero Waste Produkt ist frei von Plastik & Schadstoffen und wiederverwendbar.
UVP: 25,90 EUR für DIE WELT Leserinnen speziell 21,90 EUR www.hera-organics.com



IM HOME-SPA WIRD DIE WANNE ZUM SOFA!
Duftkerze, gute Musik im Ohr, Schaum bis zur Nasenspitze: Fürs Abtauchen vom Alltagsstress braucht es oft nicht viel. Doch kaum liegt man im Wasser, wird‘s schnell unbequem: Man rutscht, sucht Halt, verkrampft. Wer kennt’s nicht? Mit dem Kissen von BADESOFA gelingt Entspannung ohne Kompromisse.
„Zurücklehnen, durchatmen und genießen“ leichter gesagt als getan. Denn viele stylische Wannen sind vielleicht optische Hingucker, aber in der Praxis mehr als ungemütlich. Höchste Zeit also, diese unbequeme Wahrheit zu hinterfragen!
Denn Erholung ist der Schlüssel zu mehr Energie.
MEHR KOMFORT BITTE!
Wahre Wellness-Wonnen bringt das BADESOFA: Ein innovatives

High-Tech-Kissen, das den Nackenbereich ergonomisch und angenehm stützt - ohne dass der Kopf unter Wasser sinkt.
STILVOLL ENTSPANNEN
BADESOFA ist kinderleicht im Pflege-Handling und ohne Aufwand einsatzbereit. Spontan, zuhause, jederzeit. Dank Magic-Dry-Funktion hat Staunässe keine Chance.

BADESOFA-Produkte sind zu 100 Prozent „made in Europe“ und bringen neben Qualität und Funktion auch ein ausgeprägtes ästhetisches Design mit, für das sie bereits mit dem Red Dot Design Award [2021] ausgezeichnet wurden.
SELFCARE IST TREND




Mehr über die Revolution des Selfcare- und Wellness-Erlebnisses zu Hause unter www.badesofa.de
Ardo Alyssa Double – Elektrische Doppelmilchpumpe Einfach zu bedienen, klein und handlich, für e�zientes und sicheres Abpumpen. Weltneuheit: Mit automatischer Power Pumping Funktion.
UVP: 179,99 EUR www.ardo.de








Leistungsstark, spielerisch und individuell – die Smartwatch X6 Play von Xplora bietet mit vielseitigen Funktionen und dem personalisierten Mix & Match-Konzept einen sicheren Einstieg in die digitale Welt.
UVP: 199 EUR www.myxplora.de

ANZEIGE – ADVERTORIAL

FAMILIENGESUNDHEIT Eine unabhängige Kampagne von Contentway 24
Outdoor-Sport mit Kindern

bewegung
Was gibt es Schöneres, als sich gemeinsam mit der Familie auszupowern? Diese Erwachsenen-Sportarten machen auch Kindern Spaß.
Schon 20 Minuten in der Natur verbessern die Laune: Vitamin D tanken, Stress abbauen, Immunsystem stärken. Und los geht’s!
Gute Schuhe und eine angenehme Strecke, mehr braucht es nicht für die Klassiker der einfachen Sportarten –Joggen und Wandern. Gemeinsam mit den Eltern können Kinder ab 5 Jahren joggen, eine Strecke von maximal 1,5 km ist für die Kleinen genug. Ab 8 Jahren dürfen es auch etwas größere Distanzen sein. Der Spaß soll natürlich immer im Vordergrund zu stehen. „Laufen ohne Schnaufen“ gilt für Kinder genauso wie für Erwachsene. Gar nicht langweilig ist der Wanderausflug mit der Familie, wenn er zum Geländelauf und Hindernisparcours wird, indem Baumstämme überklettert, ein Bach übersprungen oder Berghänge erklommen werden
müssen. Oder bei der modernen Form der Schatzsuche mittels GPS-Daten „Geocaches“ gefunden werden müssen –kleine Schätze, die in Baumhöhlen, unter Büschen oder anderswo versteckt sind und meist ein Logbuch oder Gegenstände zum Tauschen enthalten.
Gemeinsam um den See skaten oder ab auf die Rollschuhbahn. Beim Inlinefahren kommen alle in Schwung! Die Funsportart trainiert Gleichgewichtssinn, Körperbeherrschung und Kondition gleichermaßen. Bevor es richtig losgeht, sollten Kinder ab 6 Jahren die Grundtechniken des Fahrens, Bremsens und auch des richtigen Fallens erlernen –Helm und Protektoren sind dabei immer mit von der Partie.
Vorhand, Rückhand, Volley, Aufschlag: Der Klassiker unter den Rückschlagsportarten ist Tennis. Empfohlen für Kinder ab 5 bis 7 Jahren ist Tennis ein Sport, bei dem sich bei Anfängern und Fortgeschrittenen schnell Erfolgserlebnisse einstellen. Bevor es auf den Platz geht, genügen auch ein Softball und das Garagentor zum Üben. Um Schnelligkeit, Koordination und Reaktionsvermögen geht es auch beim Tischtennis. Häufi g
sind in Parks oder Spielplätzen Tischtennisplatten zur kostenlosen Nutzung zu fi nden. Kinder ab 8 Jahren können sich an unterschiedlichen Schlagtechniken ausprobieren. Und beim Rundlauf kommen auch die Eltern ins Schwitzen. Kinder springen Seil, Erwachsene hüpfen beim Rope Skipping. Seilspringen eignet sich für Kinder ab 5 Jahren. Das Springen mit verschiedenen Seilen und Sprungarten sorgt für Kraft in den Beinen, das Herz-Kreislauf-System wird angeregt und die Erwachsenen verbrennen eine Menge Kalorien. Unkompliziert, auch für die Kleinsten sind Federballspiele – ohne Schläger. Der kleine Federball fl iegt durch die Federn immer weit und weich, auch wenn noch nicht so viel Schwung in den Armen da ist. Werfen und Zielen werden so trotzdem schon trainiert.
Nun aber zur Entspannung: Yoga steigert auch bei Kindern das seelische, geistige und körperliche Wohlbefi nden. Und das mal ohne Wettkampfgedanken: Spezielle Übungsformen, auf jede Altersstufe abgestimmt, sind ein guter Ausgleich zum Schulalltag und entspannende Ergänzung zu anderen Sportarten.
Von der ausgerollten Yoga-Matte in die Bäume und auf vorbeiziehende Wolkenformationen zu blicken und das intensive Wahrnehmen von Natur und Jahreszeit unterstützen die innere Ausgeglichenheit. Natürlich lassen sich viele OutdoorSportarten auch im Herbst und Winter verfolgen. Mit der richtigen Kleidung gibt es keine Ausreden mehr!
fakten
Bewegung ist für die gesunde Entwicklung von Kindern von großer Bedeutung. Experten empfehlen für Heranwachsende mindestens 60 Minuten körperliche Aktivität mittlerer Intensität pro Tag. Der Fokus sollte aber immer auf dem Spaß an der Bewegung liegen und diese auch ohne elterlichen Zwang gern ausgeübt werden.
25 FAMILIENGESUNDHEIT Eine unabhängige Kampagne von Contentway
Text: Julia Butz
Foto: Morgan David de Lossy/unsplash
„Laufen ohne Schnaufen“ gilt für Kinder wie für Erwachsene.
Gar nicht langweilig ist der Wanderausfl ug mit der Familie, wenn er zum Geländelauf und Hindernisparcours wird.
Kickstart zur Selbstfindung
entwicklung
Ein Coaching stößt die Selbstreflexion an und unterstützt bei der Potenzialentfaltung und Umsetzung konkreter persönlicher oder berufl icher Ziele.
Text: Kirsten Schwieger
Foto: Shvets Production/pexels
Ob berufl iche oder private Neuorientierung, einschneidende Lebensereignisse oder gar eine ausgewachsene Sinnkrise: Es gibt Situationen im Leben, in denen man am Ende seines Lateins ist und den Wald vor lauter Bäumen nicht mehr sieht. In solchen Lebenssituationen kann ein Life- oder Business-Coach professionelle Unterstützung bieten. Mit geschultem Blick von außen begleitet er die Klienten in ihrem Selbstfi ndungsprozess und hilft, eigene
Antworten und Lösungen zu fi nden. Coaches unterstützen ihre Klienten dabei, zu erkennen, wo sie im Moment stehen und eine Vision zu entwickeln, wo sie hinwollen – inklusive konkretem Plan, dorthin zu gelangen.
Coaching bedeutet motivationale Klärung, aktive Problembewältigung und Ressourcenaktivierung. Ein Prozess, der Werkzeuge zu Potenzialentfaltung und nachhaltiger Veränderung in einem oder mehreren Lebensbereichen liefert. Sei es berufl iche Selbstverwirklichung, Partnerschaft, Finanzen, Gesundheit oder Spiritualität. Häufi g kommen dabei Themen wie Selbstwert, Selbstbewusstsein, Entscheidungsfähigkeit aber auch Wertekonfl ikte und Zeitmanagement auf den Tisch. Und die Einsicht, dass eigene Fähigkeiten oft unterschätzt und Probleme überschätzt werden.
Insbesondere Frauen profitieren von Lebens- wie Business-Coaching – in Zeiten, in denen Männer immer noch das Gros

der Führungspositionen innehaben oder in vergleichbaren Jobs ein höheres Gehalt einstreichen. Nicht selten reiben sich Frauen zwischen Familie und schlecht bezahlten Teilzeit-Jobs auf und stellen ihre persönliche Erfüllung hinten an. So spielt im Frauencoaching häufi g die Auseinandersetzung mit geschlechterspezifischen Problemen sowie gesellschaftlichen Einflüssen eine zentrale Rolle. Frauen nutzen Coaching-Angebote verstärkt, um Themen wie Vereinbarkeit von Karriere und Familie aber auch Führen in Teilzeitmodellen zu klären. Auch die berufl iche Neuorientierung steht bei Frauen hoch im Kurs. Frauencoaching stärkt die Selbstsicherheit und das Vertrauen in die eigenen Fähigkeiten.
Coaching ist immer Hilfe zur Selbsthilfe. Es dient dazu, persönliche Ziele zu definieren und das Potential für Kraft und Selbstbewusstsein freizusetzen. Dabei werden keine fertigen Lösungsvorschläge präsentiert, sondern Ressourcen zur eigenen Lösungsfi ndung mobilisiert. Durch
personenzentrierte Gesprächsführung mit gezielten Fragen und anschließendem Zusammenfassen wird die Selbstreflexion der Klienten verbessert und eine klarere Sicht auf individuelle Stärken, Schwächen, Ziele und Bedürfnisse geschaffen. Ein Coach unterstützt bei der Erkennung und Lösung von Blockaden und Problemen und fördert die Entstehung von Lösungen. Er gibt wichtiges Feedback zu persönlichem Verhalten und Selbstbildern um am Ende des Coaching-Prozesses den Klienten zu klaren Prioritäten und konkreten Zielen für die persönliche Weiterentwicklung zu befähigen.
Finanzielle Förderung
Unter bestimmten Voraussetzungen fördern Jobcenter beziehungsweise die Agentur für Arbeit mit einem Aktivierungs- und Vermittlungsgutschein (AVGS-Gutschein) ein berufl iches Coaching in vollem Umfang.
FAMILIENGESUNDHEIT Eine unabhängige Kampagne von Contentway 26
Coaching ist immer Hilfe zur Selbsthilfe.
Coaching ist immer Hilfe zur Selbsthilfe. Es dient dazu, persönliche Ziele zu definieren und das Potenzial für Kraft und Selbstbewusstsein freizusetzen.
Impulse in Espressolänge®
Impulse in Espressolänge®
DIE LIFE COACH AUSBILDUNG (IiE® - CA)
Impulse in Espressolänge®


DIE LIFE COACH AUSBILDUNG (IiE® - CA)
DIE LIFE COACH AUSBILDUNG (IiE® - CA)





UNSER AUSBILDUNGSPROGRAMM ZUM LIFE –UND IMPULS – COACH „ALLES. WIRKT.“®















Als zertifizierter Life Coach (IiE®-CA) unterstützt du Menschen in den unterschiedlichsten Lebensbereichen, der Mensch mit seinen Zielen & Wünschen steht im Mittelpunkt. Er ist der gemeinsame Nenner und hat die Lösung bereits in sich.




Du begleitest ihn „nur“ dahin, diese zu finden und Erlaubnis zu geben, authentisch und von Herzen zu leben.


#alleswirkt
Ganz nach dem Motto „Lebensfroh. Rockt.“ widmet sich diese Life Coach Ausbildung ganz speziell dem Leben in all seinen Facetten, Formen und Farben, der Freude daran und natürlich dem Menschen darin.
#lebensfrohrockt
SELBSTERFAHRUNG, ERLEBEN & TUN
Eine Ausbildung zum Machen und Erleben. Eine Ausbildung, in der du sowohl an dir arbeitest, als auch mit Menschen in Beziehung gehst.
Es ist die Ausbildung für Herz und Hirn.
Du bekommst an die Hand, was funktioniert, testest es, gibst dem Ganzen deine Farbe und trainierst den Mut, das auch auszuprobieren
Du lernst dir zu vertrauen und auf dein Herz zu hören und andere dabei zu begleiten, dasselbe zu tun. Es ist die Ausbildung für Menschen. Es ist die Ausbildung für dich. #mehrmachen
Start SOMMER: 13. Juni 2023
Start HERBST: 19. September 2023 2023











Zentrum für Lebensfreude
Zentrum für Lebensfreude
a bit of color & FRIENDS GmbH
a bit of color & FRIENDS GmbH
Tel.+49(0)941 206 035 10
Tel.+49(0)941 206 035 10
Mail: info@abitofcolor.de
Mail: info@abitofcolor.de
Zentrum für Lebensfreude
WWW.ABITOFCOLOR.DE
a bit of color & FRIENDS GmbH
WWW.ABITOFCOLOR.DE
Tel.+49(0)941 206 035 10













Fotos: Petra Homeier
Fotos: Petra Homeier
Mail: info@abitofcolor.de


WWW.ABITOFCOLOR.DE



Fotos: Petra Homeier

Nachhaltig essen in der Zukunft
einleitung

Wie werden wir in Zukunft essen? Zwei der großen Trends auf dem Lebensmittelmarkt sind Nachhaltigkeit und Gesundheitsorientierung



Foto: Sandra Ritschel/Lebensmittelverband
Flexitarische Ernährung, also eine Mischung aus vegetarischer Lebensweise verbunden mit dem bewussten Konsum von Fleisch und Fisch ist dabei ein wesentlicher Aspekt. Viele Deutsche haben ihren Fleischkonsum reduziert und die Fleischproduktion ist hierzulande 2022 das sechste Jahr in Folge zurückgegangen, wie das Statistische Bundesamt im Februar mitteilte. Auch wenn Importe von Fleisch in diesen Zahlen nicht berücksichtigt werden, so ist der Trend dennoch nicht von der Hand zu weisen: Die Produktion sank um 8,1 Prozent auf sieben Millionen Tonnen. Die Lebensmittelbranche erkennt solche Veränderungen und versucht, frühzeitig darauf zu reagieren, denn sie möchte den Menschen ermöglichen, nach ihren individuellen Vorstellungen zu leben. Deshalb boomt seit Jahren der Markt der Fleischalternativen. Sie sollen vegetarisch und vegan lebenden Menschen eine ebenso große Produktauswahl ermöglichen, wie sie Menschen haben, die tierische Produkte essen. Dabei gibt es nicht die eine „Ersatz-Ressource“, sondern es kommt darauf an, die Vielfalt zu nutzen, die wir an möglichen Rohstoffen zur Verfügung haben wie Hülsenfrüchte, Pilze, Reis, Hafer, Soja und viele mehr. Nur so erhalten wir Biodiversität und können vielfältige Geschmackserlebnisse anbieten. Das gilt auch für andere, neuartige Proteinquellen wie Insekten und Algen. Insekten beispielsweise sind zwar mit mehr als 50 Gramm pro 100 Gramm sehr proteinreich, aber eben nicht für

Vegetarier oder Veganer geeignet. Algen hingegen sind pflanzlich und haben den Vorteil, dass sie auch reich an essenziellen Fettsäuren – den Omega-3-Fettsäuren – sind. Das zeigt, dass wir variationsreich bleiben müssen, um eine optimale Versorgung für alle Lebensstile zu gewährleisten.

Mit Blick auf die wachsende Weltbevölkerung müssen wir zudem nicht nur offen sein für neue Technologien wie Rohstoffe, die in Bioreaktoren wachsen oder Rohstoffe, die mit neuen Züchtungstechnologien angebaut werden. Wir müssen vor allem so ressourcenschonend wie möglich arbeiten und dazu gehört vermeidbare Lebensmittelverluste weitestgehend zu reduzieren. Zuerst versucht man, dass solche Verluste und Abfälle gar nicht erst entstehen. Und wo das nicht geht, werden diese dann zumindest abgegeben, damit sie nicht im Müll landen, zum Beispiel je nachdem an welchem Punkt der Wertschöpfungskette man sich befindet als Tiernahrung oder als Spende an eine der 950 Tafeln in ganz Deutschland, die damit wiederum über 1,6 Millionen Bedürftige versorgen. „Auf Null“ kann man vermeidbare Lebensmittelabfälle übrigens nie setzen, denn Sicherheit und Qualität gehen immer vor. Das heißt, es wird immer auch Warenrückrufe zum Schutz der Gesundheit der Verbraucher geben, möglicherweise auch von Lebensmitteln, die gesundheitlich unbedenklich sind. Außerdem ist die Aufklärungsarbeit gegenüber den Verbrauchern von essenzieller Bedeutung. Denn nach wie vor werfen Privathaushalte zu viel Essen weg. Durch bewusstes Einkaufen, richtiges Lagern und den richtigen Umgang mit dem Mindesthaltbarkeitsdatum könnte dem Vorschub geleistet werden.
René Püchner, Präsident Lebensmittelverband Deutschland e. V.
Besonders nachhaltig dank Karton-Manschette

LEBENSMITTEL Eine unabhängige Kampagne von Contentway 28
Bester Geschmack für jeden Geschmack.
„Wir müssen vor allem so ressourcenschonend wie möglich arbeiten und dazu gehört vermeidbare Lebensmittelverluste weitestgehend zu reduzieren.“
Innovative Art, Quark zu genießen Alle Produkte ohne Palmöl www.moevenpick-finefood.com ANZEIGE
„Nachts entstehen die besten Ideen.“
einblick
Wie wichtig ist die Clubkultur? Ein Interview mit Dimitri Hegemann, dem Gründer des Berliner Clubs „Tresor“ und eine der Größen der Clubkultur.
Text: Julia Butz

Foto: Marie Staggat
Warum ist Clubkultur so wichtig?
Eine spezifi sche Clubkultur steht für einzelne Gruppen und somit auch für einen Raum, der sich für diese einzelnen Gruppen zum Schutzraum entwickelt hat und an dem sie ihre Persönlichkeit ausleben können. Dies ist besonders im Hinblick auf Menschen wichtig, die nicht den Idealen unserer Mehrheitsgesellschaft entsprechen. Im Idealfall ist ein Club also ein Ort, in dem sich Angehörige marginalisierter Gruppen ungestört bewegen können. Genau dies spiegelt auch die Anstrengungen von Politik und Gesellschaft wider, mit denen wir es aktuell so stark zu tun haben: Inklusion, Diversität, Vielfalt und Gleichstellung zu fördern und dazu entsprechende Konzepte auch in die Tat umzusetzen.
Wie sieht denn eine ideale Clubkultur aus?
Um dies einmal deutlich zu machen: Es geht nicht darum, ab und an mal ein z. B. konventionelles Rockkonzert zu hören
oder einen Drink in einer Bar zu nehmen. Es geht darum, diejenigen anzusprechen und einzubinden, die andere Wege suchen. Clubs sind nicht einfach eine Vergnügungsstätte wie eine Diskothek…
Sondern?
…ambitionierte Kulturorte mit einem gut kuratierten Programm. Es geht um verschiedene Szenen, um neue Entdeckungen in der Musik oder den Umgang mit einem ganz besonderen spezialisierten musikalischen Angebot. Um eine Art kultureller Qualität, sie sich nicht vordergründig an Gewinnmaximierung orientiert. Clubs dienen als Orte einer sozialen Identifi kation der Orientierung und fördern den Zusammenhalt von verschiedenen sozialen Gruppen. Ein Club gehört zur Avantgarde einer modernen zeitgenössische Subkultur und es wird Zeit dieser Realität und dieses Wertes Rechnung zu tragen. Und ihm entsprechend in Deutschland ausreichend Platz einzuräumen.
Woran mangelt es?
Zum einen brauchen wir im ganz wörtlichen Sinne freie Räume. Freizeit- und Kreativräume, die abseits von Kommerz liegen, die mit Perspektive und Angeboten gefüllt werden, an denen junge Menschen sich mit ihrer Lebenswirklichkeit beschäf-
tigen und ihren Vorlieben und Interessen nachgehen können. Und natürlich die Macherinnen und Macher aktivieren, die tatsächlich schon in der jeweiligen Stadt leben, sie warten alle… Junge Menschen brauchen Freiräume, um kreativ zu sein. Diese fehlende Infrastruktur ist neben mangelnder berufl icher Perspektive oftmals mit dafür verantwortlich, dass es zu drastischer Abwanderung vor allem in den strukturschwächeren Regionen kommt. Was im Übrigen nicht nur ein Problem in Deutschland, sondern auch allgemein für Europa oder andere Teile der Erde gilt.
Warum gelingt dies insbesondere in Berlin in diesem hohen Maße?
Berlin ist ein Extrembeispiel, denn die gesamte Stadt war nach dem Mauerfall so ein freier Raum. Menschen mit dem Potenzial und dem Drang, etwas Neues zu erschaffen, fanden in den vielen leerstehenden Gebäuden ihre ganz eigenen freien Räume, um sich auszuprobieren und entfalten zu können. Nicht zu vergessen, der sehr niedrige ökonomischen Druck und eine Toleranz seitens der Behörden. Inzwischen ist die Berliner Clubkultur von so herausragender kultureller Bedeutung, dass sie sich zu einem der wichtigsten Wirtschaftsfaktoren der Stadt entwickelt hat.
JÄGERMEISTER – PARTNER CONTENT


Lesen Sie das ganze Interview online auf: contentway.de
fakten
Dimitri Hegemann ist Kulturschaff ender und Raumforscher und beschäftigt sich gerne mit Dingen, die anders sind. 2012 gründete er mit Annette Ochs die Beratungsagentur „Happy Locals“, die in kleineren Städten Kulturangebote entwickelt, um der Bevölkerungsabwanderung entgegenzuwirken.

Initiative zum Erhalt der Nachtkultur
Nicht nur reden, sondern auch machen. Für den Erhalt und die Verbesserung der Nachtkultur sind innovative Ideen gefragt.
Weltweit stehen die Akteure der Nachtkultur nicht nur durch die Folgen der Pandemie vor gewaltigen Herausforderungen: Einerseits die globale Krise mit den immens gestiegenen Kosten, teilweise prekären Jobverhältnissen und immer weniger Personal. Andererseits fordert der gesellschaft liche Wandel, das Nachtleben diverser und inklusiver zu gestalten, gegen alte Mechanismen diskriminierender Clubkultur anzugehen und ein echter Safe Space für alle Gäste und Künstler zu sein. Durch diese weitreichenden Folgen ökonomischer, kultureller und sozialer Natur steht nicht nur die Existenz von Clubs auf dem Spiel. Vielmehr geht es seit dem Re-Start als globales Thema darum, die Nachtkultur weiterzuentwickeln, zu verbessern oder sogar grundlegend umzugestalten.
Kräuterlikörhersteller Jägermeister setzt sich als etablierter Partner der NightlifeSzene mit seinem Purpose „Best Nights of your life – today and tomorrow“ dafür ein, Menschen die besten Nächte ihres Lebens zu bereiten. Dazu gehört es auch,
MAST-JÄGERMEISTER SE
den Erhalt des Nachtlebens weltweit und nachhaltig zu unterstützen und über die Partynacht hinaus für die drängenden Themen Inklusion, Sicherheit und Vielfalt unterschiedlichster Lebensentwürfe einzustehen und zu sensibilisieren. Deswegen wurde 2020 #SavetheNight initiiert. Das Projekt hat sich seither zu einer globalen Plattform entwickelt, die sich für den Erhalt von Kulturgütern und den Schutz der Vielfalt im Nachtleben einsetzt.
Dazu Kai Dechsling, Head of Global Culture & Experiential Marketing bei der Mast-Jägermeister SE: „Gerade in diesen unbeständigen Zeiten sehnen sich Menschen nach Orten, die ihnen eine Flucht aus dem Alltag und gleichzeitig Sicherheit bieten. Im Nachtleben haben sie die Mög-
lichkeit, sie selbst zu sein. Leider nicht immer und überall auf der Welt. Wir wollen unseren Beitrag leisten, das zu ändern.“
Eine von vielen #SavetheNight-Maßnahmen ist der globale Fund, der 2022 erstmals ausgelobt wurde. Gesucht wurden innovative Projektideen, die das Potenzial haben, das Nachtleben positiv zu beeinflussen. In diesem Sommer folgt ein zweiter, weltweiter Aufruf für kreative Ideen zu Erhalt, Förderung und Verbesserung des Nachtlebens.

Bis heute hat Jägermeister mit #SavetheNight bereits mehr als 1.500 Kreative und 1.200 Projekte in über 60 Ländern unterstützt. Neben der Finanzierung geht es in erster Linie darum, Strukturen zu verän-
Das auff ällige Logo ist eine Anlehnung an die Sage vom Heiligen Hubertus. Einst ein wilder, rücksichtsloser Jäger, erschien Hubertus eines Tages im Wald ein mächtiger Hirsch mit einem strahlenden Kreuz zwischen seinem Geweih. www.save-the-night.com
Kai Dechsling, Director Global Culture & Experiential Marketing bei Mast-Jägermeister SE

dern, anzustoßen und langfristig echten Impact zu schaffen. Und die Kraft der Marke und kollektive Intelligenz dafür zu nutzen, Lösungen und echte Perspektiven zu fi nden. „Wir kreieren gemeinsam mit Kulturtreibern und der kreativen Szene die vielfältigsten Projekte. In den USA haben wir zum Beispiel mit dem Lesbian Bar Project Aufmerksamkeit und Spenden generiert, um die letzten verbliebenen Bars für die lesbische Community zu erhalten“, so Dechsling.
Neben dem #SavetheNight Fund plant das Team um Dechsling gemeinsam mit Partnern in aller Welt auch in diesem Jahr zahlreiche Maßnahmen rund um den Globus.
29 LEBENSMITTEL Eine unabhängige Kampagne von Contentway
Dimitri Hegemann, Gründer des Berliner Clubs „Tresor“
Foto:Presse
Tee ist immer ein Genuss




























































































teezeit






Ob anregend oder beruhigend, würzig, mild oder erfrischend – Tee ist gut fürs Gemüt , und gut für die Gesundheit. Frank Schübel, Vorsitzender des Deutschen Teeverbandes, erzählt, warum besonders „KonzeptTees“ boomen


Text: Katja Deutsch
Fotos: Massimo Rinaldi/unsplash Presse

Herr Schübel, welche Sorten Tee sind am beliebtesten?

Es gibt nicht den einen Lieblingstee, die Verbraucher genießen je nach Anlass und Gemütslage völlig unterschiedliche Dinge: Oft morgens schwarzen Tee, nachmittags Kräutertee und abends noch einen Früchtetee. Vom Anteil her sind Kräuter- und Früchtetee mit 68 Prozent am beliebtesten, Schwarztee liegt bei 24 Prozent und Grüntee bei acht Prozent. Wir haben über 400 Sorten in den Regalen unserer Märkte und exportieren in 108 Länder. Aufgrund der sehr strengen Gesetze in Deutschland haben wir sehr guten Tee und deshalb weltweit einen sehr guten Ruf.
Woher stammt der Großteil unseres Te es?


48 Prozent der Rohwaren stammen aus China, etwa 20 Prozent aus Indien. In Uganda und Ruanda wird eine staatlich geförderte Teeindustrie aufgebaut – mit gut ausgebildeten Landwirten auf ganz hervorragenden Böden, die noch nie ein Pestizid gesehen haben. Beide Länder sehen ihre Chance bei Premiumund Bioqualität. Auch Kenia bietet hervorragende Qualitäten.

Wie wird er angebaut, geerntet und behandelt?


In bestimmten Regionen im Regenwald kann man kontinuierlich das ganze
Jahr ernten, weil man immer nur die oberen Blätter und Knospen der Pflanze verarbeitet. In anderen Regionen wie Darjeeling ruht die Pflanze für mehrere Monate, bis man ab April, abhängig von Mondphase und Wetterlage, den First Flush erntet. Grundsätzlich wird Tee fast immer von Hand gepflückt, um die Pflanze nicht zu zerstören. Die Pflanzen werden frisch geerntet, gepflückt, sofort in eine bestimmte Größe vorgeschnitten und vor Ort getrocknet, anschließend gehandelt und in den verarbeitenden Betrieben weiter veredelt.




Woran erkennt man hochwertigen Tee?
Man erkennt ihn nicht an der Schnittgröße! Kleingeschnittene Teeblätter
im Teebeutel sind nicht weniger gut als großblättriger, loser Tee. Doch die Frage ist schwer zu beantworten. Ich würde sagen, man erkennt ihn am Geschmack. Zunehmende Bedeutung haben die Laborwerte, also die Belastung mit Pestiziden und Kontaminanten. Die Höhe möglicher Pestizide hängt vom jeweiligen Teegarten ab. Ein konventioneller Teegarten braucht mindestens drei Jahre, bis sich sein Boden erholt hat, um Bio-Qualität zu produzieren.

Wohin bewegt sich geschmacklich der aktuelle Teetrend?
Das Segment der komplexen Konzept-Tees, also Kräuterteemischungen mit Funktion und emotionalem Versprechen, wie zum Beispiel „schlaf gut“
und „entspann dich“ wächst sehr stark. Die Wertschätzung für komplexere Geschmäcker steigt, denn Tee wird als einfaches Mittel gesehen, sich und seiner Gesundheit etwas Gutes zu tun.

















LEBENSMITTEL Eine unabhängige Kampagne von Contentway 30
ANZEIGE
Die feinen Partikel im Teebeutel entfalten ihr Aroma zumeist schneller. Loser Tee sollte während der Ziehzeit möglichst frei schwimmen.
Probier´nen
Tee-Latte
NEU! Ab April im Kühlregal
Frank Schübel, CEO von Teekanne und Vorsitzender des Deutschen Teeverbands
neuen
von Mix!Meßmer.
Wenn der kleine Hunger zwischendurch kommt
gesunde snacks Chips und Co. sind beliebte Snacks, aber sehr ungesund. Doch es gibt gesunde Alternativen wie Nüsse, Popcorn, Trockenfrüchte oder Gemüsesticks.
Text: Armin Fuhrer Foto: No Revisions/unsplash
Wer kennt das nicht: Man liegt auf dem Sofa, schaut einen spannenden Film oder arbeitet gerade angestrengt an einem Projekt und greift fast schon automatisch in die offene Chipstüte oder nimmt sich einen Riegel Schokolade. Später ärgert man sich dann – schon wieder konnte man der Versuchung nicht widerstehen und hat eine Menge unnötiger Kalorien und ungesunder Stoffe zu sich genommen. Kartoffelchips enthalten sehr viele Kohlenhydrate und Fette. Zudem wird die empfohlene Menge an Salz von sechs Gramm pro Tag mit dem Verzehr von einer Tüte deutlich überschritten. Das fördert Herz-Kreislauf-Krankheiten und Bluthochdruck. Auch Schokolade enthält viel Fett und Zucker.
Besser ist also, die Finger wegzulassen von der Chipstüte oder dem Schokoladenriegel. Auf den Snack muss man deshalb aber nicht verzichten, denn es gibt Alternativen, die ebenfalls lecker sind, aber die Gesundheit nicht schädigen, sondern ganz im Gegenteil fördern. Allen voran: Nüsse. Wenn der kleine Hunger zwischendurch kommt oder der große Heißhunger auf eine Knabberei, sollten Nüsse die erste Wahl sein. Sie haben zwar ebenfalls einen hohen Fettanteil, aber dabei handelt es sich um ungesättigte Fettsäuren. Und die machen nicht dick, sondern sind gesund und helfen sogar beim Abnehmen. Das gilt für alle Nüsse aus dem Super- oder Biomarkt, also zum Beispiel für Haselnüsse, Cashewkerne, Macadamia, Mandeln oder Pistazien.
Viele Nusssorten haben allerdings einen Nachteil: Ihr Anbau ist nicht ökologisch nachhaltig und sie müssen oft einen weiten Weg bis in die heimische Snackschale zurücklegen, weil sie nicht in Deutschland wachsen. Daher sind hierzulande wachsende Nüsse am nachhaltigsten – Haselnüsse, Walnüsse und Maronen zum Beispiel.
Popcorn hat bei vielen den Ruf, ein ungesunder Snack zu sein, den man sich bestenfalls mal im Kino leistet. Doch das Gegenteil ist der Fall – Popcorn ist sogar ziemlich gesund. Allerdings nur dann,
Trockenfrüchte stellen einen süßen, leckeren Snack dar, der gesund ist und zumindest zum Teil aus der heimischen Region kommt.
wenn man darauf verzichtet, ihn in der gezuckerten Variante zu verzehren, ihn nicht mit zu viel Salz bestreut oder in Butter ertränkt. Popcorn besteht nämlich aus Mais und der quellt nach dem Verzehr im Magen auf, hat viele Ballaststoffe und sorgt für ein Sättigungsgefühl. Er kann leicht zuhause hergestellt werden. Allerdings hat auch Popcorn ein Problem mit der Nachhaltigkeit, denn der Mais kommt für gewöhnlich aus den USA und China.
Gerne genommen werden auch Trockenfrüchte. Sie stellen einen süßen, leckeren Snack dar, der gesund ist und zumindest zum Teil aus der heimischen Region kommt. Aber Achtung: Weil Trockenfrüchten das Wasser entzogen wurde, weisen sie einen erheblich höheren Anteil an (Frucht-)Zucker auf – und haben daher ordentlich Kalorien intus.
Zweifellos nicht nach dem Geschmack eines oder einer jeden, aber dafür super-
Wo das Besondere im Ursprung liegt
Nüsse und Früchte transparent in die Tüte zu bringen, den Anbau im Ursprung zu begleiten und zu gestalten – dafür steht Farmer‘s Snack.
Die fruchtige Frühstücks-Bowl oder kerniges Porridge schmecken umso besser, wenn naturbelassene Zutaten darin landen. Nüsse gehören dazu, denn sie enthalten viele wertvolle Inhaltsstoffe, liefern Proteine und sind reich an guten Fetten. Trockenfrüchte punkten mit Ballaststoffen und Mineralien. Dass viel Gutes darin steckt, ist den meisten Verbraucher:innen bewusst – zurecht wollen aber viele wissen, woher die knackigen Kerne und leckeren Früchte stammen. Wo werden sie angebaut und was macht ihren Ursprung aus?
Wissen, wo die Rohware herkommt Farmer‘s Snack, Hersteller hochwertiger Nusskerne und Trockenfrüchte aus dem niedersächsischen
Seevetal, ist es wichtig, Antworten auf diese Fragen zu liefern. Mallorca Mandeln, Ananasringe aus Südafrika oder Kokos-Chips aus Westafrika – all diese reinen Naturprodukte bringt das Unternehmen deshalb transparent in die Tüte: Auf den Verpackungen können sich Verbraucher:innen direkt über die Herkunft der Rohware informieren. Wer den QR-Code auf der Rückseite scannt, erfährt darüber hinaus noch einiges mehr über die Anbauregion und die Ursprungsprojekte des Unternehmens.
Purer Geschmack
Mandeln baut Farmer’s Snack zum Beispiel klimafreundlich auf eigenen Plantagen in Europa an. Auf Mallorca wachsen sie an den Süßmandelbäumen wild und entfalten ihren milden, marzipanartigen Geschmack. Anschließend gelangen sie auf direktem Weg in die hauseigene Produktion. Als vorbildlich gilt auch der Anbau der Ananas: In Südafrika

Wenn der kleine Hunger zwischendurch kommt oder der große Heißhunger auf eine Knabberei, sollten Nüsse die erste Wahl sein.
gesund sind Gemüsesticks mit Joghurtdip. Dass Gemüse gesund ist und wenig Kalorien hat, ist allseits bekannt. Aber als Snack abends beim Fernsehen oder zwischendurch während der Arbeit?

Da zögern viele. Doch probieren geht über studieren und das Gefühl, sich eine Knabberei in den Mund zu stecken, stellt sich allemal ein. Körper, Fitness und Gesundheit werden es einem danken, wenn man regelmäßig zu kleingeschnittenen Paprika, Gurken oder Radieschen greift, die mit einem lecker gewürzten Low Carb-Dip veredelt werden.
ANZEIGE – ADVERTORIAL
kümmert sich Farmer’s Snack persönlich darum, dass die süße Frucht vor Ort geschält, geschnitten, schonend getrocknet und verpackt wird. Anschließend geht es für die Naturprodukte ohne Umwege „vom Feld zu Dir“ nach Deutschland. Und das schmeckt man: Tüte öffnen – den Duft und das wunderbar fruchtige Aroma genießen!

31 LEBENSMITTEL Eine unabhängige Kampagne von Contentway
Anstatt zu Schokolade oder Chips zu greifen empfiehlt sich der Griff zu ungesüßtem Popcorn. Der gepoppte Mais ist ballaststoffreich und wirkt sättigend.
fakten
Wenn Alexander Herrmann gerade nicht am Herd steht und leckere Gerichte zubereitet, dann ist er gerne auch mal – um im Bild zu bleiben – eine Couch-Potato. „Ich kann zum Entspannen einfach auf dem Sofa liegen und Nichts tun“, sagt der 58-Jährige. Ebenso hört er gerne Romane als Hörbücher.
3Fragen an Annemarie
Leniger

Annemarie Leniger, Geschäftsführerin der Ostfriesischen Tee Gesellschaft und verantwortlich für Marketing, Einkauf, Qualitätssischerung sowie Forschung und Entwicklung

großes interview Kochen kann jeder und der Zeitaufwand in der Küche wird überschätzt, sagt TV-Koch Alexander Herrmann. Sein Tipp für Anfänger: Einfach mal anfangen.
Text: Armin Fuhrer
Foto: Jens Hartmann
Herr Herrmann, Sie haben zwei Michelin-Sterne und sind als TV-Koch bekannt. Ist für Sie kochen eigentlich Beruf oder Berufung?

Ehrlich gesagt kann ich nur schwer unterscheiden zwischen berufl ichem und privatem Kochen. Es gibt aber doch einen Unterschied: Wenn ich berufl ich am Herd stehe, bin ich wesentlich präziser, denn dann muss alles perfekt stimmen. Wenn ich privat für mich und meine Familie koche, dann lasse ich auch schon mal alle fünf gerade sein – da ist es nicht so schlimm, wenn von einem Gewürz mal eine Prise zu viel verwendet wird.
kochen. Einen Gurkensalat können auch Kinder zusammenschnipseln, der muss nicht unbedingt perfekt aussehen. Allerdings gebe ich zu, dass gerade die deutsche Küche ein Problem hat, wenn es um den Zeitaufwand geht.
Inwiefern?
Keine andere Küche ist so zeitintensiv wie die Deutsche. Das gilt selbst für ein einfaches Gericht wie Bratkartoffeln – Sie müssen die Kartoffeln erst kochen, dann auskühlen lassen, schneiden und braten. Mediterrane Gerichte wie Penne Arrabiata gehen viel schneller. Und mediterrane Küche verzeiht auch eher kleine Fehler, wie z. B. die Beigabe von zu vielen Gewürzen.
Frische Zutaten oder Fertigprodukte?
Wenn man selbst mit gesunden und frischen Zutaten kocht, tut man seiner Gesundheit etwas Gutes. Deshalb fi nde ich, dass man solche Zutaten zumindest dann verwenden sollte, wenn man sich am Wochenende Zeit nimmt für die Zubereitung einer Mahlzeit. Das bedeutet für mich auch Lebensqualität.
Wir sprachen über Zeit – aber ein gewisses Talent braucht man doch auch, oder?
kochen. Daneben sollte eine Küche mit zwei unterschiedlich großen Pfannen ausgestattet sein. Zum Schneiden sind drei Messer ausreichend, davon ein Sägemesser für Brot. Als elektrisches Gerät verwende ich zuhause nur einen Pürierstab mit verschiedenen Aufsätzen. Mehr braucht man nicht.
Und was wird in deutschen Küchen besonders gerne gekocht?
Je besser die Rohstoff e, desto größer der Genuss?
Braucht man unbedingt viel Zeit, um sich ein gutes Essen zu zaubern?
Die Klage, dass ein Gericht zuzubereiten so wahnsinnig viel Zeit kostet, fand ich schon immer etwas mühsam. Alles, was wir machen, benötigt doch Zeit. Wenn Sie zum Beispiel ein paar Mal pro Woche ins Fitnessstudio gehen, um sich sportlich und fit zu halten, ist dafür auch ein großer Zeitaufwand nötig. Die Frage ist: Wofür bin ich bereit, meine Zeit zu nutzen? Aber wenn ich zuhause koche, benötige ich im Alltag ohnedies selten länger als eine halbe Stunde. Kochen kann ja übrigens auch gemeinsame Zeit bedeuten. Ich halte es zum Beispiel für sehr wichtig, dass Familien zusammen

Beim Kochen ist so wie mit dem ersten Kuss: Ein bisschen Talent ist durchaus sinnvoll. Aber irgendwann versucht es trotzdem jeder und wem das naturgegebene Talent fehlt, der muss sich eben ein bisschen mehr anstrengen. Ich bin der Meinung, dass jeder fähig ist, zu kochen, und es gibt viele gute Kochbücher für Anfänger, in denen man sich Ratschläge holen kann. Mein Tipp: Einfach mal machen.
Was sollte es in jeder Küche eines Hobbykochs geben?
Für Gerichte für zwei bis vier Personen reichen in der Regel zwei Töpfe völlig aus. Im Größeren mit etwa fünf Liter kann man dann beispielsweise Nudeln
Pasta ist des Deutschen liebstes Kind. Das ist schnell gemacht und wie schon gesagt: Die mediterrane Küche verzeiht sehr viel. Kartoffeln und Reis teilen sich den zweiten Platz bei den Stärkegerichten. Hierzulande wird gerne auch bürgerlich und deftig gekocht, also z. B. Kartoffelgratin und Lasagne. Ebenso hat die asiatische Küche viele Freunde. Auch einfache deutsche Gerichte sind sehr beliebt. Wenn man eine Scheibe Leberkäse mit einem Spiegelei belegt, ist das schnell gemacht –für mich übrigens eine große Delikatesse. Fleisch wird nach wie vor sehr viel gegessen, aber die heranwachsenden Generationen legen viel größeren Wert auf Gemüse. Übrigens gibt es gerade einen Trend, Gemüse zu fermentieren. Das ist eine tolle Sache, denn eingemachtes Gemüse ist gesund und der Körper wird es einem danken. Mein Restaurant hat ein eigenes Labor, in dem wir das testen.
Genuss entsteht erst, wenn die Qualität stimmt, aber auch die Verantwortung hinter den Kulissen ernstgenommen wird. Bedeutet: Die Zutaten selbst sind genauso wichtig wie das Engagement für mehr Nachhaltigkeit und Transparenz, das wir gemeinsam mit unseren langjährigen Partnern im Tee-Anbau vorantreiben.

Wie beeinfl ussen Anbaugebiet und Erntezeiten den Geschmack?
Wir verwenden mehr als 200 pfl anzliche Zutaten aus über 90 Ländern. Mit Tee ist es wie mit Wein: Je nach Anbaugebiet und klimatischen Bedingungen unterscheidet sich der Geschmack. Auch Erntemethoden haben einen Einfl uss. Unsere Tea Taster überprüfen die Rezepturen ständig, um den Geschmack zu optimieren.
Welche Rolle spielt die Verarbeitung?

Wir betreiben viel Aufwand, um Rohstoff e in bester Qualität zu bekommen. Um die Aromen zu erhalten, verarbeiten wir sie besonders schonend. Dabei hilft unsere über 115-jährige Erfahrung genauso wie modernste Technologie.
Text: Kirsten Schwieger, Foto: Presse/OTG
Zum Schluss einmal Hand aufs Herz: Gibt es bei Ihnen auch manchmal Fast Food oder eine Portion Pommes mit Majo und Ketchup?
Auch wenn ich professioneller Koch bin, bedeutet das nicht, dass ich immer nur High-End esse. Ich esse mit Emotionen und daher fi nde ich auch manchmal den Weg zur Imbissbude oder mache mir eine Leberkäs-Semmel.
LEBENSMITTEL Eine unabhängige Kampagne von Contentway 32
Alexander Herrmann:
„Ich esse mit Emotionen“
„Zum Schneiden sind drei Messer ausreichend, davon ein Sägemesser für Brot.“
„Die Zutaten selbst sind genauso wichtig wie das Engagement für mehr Nachhaltigkeit und Transparenz, das wir gemeinsam mit unseren langjährigen Partnern im Tee-Anbau vorantreiben.“
„Auch einfache deutsche Gerichte sind sehr beliebt.“
Best of BBQ?
grillen Kohle-, Gas- oder Elektrogrill: Welcher ist der Beste? Diese Frage erhitzt die Gemüter – und ist nicht einfach zu beantworten, da jedes System Vorund Nachteile hat.
Text: Kirsten Schwieger
Foto: Ataberk Güler/unsplash
Eingefl eischte Grillfans schwören auf Kohlegrills, denn für sie gehören Feuer und Fleisch zusammen wie Pech und Schwefel. Weil nur das Grillen mit Holzkohle oder Briketts dem Grillgut das charakteristische rauchige Grillaroma verleiht. Außerdem ermöglichen die kompakten und flexibel transportier- und aufstellbaren Geräte das Grillen in der freien Natur. Einfache Modelle für den Eigenzusammenbau gibt es schon für relativ kleines Geld. Für Kugelgrills mit Deckel muss man schon etwas tiefer in die Tasche greifen, dafür ermöglichen diese neben scharfem Angrillen auch schonendes Garen. Dieses indirekte Grillen verhindert die Freisetzung von Giftstoffen, wenn Fleischsaft oder Fett auf die Kohleglut tropfen. Der größte Nachteil von Holzkohlegrills ist aber wohl die Rauch- und Geruchsentwicklung, welche nicht selten verärgerte Nachbarn auf den Plan ruft. Von allen drei Grillarten verursachen Kohlegrills zudem das meiste klimaschädliche CO2. Außerdem braucht es Geduld: Mit Vorbereitung und Anheizzeit vergeht locker eine halbe Stunde.

Der Zeitfaktor wiederum ist ein defi nitiver Pluspunkt des Gasgrills. Butan- oder Propangasfl asche aufdrehen, erwünschte Temperatur einstellen und schon kann das Grillgut aufgelegt werden. Ein weiterer Vorteil ist die präzise regelbare Temperatur. Über die Gaszufuhr der einzelnen Brenner kann bei guten Gasgrills die Hitze der jeweiligen Flamme
bestimmt und so Zonen mit unterschiedlichen Temperaturen ermöglicht werden. Bei solch hochwertigen Modellen sind die Brenner zudem mit Flammenverteilern geschützt, welche verhindern, dass Fett und Fleischsäfte in die Flammen tropfen. Gasgrills produzieren kaum Rauch und keine Asche. Allerdings lassen sie auch das „typische“ Grillaroma vermissen – es sei denn, man investiert in spezielle Rauchkapseln wie Räucherpellets, Smoking Chips oder Holzspäne in Räucherboxen. Apropos investieren: In der Anschaff ung ist der Gasgrill verhältnismäßig teuer – angefangen bei circa hundert Euro ist die Preisspanne ziemlich groß.
Elektrogrills bieten zwar nicht das besondere Grill-Feeling, dafür aber eine schnelle, pragmatische Möglichkeit auf Balkon oder Terrasse zu grillen. Einfach in die Steckdose stecken und innerhalb kürzester Zeit ist er aufgeheizt und das Grillgut gar. Ohne sich Gedanken über Rauch, Nachbarn oder eine gefüllte Gasfl asche machen zu müssen.
Allerdings lässt auch er das spezielle Grillaroma missen. Dafür lassen sich antihaftbeschichtete Grillplatten leicht reinigen und Asche muss auch keine entsorgt werden. Auch der recht günstige Anschaff ungspreis überzeugt. Darüber hinaus stellt der Elektrogrill die klimafreundlichste der drei Grillvarianten dar – besonders wenn er mit Ökostrom befeuert wird.
Preise Kohlegrill:


Einfache Rundgrills gibt es schon ab circa 10 Euro. Mini-Kugelgrills und Säulengrills aus Edelstahl starten bei ungefähr 40 Euro.
Gasgrill:
Ab circa 100 Euro geht es los. Hochwertigere Geräte kosten ab 300 Euro und mehr.
Elektrogrill:
Günstigste Modelle starten bei circa 25 Euro, für ein gutes Modell sind jedoch mindestens 100 Euro fällig.
Nusskerne und Trockenfrüchte sind der beste Snack für zwischendurch, wenn der große Heißhunger kommt. Sie sind gesund, enthalten wertvolle Inhaltsstoff e und sättigen schnell und lang anhaltend. Stammen die Packungen voller Nüsse, Nussmischungen und Früchte-Nuss-Mischungen von Farmer’s Snack, kann man sich darauf verlassen, dass sie nicht nur hervorragend schmecken, sondern am Produktionsstandort Seevetal auch klimapositiv verarbeitet werden.
Die Rohwaren dafür kommen aus der ganzen Welt: Die Ananas aus Südafrika, die Paranüsse aus Bolivien, die Mangos und Kokoschips aus Westafrika. Gerade aus Gründen des Klimaschutzes versucht Farmer‘s Snack, immer mehr Rohstoff e aus nahegelegenen Regionen wie z. B. Mandeln aus Katalonien und aus eigenem Anbau aus Mallorca zu verarbeiten.
Holzkohlegrill verleihen dem Grillgut das charakteristische Raucharoma. Bei Gasgrills kann man hierzu spezielle Rauchkapseln nutzen.
Mit seinen Lieferanten arbeitet Farmer’s Snack seit vielen Jahren zusammen und ist regelmäßig im Ursprung vor Ort, um den Anbau in Bezug auf seine strengen Qualitäts- und Sozialstandards zu unterstützen. Auf der Webseite des Unternehmens fi nden sich weitere Hintergrundinformationen zu vielen Produkten.
Text: Katja Deutsch, Foto: Presse
ADVERTORIAL
Grill-Genuss für jede Gelegenheit: Stylische PRO-Serie von RÖSLE bietet besten Komfort
Sommer, Sonne, Grillgenuss – sobald die ersten warmen Tage nach draußen locken, wird angegrillt. Dabei geht es um mehr als nur satt werden: eine gute Zeit mit Freunden und Familie verbringen, Essen gemeinsam zubereiten und genießen. Mit dem passenden Equipment von RÖSLE macht es doppelt so viel Spaß.
Ganz in schwarz und mit extra Features
Die neuen und exklusiven BBQ-Stationen der VIDERO PRO-Serie sind nicht nur optisch echte Highlights, sie bieten auch durchdachte und praktische Vorteile, die das Grillen auf das nächste Level heben. Dazu zählen, zusätzlich zu der matt-schwarzen Optik, clevere Schubladen im Unterschrank, in denen sich neben Gewürzen und Saucen auch Grillhandschuhe und Schneidebretter griffbereit verstauen lassen. Primezone und Seitenbrenner besitzen massive Gussroste und das integrierte VARIO+ Grillrostsys-
tem sorgt weiterhin für vielseitige Genussmomente am Grill. Die dreifarbig beleuchteten Drehknöpfe, für die perfekte Kontrolle und Steuerung der Gaszufuhr, runden die edle Ausstattung ab.
satzbereit und vor allem leicht zu reinigen, dank der herausziehbaren Fettauffangwanne aus Edelstahl, die zusammen mit dem Grillrost auch in der Spülmaschine gereinigt werden kann.
Der Klassiker: Holzkohlegrill
Für Balkon-Griller und Outdoor-Fans
Auch die kleinen mobilen Grills, als Elektro- oder Gasgrill, gibt es in der PRO-Version. Kompakt, handlich, aber voller Grill-Power und in bewährter RÖSLE Qualität sind sie einfach zu bedienen, schnell ein-
Der typische Geruch eines Holzkohlegrills und die Zeit, die man sich zur Befeuerung nimmt, gehören für viele zu einem Grillabend dazu. Und so gibt es auch einen RÖSLE Holzkohle-Kugelgrill im edlen schwarzen Design der PRO-Serie. Als besonderes Highlight gibt es dabei das VARIO+ Grillrostsystem in Edelstahl on top, für vielfältige Genüsse vom Grill, egal ob knackiges Gemüse aus dem Wok, würziger Eintopf aus dem Dutch Oven oder knusprige Pizza vom Pizzastein.
Egal, ob mit Gas, Elektro oder Holzkohle – mit RÖSLE wird Grillen zu einem Genuss-Erlebnis auf höchstem Niveau!
33 LEBENSMITTEL Eine unabhängige Kampagne von Contentway
?Wussten Sie schon, dass... Nusskernmischungen nicht nur gesund sind, sondern auch klimapositiv verarbeitet werden können?
Gasgrill BBQ-Station VIDERO PRO G4-S VARIO+
Schnellkochtopf spart schlau Energie
klimaschonend kochen Regionale Lebensmittel sind wichtige Zutaten für nachhaltiges Kochen. Wer sie im richtigen Gefäß gart, darf guten Gewissens klimafreundlich genießen.

Text: Kerstin Kloss
Foto: Uwe Conrad/unsplash
Ab April ist Blumenkohl wieder als regionales Saisongemüse verfügbar und eignet sich ideal für die nachhaltige Küche. Aber aufgepasst, dass der CO2-Fußabdruck auch am Herd klein bleibt – sonst gibt es Punktabzug nach dem sonst so klimafreundlichen Einkauf auf dem Markt. Wer das weiße Gemüse smart im Schnellkochtopf zubereitet, verbraucht nur halb so viel Energie wie in einem konventionellen Kochtopf. Das ipi Institut für Produkt- und Marktforschung in Stuttgart gibt den Gesamt-Energieverbrauch mit 198 im Vergleich zu 404 Wattstunden an. Außerdem ist Blumenkohl laut ipi schon in 13 Minuten essfertig, während er normalerweise knapp dreißig Minuten köchelt.
Im Schnellkochtopf verkürzt sich die Kochzeit, weil Lebensmittel darin mit höherer Temperatur von fast bis zu 120 Grad gar werden. Möglich macht das ein dicht schließender Deckel mit fest einrastendem Schraubverschluss und druckfester Gummiringdichtung. Nachhaltiges Kochen geht fi x: Einfach den Topfboden mit etwas Wasser befüllen, Lebensmittel ressourcenschonend in einer Schüssel
statt unter dem laufenden Wasserhahn waschen, in den Siebeinsatz des Dampfdrucktopfes legen, Deckel zuschrauben – fertig. Im Inneren kann sich Druck für das Dampfgaren aufbauen, das als besonders nährstoff- und aromaschonend gilt.
Der ‚Speedy Gonzales‘ unter den Töpfen punktet hinsichtlich Energie, Zeit und Nährstoffen bei fast allen unverarbeiteten Lebensmitteln, die auf dem Einkaufszettel für nachhaltiges Kochen so stehen. Das gilt ipi zufolge speziell für Hülsenfrüchte, wie unverarbeitete Sojabohnen, die mit allen erhaltenen Mineralstoffen schon nach gut 30 Minuten gar sind anstatt nach über zwei Stunden. Blumenkohl verfügt nach dem Dampfgaren noch über 82 Prozent der Mineralstoffe, während im normalen Kochtopf durch den direkten Wasserkontakt bereits fast 50 Prozent ausgewaschen werden.
Stiftung Warentest hat nachgewiesen, dass Schnellkochtöpfe vor allem auf einem energieeffi zienten Induktionsherd schnell kochen. Aber hohe Anschaff ungskosten schrecken ab. Kann Kochen fürs Klima auch mit gewöhnlichen Töpfen auf Herden mit Glaskeramik-Kochfeldern oder Gussplatten gelingen? „Schon mit einfachen Handgriffen lässt sich einiges bewirken“, sagt Volker Irle, Geschäftsführer bei der Arbeitsgemeinschaft Die Moderne Küche, AMK, in Mannheim. Die Wirtschaftsvereinigung und Interessenvertretung der Küchen-
Im Schnellkochtopf verkürzt sich die Kochzeit, weil Lebensmittel darin mit höherer Temperatur von fast bis zu 120 Grad gar werden.
branche rät: Deckel drauf, damit kein Wasserdampf entweichen kann und es schneller geht, nicht mehr Wasser verwenden als nötig.
Umweltwissenschaftler Christoph Schulz engagiert sich in seinem Blog ‚CareElite‘ für nachhaltige Lebensweisen. Sein Kochtipp: „Restwärme nutzen“ – also die Herdplatte zwei bis drei Minuten früher abstellen. Und das Bundesministerium für Verbraucherschutz verweist auf den Wasserkocher, der gegenüber einem Elektroherd deutlich weniger Strom benötigt. So lässt sich der CO2-Fußabdruck verringern, wenn Blumenkohl im normalen Topf köchelt.

fakten
Übrigens wird der Schnellkochtopf in Deutschland dieses Jahr 70 Jahre alt und damit wird auch der Standort Idar-Oberstein als Geburtsstätte gefeiert.
Markenversprechen: Gewöhnliches außergewöhnlich gut machen!
Jeder verbindet die Premiummarke Mövenpick Fine Food mit dem Werteversprechen: Gewöhnliches außergewöhnlich gut machen! Als der Schweizer Ueli Prager 1948 die Marke Mövenpick gründete, war sein Anliegen, dass man: „...im Fluge, schnell etwas Kleines, Gutes essen“ kann. Bei einem Spaziergang auf der Zürcher Quaibrücke beobachtete Ueli wie eine Möwe aus der Hand eines Mannes ein Stück Brot pickte – so war der Name Mövenpick geboren. Die Schreibweise mit V statt mit W erschien Prager passender zum Flügelschlag der Möwe.
„Bis heute ist sein Anspruch in jedem einzelnen Mövenpick Produkt, mit viel Liebe zum Detail den bestmöglichen Geschmack zu garantieren. Mittlerweile gehören Kaff ee-Spezialitäten, Milchfrischprodukte, Gourmet-Fruchtaufstriche, Haselnuss-Crèmes und Rührkuchen-Klassiker zum Mövenpick Sortiment“, sagt Jürgen Herrmann, CEO der Mövenpick Holding AG.
Mövenpick ist nach wie vor regional in der Schweiz verwurzelt. Hauptsitz ist Baar in der Nähe von Zürich. www.moevenpick-fi nefood.com
Text: Armin Fuhrer, Foto: Presse
„Bis
LEBENSMITTEL Eine unabhängige Kampagne von Contentway 34
heute ist sein Anspruch in jedem einzelnen Mövenpick Produkt, mit viel Liebe zum Detail den bestmöglichen Geschmack zu garantieren.
Mittlerweile gehören Kaffee-Spezialitäten, Milchfrischprodukte, GourmetFruchtaufstriche, Haselnuss-Crèmes und Rührkuchen-Klassiker zum Mövenpick Sortiment.“
Deckel verhindern ebenfalls das Entweichen von Wärme und beschleunigen die Garzeit.
Jürgen Herrmann, CEO der Mövenpick Holding AG.












Alexander Herrmann empfiehlt die Original-Profi Collection® #fürdaswaszählt
Präventive Hautpflege ist Zeitgeist
einleitung
Als Dermatologin mit Spezialisierung im Bereich der ästhetischen Dermatologie und reichweitenstarken Social-Media-Profilen beobachte ich ein gesteigertes Interesse an Hautgesundheit und Hautpflege – insbesondere bei jüngeren Menschen.

Foto: Presse

Solarien sind wie Sonnenbrände längst nicht mehr salonfähig, seit Informationen digital so leicht zugänglich sind. Wo früher versucht wurde, Sonnenschäden wegzucremen, wird heute präventiv mit Pflegeprodukten und Sonnenschutz vorgesorgt. Doch woran erkennt man einen optimalen Sonnenschutz? Was macht eine gute Hautpflege aus? Welche Schritte einer Pflegeroutine sind wann wichtig – und wie oft?
Hautgesundheit ist ganzheitlich von innen und außen zu betrachten. So wie unser größtes und vielfältigstes Organ den Körper vor Umwelteinflüssen schützt, sollten wir die Haut im Gegenzug frühzeitig mit Pflege und gesundem Lifestyle (be-)schützen. Eine direkte UV-Exposition, insbesondere ohne Sonnenschutz, sollte gemieden werden. Kopfbedeckungen und dicht gewebte, dunkle Kleidung sind der effektivste Sonnenschutz. Bereiche wie Gesicht und Hände, die selten textil bedeckt sind, benötigen morgens und auch bei Bewölkung Sonnenschutzprodukte, die UVA-, UVB- und UVE-Filter enthalten. Ein Lichtschutzfaktor, der sichtbar auf Produkten ausgelobt ist, z. B. LSF 50, schützt vor UVB-Strahlung bzw. Sonnenbrand. Er gibt an, wie viel länger man sich nach Anwendung eines Sonnenschutz-Produkts in der Sonne aufhalten kann, ohne einen Sonnenbrand zu bekommen. Um diesen ausgelobten Lichtschutz zu erhalten, sollte ausreichend Sonnenschutz aufgetra-
gen werden – alle zwei Stunden sowie nach Schwitzen und Wasserkontakt
UVA-Strahlung, die übrigens auch Glasscheiben durchdringen kann, beschleunigt die Hautalterung und dringt wie blaues Licht, sogenanntes HEV-Light (High Energy Visible Light), in die tieferen Hautschichten ein. Ein optimaler Sonnenschutz fi ltert all diese Bereiche sowie Umwelteinflüsse und Feinstaubpartikel. Mehr ist mehr: Mit Creme bedeckte Fingerlängen von Zeige-, Mittel- und Ringfi nger sind eine ausreichende Menge für Gesicht und Hals. Für den gesamten Körper benötigt ein erwachsener Mensch im Schnitt sechs Teelöffel Sonnenschutz. Anwender sind jedoch meistens wesentlich sparsamer. Dünnhäutige Partien wie Augen- und Lippenhaut benötigen genauso wie sogenannte ‚Sonnenterrassen‘ (z. B. Nasenrücken, Ohrmuscheln, Schultern) eine Extraportion. Und keine Sorge: Laut Studienlage hemmt Sonnenschutz die Vitamin D Produktion kaum, weshalb es nicht zu Stimmungsverschlechterungen o. ä. kommen kann. Eine auf den kosmetischen Hauttyp abgestimmte Pflegeroutine ist ebenfalls wichtig für gesunde Haut. Den Hauttyp kann man einfach selbst bestimmen, indem man sich mit lauwarmem Wasser wäscht und den Hautzustand nach 30 Minuten begutachtet. Ist die Haut trocken und spannt, kann man von einem trockenen Hauttyp ausgehen, Mischhaut beschreibt eine ölige T-Zone, ein öliger Hauttyp glänzt ganzfl ächig. Je nach Hauttyp kann man Produkte und Pflegeroutinen individuell nach jeder Reinigung morgens und abends oder auf Jahreszeiten abgestimmt anpassen. Zu zeitintensiv? Der meditative Faktor einer Gesichtsreinigung mit anschließender Pflege ist nicht zu unterschätzen. Skincare ist Selfcare – Selbstfürsorge und eine Investition in unser Wohlbefi nden im hektischen Alltag und unsere langanhaltende Hautgesundheit.
ALVEROA– PARTNER CONTENT

„Laut Studienlage hemmt Sonnenschutz die Vitamin D Produktion kaum, weshalb es nicht zu Stimmungsverschlechterungen o. ä. kommen kann.“
Aloe Ferox – die ursprüngliche Aloe Vera

Gepfl egte Haut ist attraktiv, stärkt unser Selbstbewusstsein und benötigt die besten Wirkstoff e der Natur.
Besonders bekannt dafür ist die Aloe Vera Barbadensis Miller, welche auf Plantagen gezüchtet wird. Weniger bekannt hingegen ist Aloe Ferox aus der gleichen Pflanzenfamilie, die Urpflanze der Aloe Vera. Wissenschaft liche Studien bestätigen die Kraft dieser wildwachsenden Pflanze, die allein von der unberührten Natur – ohne Eingriff des Menschen – geschaffen wird.
Aloe Ferox reines Wildwachstum
Aloe Ferox gedeiht nur unter der Sonne Südafrikas, ohne Einsatz von Chemikalien und Pestiziden. Aufgrund mehrjähriger
Alveroa Commerce GmbH









Wachstumszyklen ist die Aloe Ferox eine der wirkungsvollsten Wildpflanzen. Sie enthält essenzielle Bestandteile, wertvolle Aminosäuren, Proteine, Enzyme, Vitamine sowie zahlreiche Mineralien und Spurenelemente in höchster Konzentration. Dank dieser Inhaltsstoffe dringt Aloe Ferox tief in die Hautschichten ein, beschleunigt den Heilungsprozess und schützt vor frühzeitiger Hautalterung. Gleichzeitig bilden die natürlichen Wirkstoffe eine Schutzschicht, die ein Austreten der Feuchtigkeit verhindert. Die Haut ist optimal hydriert, Falten werden vermindert, Trockenheit verhindert oder fettige Haut reduziert. Hautirritationen und sensible Stellen werden durch entzündungshemmende Stoffe beruhigt. Das Hautbild wird verfeinert, erscheint ebenmäßig und prall.
Einzigartige Produkte durch neue Wirkstoff komplexe
Neue Wege mit Aloe Ferox geht das Schweizer Familien Start-up «Alveroa», durch die Kombination von Aloe Ferox mit 100% veganen Wirkstoffen zu einzigartigen Wirkstoffkomplexen. Das Start-up entwickelt und produziert in der Schweiz und hat nach 2-jähriger Entwicklungszeit eine Gesichtspflegeroutine mit Wash und hauttypspezifischer Creme lanciert. Die Gesichtspflege mit Anti-Aging-Effekt umfasst dank der Kraft der Aloe Ferox nur zwei Produkte. Bezeichnend für Alveroa ist, dass es neben besten Wertungen auch von «Experten testen» von RTL-News zum Vergleichstestsieger gekürt wurde. Kundenzufriedenheit steht im Zentrum, so erstattet Alveroa bei nicht Gefallen

Alveroa entwickelt und produziert mit Herzblut und Pioniergeist hochwertigste Gesichtspfl egeprodukte in der Schweiz. Wir setzen dabei auf Wirkstoff komplexe mit Aloe Ferox, einer wildwachsend und nur in Südafrika vorkommenden Aloe Art. www.alveroa.de
den Kaufpreis zurück. Alveroa wird unter anderem auf www.alveroa.de angeboten.
HAUTGESUNDHEIT Eine unabhängige Kampagne von Contentway 36
Dr. Emi Arpa, Fachärztin für Dermatologie & Gründerin Dr. Emi Cosmetics
Kosmetik ist nicht nur Frauensache







pflege
Heute ist ein waschechter Kerl nicht mehr der, der sich offensiv nicht pfl egt.
Höchste Zeit also, dass Mann sich auch kosmetisch emanzipiert
Text: Julia Butz
Foto: Allef Vinicius/unsplash
Nur Wasser an die Haut? Die Zeiten, in denen das als männlich, ursprünglich und kernig galt, sind lange vorbei. Viele Männer beschäftigen sich heute bewusster mit Hygiene und Pflege, eine Entwicklung, die sich in Produktauswahl und Marktpräsenz aber noch nicht widerspiegelt. Das macht es Männern nicht immer leicht, ein passendes Produkt oder überhaupt einen Zugang zu Pflegeprodukten zu fi nden.
Auch trockene Männerhaut bringen Cremes mit Hyaluronsäure und Mineralstoffen in Schwung. Nach häufi gem Duschen will der Feuchtigkeitshaushalt mit Repair-Cremes aus hautidentischen Inhaltsstoffen wieder ins Lot gebracht werden, Peelings frischen die Hautstruktur auf und sind bester Anti-Aging-Trick, schweißresistenter UV-Schutz hilft Sportlichen gegen langfristige Hautschäden. Es ist daher überhaupt nicht verwunderlich,
dass Mann gern zur Pflegelotion der Frau greift. Allerdings ist die Männerhaut hormonbedingt zwei- bis fünfmal dicker als Frauenhaut. Dadurch produziert sie mehr Fett und altert später. Die sehr reichhaltigen Pflegecremes für Frauen können Männerhaut irritieren und das Hautbild sogar verschlechtern. Männerhaut hat außerdem größere Poren und wird durch die Rasur regelmäßig sehr beansprucht.
Ein Hautprodukt Unisex zu nennen, passt nach Expertenmeinung daher überhaupt nicht in die Beauty-Realität. Obwohl es um viel mehr als um Duftanpassungen geht, orientieren sich viele Brands noch immer eher an den Bedürfnissen der Frau. Aber Männerhaut benötigt ebenso spezielle Inhalts- und Rohstoffe, die auf ihre Bedürfnisse und den jeweiligen Hauttyp zugeschnitten sind. Dazu gehören auch Eigenschaften wie z. B. in der Gesichtspflege oder beim Hair-Styling weniger Glanz und mehr Mattigkeit zu erzielen.
Aus Marketingsicht mögen es Männer unkompliziert und praktisch, bestenfalls indem ein Produkt direkt mehrere Funktionen enthält oder diese in der Anwendung aufeinander aufbauen. Produkte, die den aktiven Lebensstil unterstützen und die
selbstbewusste Haltung zu sich selbst noch besser ausstrahlen lassen. Auch die werbliche Ansprache unterscheidet sich, Nutzen und Funktion werden dabei meist in den Vordergrund gestellt: ein Bartfärbungsmittel wird z. B. nicht als „Coloration“, sondern als „Bartfarbe“ bezeichnet. Bartpflegeprodukte gehören zu den Wachstumstreibern der Männerkosmetik. Der Bart als modisches Accessoire und Ausdruck demonstrativer Männlichkeit. Denn Bärte stehen, obwohl sie aufwendiger Pflege bedürfen, für das urwüchsig Männliche. Rasiermesser und Trimmer, Cremes und After-Shave-Balms, hochwertige Bartöle und -düfte bis zu passenden Bartbürsten, -wachsen und -reinigern.
COLLAGEN – eine Alternative zum Skalpell?
Nach intensiver Forschung haben Wissenschaftler der deutschen GELITA AG, Weltmarktführer bei hochwertigen CollagenProdukten, spezielle bioaktive Collagen-Peptide der Marke VERISOL® entwickelt. Unter bioaktiven Collagen-Peptiden versteht man Proteinfragmente, also kurze Aminosäurenketten, die körperliche Vorgänge modulieren und so den Zustand sowie die Funktion des Organismus positiv beeinflussen können. VERISOL® Collagen ist extra für die kosmetische Anwendung optimiert. Die speziellen Collagen-Peptide gelangen nach der Einnahme in den Blutkreislauf und werden dort als Collagen-Abbaufragmente erkannt. Dadurch werden die Fibroblasten (die Collagen produzierenden Zellen) der Haut angeregt, körpereigenes Collagen zu produzieren und gleichen so den altersbedingten Abbau des Strukturproteins aus.
In Studien (1,2,3,4) nachgewiesene Effekte von VERISOL® Collagen-Peptiden auf Haut & Fingernägel:
• Steigerung der Hautelastizität um bis zu 15%1
• Verringerung der Faltentiefe um durchschnittlich 20,1%2
• Signifikanter Rückgang des Cellulite-Grades nach ca. 6 Monaten3










• Signifikante Verbesserungen des Nagelwachstums nach ca. 3 Monaten4
• Rückgang von spröden und brüchigen Nägeln um 42% nach ca. 6 Monaten4
Das in unseren Cellufine® Collagen-Produkten enthaltene VERISOL®-Collagen kann demnach zu weniger Falten, einer gesteigerten Elastizität und mehr Straffheit der Haut, einem jüngeren Aussehen und gesunden Fingernägeln verhelfen.1,2,3,4
Unsere Haut im Vergleich ...

Die Produktpalette für die rundum Pflege und ein perfektes Bartstyling wie im Barbershop ist schneller gewachsen als die der klassischen Männerkosmetik. Eine Marktlücke, bei der die Kosmetikindustrie noch einiges nachzuholen hat.
fakten
60 % des Umsatzes entfallen im Markt für Männerkosmetik auf Deound Duschprodukte. Gesichts- und Haarpfl ege rücken stärker in den Fokus. Auch die Bereitschaft, für Bartpfl egeprodukte Geld auszugeben, ist recht neu – obwohl es immer Bartträger gab.
(L’Oréal Studie/2021)

ANZEIGE
mit wenig Collagen mit ausreichend Collagen

allergenfrei
VERISOL® Collagen –bei uns als Pulver, in Kapseln & Drinks www.APOrtha.eu





JETZT ENTDECKEN!
Specific Collagen Peptides Has a Body Mass Index-Dependent Beneficial Effect on Cellulite Morphology Michael Schunck, Vivian Zague, Steffen Oesser, Ehrhardt Proksch 4 Hexsel, D., Zague, V., Schunck, M., Siega, C., Camozzato, F. O., Oesser, S., Oral supplementation with specific bioactive collagen peptides improves nail growth and reduces symptoms of brittle nails. J Cosmet Dermatol. 2017, 00, 1–7






VERISOL® ist eine eingetragene Marken der GELITA AG
www.APOrtha.eu
37 HAUTGESUNDHEIT Eine unabhängige Kampagne von Contentway
1
2
3 JOURNAL
Proksch E., Segger D., et al., Skin Pharmacol. Physiol. 27, 47-55 (2014)
Proksch E., Schunck M, et al., Skin Pharmacol. Physiol. 27, 113-119 (2014)
OF MEDICINAL FOOD, J Med Food 00 (0) 2015, 1–9, DOI: 10.1089/jmf.2015.0022, Dietary Supplementation with
für HAUT & NÄGEL1,2,3,4 Clean Label Made in Germany
Epidermis
Dermis Collagen
Normale Haut
Ausgeglichene Hautzonen
Rosig, straff, feinporig, unempfi ndlich, mitunter eine leicht fettige T-Zone: Das zeichnet den normalen Hauttypus aus. Talgproduktion, Regeneration, Abschuppung, Durchblutung und Feuchtigkeitshaushalt sind ausgewogen. Auch wenn normale Haut nicht sehr anspruchsvoll ist, sollte man sie konsequent reinigen und pfl egen. Aggressive, stark fettende oder austrocknende Inhaltsstoff e sind tabu. Besser ist es, eine tägliche Feuchtigkeitspfl ege und milde Reinigungsprodukte mit einem niedrigen pH-Wert zu verwenden, die den Fett- und Feuchtigkeitshaushalt unterstützen und die Haut mit genügend Feuchtigkeit versorgen. Ist die Haut im Winter trockener Heizungsluft ausgesetzt, eignet sich eine leicht fettende Emulsion. Ferner sollte die Haut im ganzen Jahr mit einem ausreichenden UV-Schutz geschützt werden. Bei Vernachlässigung der Pfl ege kann sich normale Haut verändern: Stress, Müdigkeit, Umwelteinfl üsse oder aggressive Reinigungsprodukte können sie schnell austrocknen und die Hautschutzbarriere beeinträchtigen. Die Haut wird dann trocken und verliert ihr gesundes Aussehen, schade drum!
Fettige Haut
Richtige P�ege benötigt
Vergrößerte Poren, Hautunreinheiten wie Mitesser oder Pickel und ein öliger Glanz: Diese Merkmale prägen das Hautbild fettiger Haut. Schuld daran sind meistens Hormone. Diese können zu einer übermäßigen Talgproduktion führen und die Haut dadurch zum Glänzen bringen. Fettige Haut zeigt sich vor allem im Gesicht, wo besonders die T-Zone betroff en ist. Aber auch an den Schultern, an Rücken und Dekolleté ist fettige Haut keine Seltenheit. Gegen fettige Haut hilft eine gründliche und regelmäßige Reinigung. Cremes und Pfl egeprodukte sollten nicht komedogen sein, die Poren also nicht verstopfen. Es kann sinnvoll sein, ein- bis zwei Mal pro Woche ein Peeling zu machen, um die Haut von abgestorbenen Hautschüppchen zu befreien und Unreinheiten verursachende Bakterien zu bekämpfen. Auch eine pfl egende Maske ist empfehlenswert. Dadurch wird das Hautbild verfeinert und ölige Haut erscheint matter. Kleiner Trost: Durch den Fettfi lm ist die Haut besser vor äußeren Einfl üssen geschützt: Kälte, Sonne und Nässe können ihr vergleichsweise wenig anhaben. Außerdem bleibt fettige Haut länger glatt und straff.
Hyaluron Serum
Optische Faltenreduktion & Feuchtigkeit Formulierung mit 4-fach Wirkkomplex
Um der natürlichen Faltenbildung mit zunehmenden Alter gezielt und optisch entgegenzuwirken, hat die Unternehmerin Tanja Horstmann das POJ ® H yaluron Serum auf den Markt gebracht.
Das Serum glättet und strafft die Haut optisch mit einem sofort wahrnehmbaren Effekt und lässt sie deutlich jünger erscheinen. Die Haut gewinnt spürbar an Feuchtigkeit und Geschmeidigkeit. Das Besondere am POJ ® H yaluron Serum ist die Kombination aus vier unterschiedlichen Hyaluronsäuren und Wirkweisen, denn die Mehrzahl der im Markt angebotenen Produkte mit Hyaluronsäure beinhalten oft nur eine oder zwei unterschiedliche Säuren.
Das Serum besteht aus hochmolekularer Hyaluronsäure, die sich als dünner Film auf die Hautoberfläche legt und Feuchtigkeit bindet. „Nach dem Auftragen verdunstet im ersten Augenblick
Trockene Haut

Hilfreiche Öle Mischhaut
Trockene Haut neigt leicht zu Rissen, Rötungen und Schuppungen oder sie weist raue Stellen auf. In extremen Fällen kann es zu einem Exsikkationsekzem (Austrocknungsekzem) kommen. Häufi ge Ursachen sind eine verminderte Talgproduktion, eine beeinträchtigte Funktion der natürlichen Hautschutzbarriere, eine mangelnde Flüssigkeitszufuhr und übermäßiges Waschen mit aggressiven Seifen und Waschgels. Menschen mit diesem Hauttyp neigen generell schneller zur Bildung von Falten. Feuchtigkeitscremes mit Hyaluronsäure haben sich für die Pfl ege trockener Haut bewährt. Auch rückfettende Cremes und Lotionen können gegen trockene Haut helfen. Zur Behandlung trockener Gesichtshaut empfehlen sich unter anderem auch pfl anzliche Öle, die zum Beispiel Mandeln oder Aloe Vera enthalten, und reichlich Trinken. Zur vorbeugenden Pfl ege empfehlen Dermatologen teilweise Urea- und glycerinhaltige Cremes. In jedem Fall ist es ratsam, nicht zu lange zu duschen oder zu baden. In einigen Fällen kann eine Grunderkrankung die Ursache trockener Haut sein. Diese ist durch einen Facharzt zu behandeln.
Der klassische Hauttyp
Trockene Hautpartien im Wangen- und Augenbereich, ein eher öliges Hautbild im Bereich von Stirn, Nase und Kinn: Mischhaut ist der am häufi gsten vorkommende Hauttyp. Die nebeneinanderliegenden fettigen und trockenen Zonen machen die Hautpfl ege nicht gerade leicht. Für die typgerechte Pfl ege von Mischhaut ist es wichtig, die unterschiedlichen Ansprüche der verschiedenen Hautbereiche zu berücksichtigen: Während die trockenen Partien reichhaltigere Produkte benötigen, welche die fehlende Feuchtigkeit der Haut ausgleichen und den Hautschutzmantel stärken, kommen in der T-Zone ausgleichende, entzündungshemmende und beruhigende Wirkstoffe zum Einsatz. Sie regulieren die Talgproduktion, bekämpfen Hautunreinheiten und sorgen für einen gleichmäßigen, mattierten Teint. Bei der Gesichtsreinigung ist darauf zu achten, die Haut nicht zu sehr zu reizen und sie mit Feuchtigkeit zu versorgen. Eine milde Reinigungslotion oder ein hydrierendes Reinigungsgel sind optimal. Als Ergänzung zur täglichen Gesichtsreinigung bieten sich talgabsorbierende, porenverfeinernde Masken oder sanfte Peelings an.
Texte: Chan Sidki-Lundius
etwas Wasser und man erlebt eine angenehm leichte optische Straffung auf der Haut“, sagt Tanja Horstmann.
Die niedermolekulare Hyaluronsäure bringt Feuchtigkeit tiefer in die Haut, bindet Wasser und polstert die Haut optisch von innen auf. Der Feuchtigkeitsspeicher hat einen positiven Einfluss auf die Wasserbalance der Haut.
Die quervernetzte Hyaluronsäure ist ebenfalls in dem Serum enthalten. Sie besteht aus sehr kleinen Molekülen, kann tief in die untere Hautschicht eindringen und gibt von dort zeitversetzt Hyaluronpartikel ab. So wird die Haut über einen längeren Zeitraum spürbar mit Feuchtigkeit versorgt.
Der vierte Wirkstoff optimiert die ersten drei Hyaluronsäure-Phasen und ergänzt sie perfekt. Weiterhin kann die Hyaluronsäure-Neusynthese verbessert und unterstützt werden, die mit zunehmendem Alter nachlässt.
POJ ® H yaluron Serum ist erhältlich unter www.thorstmanncosmetics.de, in Kosmetikinstituten sowie in jeder Apotheke Deutschlands (Bestellnr. PZN 17371806).




Das pflegende POJ ® H yaluron Serum morgens und abends nach der Reinigung auf Gesicht, Augenpartie, Hals und Dekolleté auftragen und mit sanft kreisenden Bewegungen einmassieren. Das Serum ist auch für sensible Haut geeignet, von Dermatest mit „sehr gut“ bewertet, enthält keine tierischen Inhaltstoffe, wird in Deutschland hergestellt und ist mit sämtlichen Kosmetikprodukten kompatibel.



HAUTGESUNDHEIT Eine unabhängige Kampagne von Contentway 38
Foto: Anastasiia Ostapovych/unsplash
Foto: Andrea Piacquadio/pexels
– ADVERTORIAL
Foto: Kat Stokes/unsplash
ANZEIGE
THorstmann Cosmetics GmbH Meyerbeerstr. 33 48163 Münster Tel.: +49 251 777 587 82 Fax: +49 251 777 587 80 E-Mail: info@thorstmanncosmetics.de
Tanja Horstmann, Inhaberin der THorstmann Cosmetics GmbH
Gesund Altern durch mehr Körperwissen
ernährungsmedizin
Lieber alt und gesund als jung und krank. Dieses Fazit kann man aus dem Buch Genial Vital von TV-Ärztin Dr. Yael Adler ziehen. Und: Wir können sehr viel dafür tun.


Text: Christiane Meyer-Spittler

Fotos: Duff é T.Leish/Pexels
den Organen alles passiert. Haben wir so etwas wie Gesundheitswissen oder eine Art Körperkompetenz, können wir eigene Symptome richtig lesen und besser auf uns hören. Altern ist ein multifaktorieller Prozess, und so gibt es viele richtige Wege diesem zu begegnen, bzw. viele Fehler, die wir vermeiden können.
Was sollten wir wissen, um richtig zu handeln?
aus, der ganze Rest, also über 70 % liegt an unserem Lebensstil. Von daher sollten wir Angebote an Vorsorgeuntersuchungen und Früherkennungsmaßnahmen annehmen und uns um uns kümmern. Wir können aus zahlreichen Möglichkeiten, die uns jung halten, aussuchen, was uns gut tut; seien das sportliche Aktivitäten, regelmäßige soziale Kontakte oder auch geistige Beschäftigungen.
Als Hautärztin, Ernährungsmedizinerin und AntiAging-Spezialistin erklärt Adler in ihrem Buch detailliert und verständlich die Alterungsprozesse unseres Körpers und wie wir sie positiv beeinflussen können.
Frau Adler, worin liegt der Schlüssel zum gesunden Altern?
Nach meiner Auff assung liegt der Schlüssel darin, dass wir wissen, was im eigenen Körper von der Zelle bis hin zu
Eigentlich ist unser Körper schlau und ganz kann ganz viel selber regulieren und reparieren. Doch je älter wir werden, desto schwieriger werden diese Prozesse. Es ist deshalb nötig, ab einer gewissen Lebensphase, Mitte 35 und 45 Jahren, Instandhaltungsmaßnahmen durchzuführen. Eine erste Maßnahme kann schon sein, gewisse Altersbeschleuniger zu meiden, die da wären: Nikotin, Alkohol, übermäßiges Sonnenlicht oder auch Umweltgifte. Ebenso Bewegungsmangel oder zu viel ungesunde Industriekost lässt uns schneller altern. Je mehr wir über die körpereigenen Abläufe und Zusammenhänge wissen, desto besser können wir gegensteuern und individuelles Anti-Aging betreiben.
Wie viel haben wir selbst in der Hand?
Zehn bis 30 % der Krankheiten oder chronischer Leiden machen die Genetik
Welche Alltags-Tipps können Sie uns geben?
Die Ernährung ist ein wesentlicher Beitrag zu unserer Gesunderhaltung, Nicht umsonst heißt es: ‚Du bist, was du isst‘. Lösliche Ballaststoffe dienen zum Beispiel den gesundheitsfördernden Bakterien im Darm als Düngemittel. Sie sind u. a. in Akazienfasern, Flohsamenschalen, Leinsamen, bitteren Salaten oder Wurzelgemüsen zu fi nden. Ihre Vermehrung verdrängt die gesundheitsschädlichen Bakterien im Darm und baut so ein starkes Mikrobinom auf. Nur eine gesunde Darmflora kann Vitamine, Abwehrstoffe und Botenstoffe bilden und damit ein intaktes Immunsystem stellen. Überhaupt der Verzehr von sekundären Pfl anzenstoffen, wie in Möhrensaft, Tomatenmark, Matcha Pulver Tee oder Rote Beete enthalten, ermöglicht den Aufbau von Collagen. Das macht die Haut robuster und schützt gegen Lichtalterung.
Wichtig ist auch Sport unter dem Aspekt von Radikalfängern. Diese werden durch Bewegungsreize ausgebildet und ermöglichen als Ganzkörpertraining, Alltags-Stressoren abzubauen.
Viele nützliche Alltagstipps gebe ich in meinem neuen Buch für jedes einzelne Organ, mit dem man im Laufe des Lebens zwangsläufi g einmal konfrontiert sein wird, und die notwendigen Hintergrundinformationen. Denn je mehr ich über meinen Körper und dessen Abläufe weiß, desto leichter fällt es mir, Veränderungen für ein gutes Altern vorzunehmen und umzusetzen.
Die Ernährung ist ein wesentlicher Beitrag zu unserer Gesunderhaltung.
Auch ein gesunder Schlaf ist relevant. Das Dunkelheitshormon Melatonin ist nicht nur zum Einschlafen wichtig, sondern hilft auch bei der MitochondrienReparatur, den Zellkraftwerken. Durch abendliches blaues Licht, also spätes Nutzen von digitalen Medien, wird die Bildung von Melatonin behindert. Man schläft dadurch nicht nur schlecht ein, sondern das Anti-Aging-Programm des Körpers kann nicht starten.
Buchtipp:
Das Buch Genial Vital der Fachärztin und Bestsellerautorin Dr. med. Yael Adler ist ein umfassender Ratgeber über die häufi gsten Verschleiß- und Alterserkrankungen mit anschaulichen Tipps zu möglichen Gegenmaßnahmen. Es richtet sich an alle, die ihren Körper besser verstehen und ihre Vitalität erhalten wollen.
ANZEIGE – ADVERTORIAL

Aus Liebe zur Haut: Probleme sanft behandeln
Makellose Haut bleibt für viele Menschen ein Traum. Doch die Natur bietet sanfte, aber effektive Lösungen für weit verbreitete Hautprobleme!
Ob Pickel, Pigmentflecken oder trockene Hautstellen hin zu Schuppenflechte – kaum ein Mensch hat eine gänzlich makellose Haut. Zu diesem Ergebnis kommt eine Studie der EADV (European Academy of Dermatology and Venereology). Jeder zweite Europäer leidet im Laufe seines Lebens unter Hautproblemen.
Mit den Skin Solutions hat Herbacin eine Kräuterkosmetik-Linie für Problemhaut entwickelt, um Betroffenen eine effektive und sanfte Pflege mit natürlichen Wirkstoffen zu ermöglichen.
Kern der Serie ist die 3-fach Pflanzenformel aus Aloe-Vera, Kamille und Ringelblume. Diese hochwirksame Kräuterkombination wirkt entzündungshem-
mend, antibakteriell und fördert die Regeneration von empfindlicher Problemhaut. Je nach Produkt und Anwendungsgebiet wird diese Basis-Formel mit weiteren Wirkstoffkomplexen kombiniert, die auf die jeweilige Anwendung optimal abgestimmt sind.
So zum Beispiel beim Age-Spot-Primer, der mit hochwirksamen Lansi-Baum-Extrakt die Intensität von Pigmentflecken lindert. Besonders praktisch für Menschen, die nur partiell zu Unreinheiten neigen, ist die punktuelle Behandlung von Mitessern

und Pickeln. Das Blemish-Gel von Herbacin trocknet Pickel effektiv aus und beruhigt gleichzeitig mit Aloe Vera, Kamille, Ringelblume und Panthenol. Bei geröteten, juckenden oder stark strapazierten Hautstellen kann eine Pflege mit Salz aus dem Toten Meer Linderung verschaffen. Die Mineralien unterstützen die Hauterneuerung und mildern so den Juckreiz. Für die tägliche Feuchtigkeitspflege empfindlicher Haut eignet sich der Daily Skin Moisturizer aus der Skin Solutions Serie. Die 3-fach Pflanzenformel wird ergänzt mit Hyaluronsäure, Myo-Inositol und Fucose-Biopolymer, um die Wasserbindung zu fördern und somit die Haut mit Feuchtigkeit zu versorgen.
Von der Natur inspiriert, sanft und effektiv – das ist die Essenz aller Kräuterkosmetik-Produkte von Herbacin. Die kluge Kombination wertvoller, besonders wirksamer Wirkstoffe auf pflanzlicher Basis ist seit mehr als 100 Jahren das Rezept für den weltweiten Erfolg.

39 HAUTGESUNDHEIT Eine unabhängige Kampagne von Contentway
„Lösliche Ballaststoffe dienen zum Beispiel den gesundheitsfördernden Bakterien im Darm als Düngemittel.“
„Es ist nötig, ab einer gewissen Lebensphase, Mitte 35 und 45 Jahren, Instandhaltungsmaßnahmen durchzuführen.“
Dr. med. Yael Adler, Dermatologin, Ernährungsmedizinerin und Autorin
Mehr Informationen auf www.herbacin.com
Je älter, desto spermidinbedürftiger
ergänzung
Spermidine haben sich als AntiAging-Mittel einen großen Ruf erworben. Vor allem die Älteren unter uns können von seinen Wirkungen profi tieren
Text: Theo Hoff mann

Foto: Shutterstock
Viele Krankheiten bekämpft unser Körper mit komplexen Abwehrmechanismen. Aber hat er auch immer ausreichend körpereigene Mittel zur Verfügung, um Bakterien, Viren, Parasiten oder Pilze zu bekämpfen und seinen Vitamin- und Spurenelemente-Haushalt in Schuss zu halten? Und was ist mit unserem nicht zu unterschätzenden Aminosäure-Stoffwechsel? Wir müssen darauf achten, dem Körper die wichtigsten Stoffe über die Nahrung regelmäßig zuzuführen, um seinen Stoff wechsel und seine Leistungsfähigkeit zu fördern. Dabei werden wir immer wieder von Stoffen überrascht, die Wirkungen erzeugen, von denen wir bislang viel zu wenig wussten. Dazu gehört etwa das Spermidin, das sogar imstande ist, unsere Zellen gegen Demenz und Coronaviren zu schützen und als Anti-Aging-Mittel von zentraler Bedeutung ist. Wer bei dem ersten Teil des Wortes Spermidin nun gleich an Sperma denkt, liegt gar nicht so falsch. Es handelt sich dabei nämlich um basische Moleküle, die als biogene Polyamine sowohl in unseren Zellen selbst als auch in manchen Darmbakterien, vor allem aber in den männlichen Samenzellen vorkommen, die am meisten davon enthalten. Wir verfügen
darüber also bereits in unserem Körper, wir können es aber auch als Nahrungsergänzungsmittel oder in bestimmten Nahrungsmitteln zu uns nehmen. Reich an Spermidin sind etwa Käse, Pilze, Hülsenfrüchte, Äpfel, Grapefruit und Weintrauben.

In jüngster Zeit wurde die Wirkung von Spermidin in zahlreichen präklinischen Untersuchungen erforscht. Dabei erkannte man, dass Spermidin in unseren Zellen positive Wirkungen auf Alterungsprozesse, Übergewicht, Diabetes und das Immunsystem im Ganzen hat. Vor allem aber war man von den sogenannten kardioprotektiven Effekten dieses Polyamins überrascht, das sich förderlich auf die Gehirnfunktion und unsere kognitiven Fähigkeiten auswirkt. Wie wir wissen, weisen an Demenz erkrankte Patientinnen und Patienten Proteinablagerungen im Gehirn auf und man ist überzeugt, dass dies zu Zellschäden und am Ende zur Zerstörung der Zellen führen kann. Die Einnahme von Spermidin setzt genau dort an, wo ein Mangel an Aminosäuren diese Schäden auslöst und das Spermidin die sogenannte Autophagie induziert. Dahinter verbirgt sich ein zellulärer Recyclingprozess, mit dessen Hilfe schädliche Zellbestandteile abgebaut werden.
In Humanstudien konnte man nun zeigen, dass vermehrte Spermidinkonzentrationen im Blut von Probanden kognitiv leistungsfähiger machen können. Bei Seniorinnen und Senioren, die wegen einer Vorerkrankung oder auch erblich einem höheren Demenzrisiko ausgesetzt sind, konnte die künstliche Zuführung eines spermidinreichen Weizenkeimextrak-
tes über drei Monate zu einer deutlich verbesserten Gedächtnisleistung führen. Eine Studie an der FH Wiener Neustadt in Kooperation mit dem FAZ-Floridsdorfer Allergiezentrum belegte einen engen Zusammenhang zwischen dem Alter und einem sinkenden Spermidingehalt im Blut des Menschen. Das heißt, je älter wir werden, desto mehr Spermidin benötigen wir.
Wir dürfen vor allem im Umgang mit chronischen Erkrankungen, wie etwa Diabetes beim Einsatz von Spermidin natürlich keine Wunder erwarten. Was dieses Polyamin in unserem Körper aber zu leisten imstande ist, lässt sich kaum mehr von der Hand weisen.
fakten Spermidin unterstützt die Gesundheit unserer Zellen und soll gegen Demenz, Herzerkrankungen, Diabetes und sogar Coronaviren besondere Wirkung entfalten. Es kommt in unserer Nahrung vor, kann aber ohne zeitliche Beschränkungen auch als Nahrungsergänzung eingenommen werden.
Dr. Fritz Eichenseher
3Fragen an
Was genau verbirgt sich hinter dem Begriff „Staphylococcus aureus“? Staphylococcus aureus ist eine mit der menschlichen Nase und Haut assoziierte Bakterien-Spezies. In gesundem Zustand verursachen S. aureus keine Symptome, es kann aber bei Irritationen und Läsionen – wie sie bei Ekzemen oder Rosacea vorkommen – Rötungen und Juckreiz verursachen. S. aureus ist auch als Eiter verursachender Erreger bekannt. Schwerwiegende Infektionen können sogar in tödlichen Blutvergiftungen enden, insbesondere wenn es sich um antibiotikaresistente Stämme wie MRSA handelt.

Was begünstigt den Ausbruch von den mit dem Bakterium verbundenen Krankheiten? Wie können wir einer Infektion vorbeugen?
Wir sprechen von einem KolonisationsInfektions Kontinuum. Ist die Haut gereizt oder verletzt und wird die natürliche Schutzfunktion unterbrochen, ist es für die Bakterien leicht, sich zu vermehren. Eine entscheidende Rolle spielt auch ein gesundes Haut-Mikrobiom mit schützenden Mikroben.
Was hilft bei einer akuten Infektion? Gibt es konkrete und eff ektive Heilmethoden?
Bei akuten Infektionen sind Antibiotika nach wie vor das Mittel der Wahl, sie sind aber in ihrer Anwendung stark eingeschränkt und können Resistenzen verursachen. Bakteriophagen als die natürlichen Feinde der Bakterien bieten mit ihren Waffen den Endolysinen neue Möglichkeiten. Sie wirken hochspezifisch und auch gegen resistente Keime. Man kann sie über lange Zeit anwenden und sie eignen sich zur Prävention.
HAUTGESUNDHEIT Eine unabhängige Kampagne von Contentway 40
Wir müssen darauf achten, dem Körper die wichtigsten Stoff e über die Nahrung regelmäßig zuzuführen, um seinen Stoff wechsel und seine Leistungsfähigkeit zu fördern.
In Humanstudien konnte man nun zeigen, dass vermehrte Spermidinkonzentrationen im Blut von Probanden kognitiv leistungsfähiger machen können.
„In gesundem Zustand verursachen S. aureus keine Symptome, es kann aber bei Irritationen und Läsionen Rötungen und Juckreiz verursachen.“
Text: Nadine Wagner, Foto: Privat
Dr. Fritz Eichenseher, Chief Scientifi c O� cer Micreos Group




























N r.1
häufige Hautkrankheiten
Neurodermitis – frühe Qual
Die chronisch-entzündliche, nicht ansteckende Hauterkrankung nimmt ihren Anfang meist in den ersten beiden Lebensjahren. Betroffene leiden unter Hautausschlag an verschiedenen Körperstellen, der mit starkem Juckreiz einhergeht. Eine genaue Ursache der Neurodermitis konnte noch nicht identifiziert werden, offenbar wird sie von mehreren Faktoren begünstigt. Neben bestehenden Allergien, Umweltverschmutzung oder übertriebener Hygiene spielt auch erbliche Veranlagung eine Rolle. So weisen bestimmte Gene von Neurodermitikern Veränderungen auf. Allen Betroffenen gemeinsam ist eine gestörte Hautflora mit einer beeinträchtigten Schutzfunktion der Hornschicht.
Bei Erkrankungen im ersten Lebensjahr verwächst sich die Neurodermitis oftmals relativ schnell, wäh-
rend sie bei späterem Auftreten hartnäckiger sein kann. Manchmal kehrt sie auch im Erwachsenenalter zurück; Ersterkrankungen in diesem Alter sind dagegen selten. In der Regel verläuft die Erkrankung in Schüben, ausgelöst durch Trigger wie Stress, Infektionen, Textilien, schwüle Temperaturen oder Kälte. Auch Allergene wie Hausstaubmilben, Pollen und verschiedene Nahrungsmittel können Neurodermitis triggern. Durch Vermeidung dieser Auslöser, sorgfältige Hautpflege mit rückfettenden, feuchtigkeitsspendenden Produkten und mit Medikamenten lässt sich die Erkrankung meist gut in den Griff bekommen. Bei akuten Schüben hat sich Kortison, als Bestandteil von Cremes oder auch in Tablettenform, gut bewährt. Auch Lichttherapie oder Licht-Bade-Therapien können die Entzündungen wirksam lindern.
Hautinfektionen durch Staphylococcus aureus
Rötungen, Juckreiz und gespannte Haut können auch Anzeichen für eine Infektion der Haut mit dem Bakterium Staphylococcus aureus (S. aureus) sein. 30 Prozent der Menschen tragen diesen Keim in sich. Ist deren Immunsystem geschwächt, kann es – unter anderem – zu Erkankungen der Haut kommen. Hierbei gibt es verschiedene Formen unterschiedlichster Schweregrade – von kleinen Pickeln an Haarwurzeln über flache, gefüllte Blasen bis hin zu Eiterbeulen. Neugeborene kann es mit großflächigen Hautabschälungen besonders schwer treffen. All diese Formen sind stark ansteckend. Auch bei Neurodermitis, Akne und Rosacea spielt S. aureus eine wichtige Rolle. So lässt sich das Bakterium beispielsweise bei bis zu 90 Prozent der Neurodermitiker nachweisen, weswegen es
Rosacea – Entzündungen bei Erwachsenen


Die chronische, nicht ansteckende Entzündung der Gesichtshaut entwickelt sich in der Regel erst nach dem 30. Lebensjahr. Überdurchschnittlich betroffen sind Menschen mit heller Haut, insbesondere Frauen. Es gibt verschiedene Ausprägungen und Schweregrade sowie viele Mischformen von Rosacea. So können zusätzlich zur geröteten Gesichtshaut sichtbare kleine Äderchen, entzündliche Bläschen oder schmerzende Knötchen auftreten. Manchmal führt die Erkrankung auch zu knollenartigen Wucherungen an der Nase oder Entzündungen der Augen(lider). Viele Betroffene wissen nicht, dass es sich bei derartigen Symptomen um eine eigenständige, behandelbare Krankheit handelt. Deren Ursachen sind noch nicht abschließend geklärt. Neben Veränderungen der Blutgefäße sowie Immunreaktionen können auch Überempfindlichkeiten gegenüber Bakterien oder Milben eine Rolle spielen sowie erbliche Veranlagung. Auslöser von Entzündungssch-
üben können UV-Strahlen, starke Hitze oder Kälte, scharfe Gewürze, heiße Getränke, Alkohol sowie Stress sein. Neben deren Vermeidung tragen reizarme Hautpflegeprodukte dazu bei, Schüben vorzubeugen und Entzündungen zu lindern. Leichte Formen der Rosazea sprechen gut auf eine seifenfreie, sanfte Hautpflege mit niedrigem, leicht saurem pH-Wert an. Bei stärkeren Ausprägungen helfen Hautpflegeprodukte mit verschreibungspflichtigen Wirkstoffen. So hilft Brimonidin gegen Rötungen während Pusteln und Knötchen mit den Wirkstoffen Azelainsäure, Ivermectin oder Metronidazol zu Leibe gerückt werden. Reicht dies nicht aus oder sind auch die Augen betroffen kann eine zusätzliche Behandlung mit Antibiotika in Tablettenform ratsam sein.
Texte: Kirsten Schwieger
Fotos: Khoa Pham/unsplash Luca Morvillo/pexels Jenna Hamra/pexels
heute nicht mehr nur als verstärkender Faktor, sondern auch als einer von mehreren ursächlichen Neurodermitis-Faktoren betrachtet wird. S. aureus lässt sich mit Antibiotika behandeln, auch wenn eine Unterform des Keimes (MRSA) bereits gegen ein bestimmtes Antibiotikum resistent ist. Eine ebenso effiziente wie schonende Behandlung ist mit Hilfe von Bakteriophagen möglich, welche krankmachende Bakterien gezielt angreifen. So gibt es mittlerweile ein bestimmtes Enzym, das gezielt artspezifische Verbindungen in der Bakterienhülle von S. aureus eliminiert. Dieser Therapieansatz eignet sich besonders bei Neurodermitis, deren Erkrankungsdauer und wiederholte Schübe gegen die Antibiotikagabe sprechen.

HAUTGESUNDHEIT Eine unabhängige Kampagne von Contentway 42 3
Ideale Hautpflege-Routine
hautpflege
Gesunde, reine Haut ist das Ergebnis einer passgenauen und gewissenhaften täglichen Pfl egeroutine. Worauf es dabei ankommt.
Text: Kirsten Schwieger
Foto: Content Pixie/unsplash
Unser größtes Organ schützt uns vor Keimen und Schmutz, Umwelteinflüssen und UV-Strahlung, vor Austrocknung und schädlichen Substanzen. Um diese wichtige Barrierefunktion aufrechterhalten zu können, müssen wir unsere Haut schützen, stärken und pflegen. Eine effektive Hautpflege ist dabei immer auf den persönlichen Hauttyp abgestimmt.
Der erste Schritt einer wirksamen Hautpflege-Routine ist eine gründliche Reinigung des Gesichts, morgens und abends. Auf diese Weise werden Schmutz, Talg und abgestorbene Hautschuppen entfernt. Dermatologen empfehlen milde Reinigungsprodukte mit möglichst wenig Zusatzstoffen. Die Produktpalette ist riesig und unterscheidet sich in Konsistenz und Inhaltsstoffen. Es gibt Gele, Cremes, Lotionen, Milch, Balsam oder Tücher für die tägliche Gesichtsreinigung. Die


Wahl des Cleansers ist abhängig vom Hauttyp und von persönlichen Vorlieben. Die anschließende Anwendung eines Gesichtswassers (englisch: Toner) ist kein Muss, empfiehlt sich aber bei fettiger Haut. Gesichtswasser entfernen zusätzlichen Talg und bringen den pHWert der Haut wieder ins Gleichgewicht. Absolutes Muss am Abend vor der Reinigung ist ein gründliches Abschminken.
Im Anschluss an die Reinigung folgt die Hautpflege, denn Wirkstoffe können nur dann effektiv in die Haut eindringen, wenn diese sauber ist. Allen Hauttypen gemeinsam ist dabei die Versorgung mit Feuchtigkeit und der Schutz vor UVLicht. Für die morgendliche Routine ist eine Feuchtigkeitspflege mit Lichtschutzfaktor essenziell. Die konkrete Produktauswahl sollte auf Hauttyp und Alter abgestimmt sein, morgens wie abends. Bei trockener Haut um die Augenpartie empfiehlt sich zusätzlich eine reichhaltige Augencreme. Die abendliche Pflege darf etwas umfassender sein. Anstatt oder vor einer Nachtcreme mit reichhaltigen Inhaltsstoffen eignen sich insbesondere hochkonzentrierte Seren. Falls eine Augencreme hinzukommt, lautet die Reihenfolge: Serum, Augencreme, Nachtcreme. Ein bis zweimal pro Woche
empfiehlt sich die abendliche Verwendung eines auf den Hauttyp abgestimmten Peelings, eventuell ergänzt durch eine anschließende Gesichtsmaske.
Wer zu sehr trockener Haut neigt, muss diese nicht nur mit Feuchtigkeit, sondern auch mit Fett versorgen. Nach einer milden Reinigung sollten reichhaltige, hautschützende und rückfettende Pflegeprodukte zum Einsatz kommen. Beispielsweise eine Urea-haltige Creme am Morgen und ein hochwertiges Öl für die abendliche Gesichtspflege. Auch bei einer Neurodermitis ist es wichtig, die Haut mit rückfettenden und feuchtigkeitsbindenden Pflegeprodukten vor dem Austrocknen zu bewahren. Betroffenen werden zudem Reinigungsprodukte ohne Reiz- oder Duftstoffe mit niedrigem pH-Wert empfohlen. Bei fettiger, unreiner Haut empfehlen sich pH-neutrale, ölfreie Waschlotionen sowie ölfreie Pflegeprodukte auf Wasserbasis. Auch Make-up und Sonnenschutzmittel sollten möglichst fettfrei beziehungsweise „nicht komedogen“ sein – also keine Inhaltsstoffe beinhalten, die Mitesser verursachen könnten. Gegen Akne-Pickel empfehlen Dermatologen Präparate mit entzündungshemmenden Wirkstoffen wie Salicylsäure und Benzoylperoxid.
fakten
Gesunde Haut wird in vier, genetisch bestimmte, Hauttypen unterteilt: Normale, trockene, fettige und Mischhaut. Anders als der Hauttyp kann sich der Hautzustand im Laufe des Lebens verändern –beispielsweise durch hormonelle Veränderungen, Stress, Medikamente oder sogar jahreszeitenabhängig.
43 HAUTGESUNDHEIT Eine unabhängige Kampagne von Contentway ANZEIGE
fakten
Susanne Klehn liebt die Oper, die mit ihrer Gier nach Leben und der Sehnsucht nach Freiheit quasi das ganze Leben beinhaltet. Auf ihre täglichen 30 Minuten Yoga mag sie ebenso wenig verzichten, wie auf gelegentliche Fast-Food-Sünden bei ihrer ansonsten gesunden, aber undogmatischen Ernährungsweise

Zwischen Angst und Zuversicht

HAUTGESUNDHEIT Eine unabhängige Kampagne von Contentway 44
Susanne Klehn:
großes interview
Wie der Hautkrebs das Leben von Moderatorin Susanne Klehn verändert hat, was sie Betroffenen rät und warum Aufklärung im Kindesalter so wichtig ist.
Text: Kirsten Schwieger Foto: Presse
Wahrscheinlich hat Susanne Klehns Ex-Freund ihr seinerzeit das Leben gerettet. 2009, als sie mit 27 Jahren auf sein Anraten hin mit einem auff älligen Muttermal am Rücken zur Hautärztin ging. Fast mehr aus Eitelkeit, denn aus Sorge. Die Dermatologin entfernt die Stelle sicherheitshalber und schickt das Gewebe ins Labor. Zwei Tage danach, ein Freitag, dann ihr Anruf, dass sie noch keine Entwarnung geben könne, sondern weitere Laboruntersuchungen nötig seien. Montag wisse man dann mehr. „Das Wochenende war eine Achterbahnfahrt und als ich Montag um 9:00 ihre Nummer im Display sah, wusste ich, was sie mir sagen wird. Der 20-minütige Weg zu ihr war eine Tortur. Als sie mir dann die Diagnose mitteilte, malignes Melanom, also schwarzer Hautkrebs, war ich unter Schock“, erinnert sich die heute 42-Jährige. „Auch bei den nachfolgenden Untersuchungen dachte ich die ganze Zeit, das ist alles nur ein schlechter Traum, nicht mein Leben.“ Klehn wurde dann sofort an die Uni-Klinik Leipzig überwiesen, wo man ihr sehr sachlich eine 67-prozentige Überlebenschance im 10-Jahres-Verlauf prognostizierte. „Der Arzt wollte mir damit Mut machen, ich fand diese Zahl seinerzeit erschreckend niedrig!“
Aus der Rückbetrachtung rät sie Personen in einer solchen Situation dazu, was sie selbst seinerzeit nicht geschaff t hat: „Ruhig bleiben, nicht in Panik geraten und den Ärzten gut zuhören. Am besten nimmt man eine Bekannte, vielleicht auch vertrauensvolle Nachbarin, zu diesen Gesprächen mit, zum Mitschreiben. Nicht den Partner oder Familie,
Danke an alle, die helfen!
die sind ja selber total durch den Wind. Und ganz wichtig: Am besten schon im Erstgespräch nach psychoonkologischer Unterstützung fragen. Die steht einem nämlich zu, allerdings sind die hochbegehrten Plätze knapp, sodass dies nicht immer gleich von Arztseite angeboten wird.“ Außerdem empfiehlt die studierte Journalistin insbesondere jüngeren Patienten keine Scheu vor sozialer Beratung, Anschluss-Heilbehandlungen oder auch Behindertengrade zu haben: „Damit kann Geld gespart und die Arbeitskraft schneller wiederhergestellt werden.“
Sie selbst beginnt seinerzeit sofort eine 18-monatige Interferontherapie, eine Immuntherapie mit starken Nebenwirkungen. Dreimal die Woche muss sie sich selbst spritzen, weil nicht eindeutig war, ob der Krebs schon ins Blut- und Lymphsystem übergangen war. „Körperlich wie psychisch ging es mir sehr schlecht während dieser Zeit. Ich hatte regelmäßig Fieber, Gewicht verloren, schwere Depressionen und eine Riesenangst. Trotz der wahnsinnigen Angst hatte ich aber immer den Glauben, dass alles gut wird“, erinnert sich die erfolgreiche Promi-Moderatorin, die aufgrund der Erkrankung zwei Jahre lang nicht arbeiten konnte. Ihr Rat an Betroffene: „Informiert euch, zum Beispiel über die Ratgeber und Hotlines der Deutschen Krebshilfe, die haben mir seinerzeit sehr geholfen. Aber Finger weg von Doc Google und von Krebsforen, die sind viel zu emotional. Besser später einer Selbsthilfegruppe beitreten, aber keine Foren am Anfang und schon gar nicht in der Nacht!“


Rückblickend hat der Hautkrebs ihr Leben zum Positiven verändert. „Ich bin viel weicher geworden. Mit dem Bewusstsein der Endlichkeit kommt eine große Demut und viel Dankbarkeit. Ich bin zwar immer noch leistungsorientiert, aber mit einem viel größeren Respekt vor dem Leben, meinem Körper und meinem
Spermidin zur Unterstützung der Zellreinigung
mentalen Gerüst. Ich gehe bewusst mit meinen Ressourcen um – und mit der Sonne. Ich schütze meine Haut mit Sonnencreme und suche den Schatten, wo immer es geht, denn ich weiß, dass die Sonne zwar schön sein kann, aber auch eine nicht zu unterschätzende Gefahr.“
Das erzählt sie auch schon Kindergarten- und Schulkindern als Botschafterin für Hautkrebsprävention der Deutschen Krebshilfe. Die Aufklärung zur Vermeidung dieser Krebsart bereits im Kindesund Jugendalter bedeutet ihr sehr viel. „Mir geht das Herz auf, wenn ich sehe, wie schon die Kleinsten erklären können, warum zu viel Sonne und Solarium schädlich sind. Das ist gelerntes Verhalten, das Leben retten kann.“
Herr Dr. Hartig, was hat es mit dem viel beschworenem Spermidin auf sich?
Spermidin ist das Top-Thema in Wissenschaft und Forschung. Das natürliche Polyamin kommt in jeder Körperzelle vor. Es ist wissenschaftlich belegt, dass Spermidin den Prozess der Zellreinigung und -regeneration anregt. Dieser Autophagie genannte Prozess sorgt dafür, dass beschädigte oder nicht mehr benötigte Zellstrukturen in kleinere Bestandteile zerlegt werden, die dann wiederverwertet oder abgebaut werden. Dieses molekulare Selbstreinigungsprogramm schaff t ein Gleichgewicht und schützt vor vielen Krankheiten. Ohne diesen Prozess käme es zu einer „Vermüllung“ unseres Körpers. Leider lässt im Alter die Autophagie nach, weshalb Spermidin unbedingt zugeführt werden sollte. Es kann dabei unterstützen, die körpereigene Zellreinigung besser zu erhalten. Davon profi tieren auch Haut, Haare und Nägel, indem deren Wachstum und Regeneration gefördert werden. Unser fl üssiges, hochdosiertes Spermidin ist micelliert, mit wasserlöslichen Molekülen ummantelt, sodass es direkt in die Blutbahn gelangt.
Und wie geht es ihr heute, ist die Angst verschwunden? Klehns Antwort kommt ohne zu zögern: „Zuallererst: Ich hab jetzt nicht die ganzen zehn Jahre meiner prognostizierten Überlebenschance Angst gehabt. Aber um den Jahrestag meiner Diagnose ist mir schon regelmäßig mulmig zumute gewesen. Nach Ablauf der zehn Jahre war ich dann auch ziemlich erleichtert. Mit dem Erreichen der 40 hat sich jedoch wieder ein etwas ängstlicheres Mindset eingeschlichen. Die Prädisposition für Hautkrebs ist halt gegeben und ich bin eben nicht mehr 27. Umso mehr freue ich mich über jeden neuen Morgen und genieße das Leben in seinen kleinen und großen Glücksmomenten!“ ANZEIGE
Text: Kirsten Schwieger, Foto: Presse
Nothilfe Ukraine – jetzt spenden!
Seit über einem Jahr herrscht Krieg mitten in Europa. Millionen Familien aus der Ukraine bangen um ihr Leben und ihre Zukunft. Aktion Deutschland Hilft, das Bündnis deutscher Hilfsorganisationen, leistet den Menschen Nothilfe.
Danke für Ihre Solidarität. Danke für Ihre Spende.
Jetzt Förderer werden: www.Aktion-Deutschland-Hilft.de

45 HAUTGESUNDHEIT Eine unabhängige Kampagne von Contentway
„Ich schütze meine Haut mit Sonnencreme und suche den Schatten, wo immer es geht, denn ich weiß, dass die Sonne zwar schön sein kann, aber auch eine nicht zu unterschätzende Gefahr.“
© AWO International/Markus Korenjak
Dr. Peter Hartig, Mikrobiologe, Unternehmer und Autor
Zartes Sensibelchen
hautpfl ege



Sensible Haut kann viele Gesichter haben und noch mehr Ursachen. Wie man ihr vorbeugen, auf die Schliche kommen und sie behandeln sollte.
Text: Kirsten Schwieger
Foto: Karolina Grabowska/pexels
Immer mehr Menschen leiden Dermatologen zufolge unter sensibler Haut. Das komplexe und deshalb schwer diagnostizierbare Phänomen hat verschiedenste Ausprägungen und wahrscheinlich noch mehr Ursachen – welche nicht immer erkennbar sind. Sensible oder überempfi ndliche Haut äußert sich durch Rötungen, Spannungs- oder Brenngefühl, Juckreiz, Entzündungen und auch Pusteln.


Eines scheinen alle Betroffenen gemeinsam zu haben: Eine Einschränkung der natürlichen Barrierefunktion ihrer Haut in deren Folge diese an Feuchtigkeit verliert. Äußere Reizstoffe können so schneller eindringen und Irritationen auslösen. So können beispielsweise UV-Strahlung, Abgase oder auch Medikamente im Körper hochreaktive Sauerstoff verbindungen, sogenannte ‚Freie Radikale‘ entstehen lassen. Die Folge davon ist oxidativer Stress, welcher Zellschäden verursachen und die natürliche Schutzfunktion der Haut beeinträchtigen kann. Neben Schad- und Zusatzstoffen in Luft, Kosmetik oder Reinigungsmitteln können auch Umwelteinflüsse wie Hitze oder Kälte, Sonne oder Wind sowie psychischer Stress, Alkohol und Nikotin die Haut stressen. Manchmal löst auch
eine Allergie gegen einen Inhaltsstoff in Kosmetik oder Nahrungsmitteln das Hautphänomen aus. Nicht selten ist es auch einfach ein „zu viel des Guten“ im Rahmen der täglichen Hautpflege.
Vorbeugen lässt sich sensible Haut durch weitgehendes Vermeiden von Auslösern und durch die Verwendung sanfter Pflegeprodukte mit möglichst wenigen Inhaltsstoffen. Auch eine gesunde Ernährung arbeitet für die Haut – so schützen beispielsweise die Vitamine A, C und E die Hautzellen vor oxidativem Stress. Dieselbe Strategie liegt auch der Behandlung sensibler Haut zugrunde, weswegen es auch hilfreich ist, die Ursachen der überempfi ndlichen Haut zu kennen. Grundsätzlich empfehlen sich feuchtigkeitsreiche Produkte, die schnell in die Haut einzie-
hen. Zwar gibt es seit geraumer Zeit eine entsprechende Kategorie bei Hautreinigungs- und Pflegeprodukten, allerdings sind Deklarationen wie „sensitiv“ oder „für empfi ndliche Haut“ ungeschützte Werbeaussagen. Die Kennzeichnung „hypoallergen“ bedeutet lediglich, dass ein Produkt nicht allergieerzeugend sein soll. Auch mit Naturkosmetik ist man nicht grundsätzlich auf der sicheren Seite, denn auch pfl anzliche Wirkstoffe können Irritationen hervorrufen.






So empfi ehlt sich in der Regel ein genauer Blick auf die Liste der Inhaltsstoffe. Wirkstoffe wie Urea, Dexpanthenol, Nachtkerzen- oder Arganöl, Kamille, Hyaluronsäure, Aloe Vera und Hamamelis beruhigen gestresste Haut und unterstützen deren natürliche Schutzfunktion. Gemieden werden sollten dagegen Duft-, Konservierungs- und Farbstoffe, denaturierter Alkohol, Natriumlaurylsulfat sowie PEG-Emulgatoren. Gesundheitsgefährdende Parabene, Phtalate, Phenoxyethanol, Silikone und Mikroplastik selbstredend ebenso. Auch von Fruchtsäuren sowie generell starken Peelings sollten Betroffene besser die Finger lassen. An Retinol kann sich eventuell vorsichtig herangetastet werden.
fakten
Als größtes Sinnesorgan ist die Haut unzähligen schädlichen Substanzen direkt ausgesetzt. Zwar ist das Hautmikrobiom als Schutzbarriere gegen unerwünschte Eindringlinge angelegt, doch kann es dieser Aufgabe nur nachkommen, wenn dort ein Gleichgewicht zwischen „guten“ und „schlechten“ Mikroorganismen herrscht. Ist die Balance gestört, reagiert die Haut sensibel auf Umwelteinflüsse und Inhaltsstoffe von Kosmetik und Lebensmitteln.
Pur und einfühlsam
Die HILDEGARD BRAUKMANN SOLUTION Serie lässt gestresste Haut zur Ruhe kommen und bringt sie mit hochwertigen Wirkstoffen Schritt für Schritt wieder in Balance. SOLUTION ist hochwirksam bei Hautproblemen und wird besonders für sehr sensible, trockene oder gereizte Haut empfohlen.
Frei von: Paraben, PEG, Silikon,Mikroplastik,synthetischen Farbstoffen und Mineralöl.


HILDEGARD BRAUKMANN Kosmetik GmbH & Co. KG
Ehlbeek 16 · 30938 Burgwedel · T +49 (0)5139 8974-410/-411 b eratung@hildegard-braukmann.de · www.hildegard-braukmann.de



HAUTGESUNDHEIT Eine unabhängige Kampagne von Contentway 46
ANZEIGE
Bei sensibler Haut sollte möglichst auf Pfl egeprodukte mit Duftstoff en und Farbstoff en verzichtet werden.
HB_Anz_SOLUTION_Die Welt_248×121_1/3Seite_08_2022_final.indd 1 01.09.22 10:33
So funktioniert Well-Aging
well-aging
Dermatologin Dr. Miriam Rehbein über verkapselte Vitamine, fragmentiertes Hyaluron sowie weitere BeautyHacks und den Goldstandard im Anti-Aging

Text: Kirsten Schwieger
Fotos: Presse, Nati Melnychuk/unsplash
beginnt die Haut bereits mit Mitte 20 zu altern – dann lässt die Kollagenproduktion nach und die Haut speichert nicht mehr so viel Feuchtigkeit.
Welches sind die eff ektivsten WellAging Wirkstoff e und wie wirken sie?
Man muss ganz klar sagen, es gibt gar nicht so viel, was wirklich studienbasiert funktioniert. Der Goldstandard im Anti- oder Well-Aging ist Retinol, also Vitamin A1. Da weiß man einfach, dass es wirklich die Kollagenbildung und den Zellzyklus wieder anregt und auf diese Weise das Hauptbild langfristig verschönert. Hyaluronsäure funktioniert in Injektionsform auch hervorragend, weil es die Feuchtigkeit schön speichert. Antioxidantien, also die Vitamine A, C, E, D, B6 und B12 in Cremes sowie unserer Ernährung sind ebenfalls wichtig, weil sie dafür sorgen, dass unsere Zellen
freie Radikale bekämpfen, also Oxidationsprozesse aufhalten können, die eine große Rolle beim Alterungsprozess spielen. Und natürlich Lichtschutzfaktor, einer der wichtigsten Anti-Aging-Wirkstoffe überhaupt. Von den Dingen, die man noch zusätzlich machen kann, funktioniert Botox, weil es die Muskulatur entspannt und dafür sorgt, dass die Falten nicht so schnell erscheinen.
Was macht ein gutes Hautpfl egeprodukt aus?
Hochdosierte Wirkstoffe von guter Qualität in intelligenten Wirkstoff kombinationen – unter einem Prozent macht alles keinen Sinn. Neben der Dosierung ist auch die Wirkstoff aufbereitung von Bedeutung. So macht es beispielsweise einen Unterschied, ob Vitamine einfach so in purer Form in der Creme liegen oder verkapselt. Unverkapselt sind sie
nämlich der Oxidation ausgesetzt und verflüchtigen sich schnell bei Kontakt mit UV-Licht und Sauerstoff . Hyaluronsäure dagegen kann in Cremes nur in fragmentierter Form in die Haut eindringen und dort Feuchtigkeit binden. Das Molekül der klassischen Hyaluronsäure ist viel zu groß, um in die Haut zu gelangen, sondern bindet auf der Hautoberfl äche Wasser. Das gibt einen kurzzeitigen Wow-Effekt, der auch nach hinten losgehen kann. Den Zellen wird suggeriert, genug Feuchtigkeit zu haben, weswegen sie dann selber weniger produzieren.

Gibt es erprobte Power-Kombinationen?
Wie lässt sich der natürliche Alterungsprozess der Haut verlangsamen?
Durch eine nährstoff reiche Ernährung, Verzicht auf Toxine wie Nikotin und Alkohol und natürlich durch Meidung von Sonneneinstrahlung beziehungsweise Sonnenschutz. Eine gute Hautpflege berücksichtigt den individuellen Hauttyp, schützt die Hautbarriere und enthält Anti-Aging-Wirkstoffe in guter Qualität und geeigneter Konzentration. Übrigens
Neben der Dosierung ist auch die Wirkstoff aufbereitung von Hautpflegeprodukten von Bedeutung.
AGE ELEMENT: Schönheit in jeder Lebensphase
Neue Anti-Aging-Lösungen für zu Hause mit patentierter epigenetischer Wirksamkeit.
Im Laufe der Jahre altert die Haut. Die Genetik kann einen Teil dieses Prozesses erklären. Mehr als 80 % der Hautalterung wird jedoch durch Umweltbedingungen, Lebensstil und Emotionen verursacht. Diese Faktoren begünstigen die Aktivierung epigenetischer Marker und werden so zu den Hauptbeschleunigern der Hautalterung. Nach jahrelanger Forschung hat mesoestetic® mit age element® eine Lösung entwickelt, die auf diese verantwortlichen epigenetischen Marker einwirkt. Dadurch kann den Zeichen der Hautalterung entgegengewirkt und die Schönheit in jeder Lebensphase verbessert werden.
Die Zeichen der Hautalterung treten nicht allein auf. Deshalb hat das pharmazeutische Labor von mesoestetic Produkte und Formeln entwickelt, die
kombiniert werden können, um eine synergetische und ergänzende Wirkung zu erzielen: Sie ermöglichen es, das Hauptproblem zu behandeln und anderen Alterungsproblemen vorzubeugen oder diese zu verbessern. Dadurch ist die Anti-AgingPflege zu 100 % personalisierbar.
www.mesoestetic.de

Eine super Kombi ist mit Sicherheit Retinol, höhere Säurefragmente, kleinfragmentiertes Oligo-Hyaluron und Wirkstoffe aus der Neurodermitis-Forschung wie ProRenew Complex und Ectoin. Letztere stärken die natürliche Hautbarriere und in Kombination mit zellerneuerndem Retinol lässt sich quasi von innen und außen an einem schönen, elastischen Hautbild arbeiten.
Welche minimal-invasiven Behandlungen empfehlen Sie wofür?
Das lässt sich nicht pauschal sagen, das sind wirklich individuelle Entscheidungen. Wer unter Volumenverlust im Gesicht oder einer eingefallenen Wangenpartie leidet, kann diese Bereiche mit Hyaluronsäure-Fillern auff üllen lassen. Stört eine tiefe Zornesfalte, dann ist Botulinumtoxin der richtige Approach. Wer das Hautbild insgesamt unterstützen und straffen möchte, kann das mit Needling, Vampire Lifting, Radiofrequenz- oder Laser-Straff ung machen lassen. Ich persönlich bin ein großer Freund von Hautbildoptimierung, denn ein ebenmäßiger, feinporiger Teint lässt uns zehn Jahre jünger aussehen.
age element® umfasst drei Produktlinien für verschiedene Lebensphasen, die alle eine epigenetische Anti-Aging-Wirkung und ein breites Spektrum an Antioxidantien haben, die das Gewebe vor äußeren Einfl üssen schützen:
1. „Brightening Solutions“ für eine strahlendere Haut bei jüngerer Haut
2. „Firming Solutions“ für ein festeres, glatteres und definierteres Gesicht bei


3. „ Anti Wrinkle Solutions“ für eine glattere und voluminösere Haut bei reifer Haut

47 HAUTGESUNDHEIT Eine unabhängige Kampagne von Contentway
Eine gute Hautpflege berücksichtigt den individuellen Hauttyp, schützt die Hautbarriere und enthält Anti-AgingWirkstoffe in guter Qualität und geeigneter Konzentration.
Dr. med. Miriam Rehbein, Fachärztin für Dermatologie
ANZEIGE – ADVERTORIAL
Beauty-Hacks und Produkttests hautnah
einblick
Özlem Alarslan, besser bekannt als Elanhelo“, testet auf Instagram, TikTok und YouTube u. a. diverse Beauty-Produkte und klärt über Beautymythen auf.

mit dem jeweiligen Primer machen. So gibt es eigentlich für jede Haut und jedes Hautproblem einen passenden Primer, damit das Make-up besser funktioniert. Welche Kaschiertipps hast du auf Lager?
Zum Kaschieren nutze ich persönlich gerne Color Correcting, also Farbkorrekturen mit entgegengesetzten, ausgleichenden Farben. So lassen sich Augenringe beispielsweise gut mit Rosé-stichigen Produkten abdecken während Grün Hautrötungen, Äderchen oder Pickel super neutralisiert.
Wie gehst du bei deinen Produkttests vor?
Die Kopfhaut milde stimmen
haarpflege
Deine Tipps für gesunde, schöne Haut?

Äußerlich ist eine hauttypgerechte, sorgfältige Pflege wichtig – in angemessenem Umfang. Innerliche Faktoren sind sicherlich eine gesunde Ernährung, ausreichend Flüssigkeit und Schlaf.
Welchen Stellenwert besitzt die Hautreinigung?
Schöne, gesunde Haut beginnt schon bei der Reinigung – morgens und abends. Morgens reicht es oft, das Gesicht lediglich mit Wasser zu reinigen. Abends nutze ich zur Reinigung aber gerne zusätzliche Produkte; das ist jedoch immer individuell. Make-up, abgestorbene Hautzellen und Schmutzpartikel müssen dabei möglichst gründlich entfernt werden, ansonsten bleiben Reste übrig, die dann die Haut reizen oder zu Unreinheiten führen können. Ich persönlich bin durch eine Kooperation im koreanischen Pflegebereich ein totaler Fan von „Double Cleansing“ geworden. Das hat meinen ganzen Hautpflegeprozess massiv verändert, weil ich wirklich einen deutlichen Unterschied gemerkt habe, wie meine Haut danach Pflegeprodukte aufnimmt und welche Ergebnisse ich damit erzielen kann. Seitdem benutze ich auch einen Toner vor meiner Tages- und Nachtpflege.
Welches Make-up für welche Haut?
Also das kommt natürlich immer auch ein bisschen auf die persönlichen Vorlieben an. Grundsätzlich würde ich aber bei fettiger Haut mit Puderprodukten arbeiten und bei trockener Haut mit flüssigem Make-up. Da kann man aber auch viel
Bei manchen Produktkategorien wie beispielsweise Deos kann ich mir schon nach drei bis vier Anwendungen ein Urteil bilden, während ich bei Gesichtspflegeprodukten meist mehrere Wochen dran bin, um zu entscheiden, ob das Produkt etwas taugt. Entweder empfehle ich es dann oder berichte von den Problemen, die ich damit hatte. Von den Followern, welche die Produkte dann ausprobieren, bekomme ich interessanterweise zu 80 Prozent ein übereinstimmendes Feedback. Rund 75 Prozent der getesteten Produkte kaufe ich selbst, der Rest sind Kooperationen. In sieben Jahren habe ich mir auf diese Weise eine Followerschaft von 1,5 Millionen Followern über all meine Kanäle hinweg aufgebaut.
Was ist mit dem Thema Nachhaltigkeit, bei hunderten Produkttests pro Jahr?






Ich gebe die Verpackungen – sobald ich mir eine Meinung bilden konnte – zum Aufbrauchen in mein Umfeld weiter. Das gibt mir sowohl inhaltlich Feedback als auch die leeren Verpackungen zurück, sodass ich sie für Videos benutzen beziehungsweise ins Recycling geben kann. Ich kenne keinen Influencer, der bei dieser Masse an Tests so nachhaltig mit den Produkten verfährt.
Dejan Garz begeistert mit Haarpflege-Tipps fast 300.000 Follower bei Instagram. Im Interview spricht der Hamburger Friseurmeister über die optimale Pflege von Haut & Haar.

bleme machen. Man kann seine Haare auch mit einem milden Gesichts-Cleanser waschen, denn Haare waschen dient in erster Linie dazu, die Kopfhaut von Fett zu befreien. Außerdem wichtig: Kopfhaut nicht zu heiß föhnen und im Sommer auf UV-Schutz achten!

Welche Kopfhaut-bedingten Haarprobleme plagen deine Follower?



ENTSPANNUNG FÜR DIE KOPFHAUT
Die Basis für schönes Haar ist eine gesunde Kopfhaut – warum?
Alles, was mit dem Haarwachstum zu tun hat, entspringt in der Kopfhaut. Eine atmungsaktive Kopfhaut mit intaktem Säureschutzmantel sorgt für gesundes Haarwachstum. Die restlichen 50 Prozent von schönem Haar macht in meinen Augen eine gute Haarpflege aus.
Wie sieht optimale Kopfhaut-Pflege aus?
Das A und O ist eine milde Haarwäsche, welche die Kopfhaut nicht reizt und die Haarfollikel nicht verstopft. Parfümfreie Shampoos mit möglichst wenigen Zusatzstoffen sind ideal, die tägliche Haarwäsche eher nicht so. Problematisch sind Shampoos mit Silikonen, da diese komedogen wirken, also die Poren verstopfen. Auch Trockenshampoo kann Pro -


Schuppen sind definitiv ein großes Thema, wobei hier unterschieden werden muss zwischen trockenen und fettigen Schuppen. Diesbezüglich bin ich ein großer Fan von chemischen Peelings mit Säuren, die direkt in die Haut einziehen und deren pH-Wert beeinflussen. Bei fettiger Kopfhaut beziehungsweise fettigen Schuppen empfehle ich Salicylsäure, auch bekannt unter BHA. Trockenen Schuppen lässt sich mit AHA-Fruchtsäuren sanft zu Leibe rücken. Einmal die Woche ein chemisches Peeling ist auch eine gute Prophylaxe. Von mechanischen Kopfhaut-Peelings rate ich eher ab, weil der Schleifeffekt die Kopfhaut reizt.
Was ist mit Bürstenmassagen?

Ich bin ein absoluter Befürworter von Massagebürsten zum Haarewaschen. Sie regen die Blutzirkulation der Kopfhaut an, wodurch Nährstoffe besser zum Haarfollikel transportiert werden können. Wichtig ist, dass diese Bürsten spitz geformte, aber gleichzeitig auch weiche Noppen besitzen.

HAUTGESUNDHEIT Eine unabhängige Kampagne von Contentway 48 ANZEIGE
Text: Kirsten Schwieger Fotos: Presse Kevin Laminto/unsplash
Text: Kirsten Schwieger Fotos: Presse Karolina Grabowska/pexels
„Bei fettiger Kopfhaut beziehungsweise fettigen Schuppen empfehle ich Salicylsäure, auch bekannt unter BHA.“
Für fettige Haut eignet sich ein leichtes, antibakterielles Reinigungsgel.
Ein Peeling alle 2 bis 3 Wochen sorgt für eine bessere Durchblutung und befreit die Kopfhaut von abgestorbenen Rückständen.
Özlem „Elanhelo“ Alarslan, Influencerin zu finden unter instagram.com/elanhelo
Dejan Garz, Friseurmeister zu finden unter instagram.com/dejangarzhairstylist.
All you need is...
...eine strahlende und gesunde Haut. Unser größtes Sinnesorgan bedarf mehr Aufmerksamkeit, als manch einer denkt. Von der Reinigung über die Pfl ege, bis hin zum Schutz – diese sieben Produkte tragen zu einem strahlenden Teint bei und sorgen für ein gesundes Hautbild.
Aloe Ferox – Gesichtspflege reinigt, pflegt & schützt Anti-Aging für eine überzeugende Ausstrahlung
UVP: Ab 38,50 EUR www.alveroa.de
Hochwirksame Pflege aus dem hohen Norden: Ultra Booster Premium Effect Cream Tag SPF 20 von La mer




UVP: 50ml - 109,00 € Refill 50 ml - 95,00 € www.la-mer.com











ha densimatrix ist ein Serum aus Hyaluronsäure in verschiedenen Molekülformen und einem anti-hyaluronidase-complex.

UVP: 91,90 EUR www.silkmed-distribution.de




Vegane Skincare aus Hamburg. Naturreine Öle – ganzheitliche Pflege mit Aromatherapie!
UVP: 29-79 EUR www.hello-sue.com
Das POJ® Hyaluron Serum glättet und straff t die Haut optisch mit einem sofort wahrnehmbaren Effekt.
Preis: 59,95 EUR www.thorstmanncosmetics.de













Du bist perfekt! Deine Haut wird’s auch! Die handgefertigte Ziegenmilchmaske Secret Teint von pin up Secret Teint Précieux ist ein antibakterielles Schönheitselixier, unisex, für jedes Alter – ein Allroundtalent, das Unreinheiten beseitigt, die Überproduktion von Talg verhindert und selbst Pigmentflecken und Narben vermindert.
UVP: 26-32 EUR




























www.pinup-secret.de instagram: @pinupsecretberlin
All diejenigen, die auch ohne erste Sonnenbäder auf schöne Bräune nicht verzichten möchten, können jetzt aufatmen. Das leichte Selbstbräunungsmousse
M. ASAM® TRANSPARENT SELF TANNING MOUSSE schenkt binnen 3-5 Stunden makellos gebräunte Haut ohne Abfärben. Die transparente und parfumfreie Textur bräunt nicht nur schön gleichmäßig sondern spendet der Haut mit einem Mix aus beruhigender Aloe Vera und erfrischendem Kokoswasser zusätzlich eine Extraportion Feuchtigkeit.





Inklusive Applikation-Handschuh, UVP: 29,99 EUR




Mehr Info: www.asambeauty.com
Sie möchten mit den richtigen Inhalten Ihre Markenbekanntheit erhöhen und mehr potenzielle Kunden erreichen? Kontaktieren Sie uns! www.contentway.de |
40 87 407 400

49 HAUTGESUNDHEIT Eine unabhängige Kampagne von Contentway
ANZEIGE
Wir bringen Ihre Marke zur relevanten Zielgruppe.
info@contentway.de
+49
|
Gemeinsam für ein rückengesundes Leben
einleitung
Rückenschmerzen sind das Volksleiden Nummer eins. Die gute Nachricht: Über 90 Prozent aller Beschwerden sind harmlos. Trotzdem sollten Betroffene Rückenschmerzen nicht auf die leichte Schulter nehmen und als Weckruf verstehen, ihren Alltag rückengerechter zu gestalten. Wir als Aktion Gesunder Rücken e. V. geben Tipps, damit es gar nicht erst soweit kommt. Unser Ziel ist es, dass Menschen ihren Alltag so rückenfreundlich wie möglich gestalten können. Wir sind die erste Anlaufstelle bei Fragen rund um das Thema Rückengesundheit und bieten mit dem AGR-Gütesiegel eine Orientierung beim Kauf ergonomischer Produkte.
Foto: AGR
Warum schmerzt der Rücken?
Rückenschmerzen können körperliche sowie psychische Ursachen haben. Der häufi gste Grund sind Muskelverspannungen. Durch einseitige Belastung, Fehlhaltung und Bewegungsmangel verspannen und verkürzen sich die Muskeln. Häufi g reagieren wir darauf mit einer Schonhaltung. Diese führt wiederum dazu, dass andere Muskelgruppen angespannt und überlastet werden. Mit moderater Bewegung können verhärtete Muskeln aber wieder aktiviert werden, was die Durchblutung fördert und Verspannungen löst.
Erste Hilfe bei akuten Rückenschmerzen
Trotz Beschwerden ist es wichtig, so gut es geht in Bewegung zu bleiben! Gehen Sie möglichst mehrfach am Tag ca. 15 Minuten spazieren oder fahren Sie entspannt R ad. Längeres Liegen oder Sitzen sollte hingegen vermieden
werden. Akute Schmerzen können durch Wärmeanwendungen, Massagen und einfache Schmerzmittel gelindert werden. Halten die Schmerzen länger an oder Ausfallerscheinungen wie Kribbeln in den Beinen kommen hinzu, sollte auf jeden Fall ein Arzt konsultiert werden.
Beschwerden nicht auf die lange Bank schieben! Viele Rücken-Geplagte haben große Angst vor bleibenden Beschwerden. Glücklicherweise gilt in den meisten
Fällen: Aus ak uten Schmerzen müssen keine chronischen werden! Betroffene können selbst viel tun, damit die Beschwerden schnell wieder abklingen. Wichtig ist, dass sie frühzeitig geeignete Maßnahmen ergreifen.
Prävention: 4 Tipps für einen starken Rücken
1.Bringen Sie mehr Bewegung in Ihren Alltag: Vor allem langes Sitzen führt zu verspannter Muskulatur. Spaziergänge in der Mittagspause, Radfahren zur Arbeit oder Treppengänge statt Fahrstuhlfahrten eignen sich dafür perfekt. Auch kleine Lockerungsübungen am Arbeitsplatz sind empfehlenswert. Passende Rückenübungen fi nden Sie unter: www.agr-ev.de/rueckenuebungen
2. Rückenfreundliches Umfeld schaff en: Ergonomische Produkte leisten einen wesentlichen Beitrag zur Rückengesundheit. Diese gibt es mittlerweile für nahezu jeden Lebensbereich. Ein wichtiger Bestandteil der Arbeit der Aktion Gesunder Rücken e. V. ist die Vergabe des AGR-Gütesiegels, mit dem besonders rückengerechte Alltagsgegenstände durch ein medizinisches Gremium ausgezeichnet werden. Mehr dazu lesen Sie unter: www.ruecken-produkte.de
Detlef Detjen, Geschäftsführer der Aktion Gesunder Rücken e. V.

Weitere ausgewählte Produkte mit dem AGR-Gütesiegel fi nden Sie in dieser Kampagne.
3. Stress vermeiden: Negativer Stress lässt die Muskeln verspannen und begünstigt oft Rückenschmerzen. Wertvolle Hilfe bieten hier einfache Anti-Stress-Techniken wie Atemtechniken oder autogenes Training.

4. Ausgewogen ernähren: Eine eiweiß-, vitamin- und mineralstoff reiche Ernährung fördert den Muskelaufbau, stärkt die Knochen und versorgt die Bandscheiben mit Flüssigkeit.
Tag der Rückengesundheit
Jedes Jahr am 15. März veranstalten wir gemeinsam mit dem Bundesverband deutscher Rückenschulen e. V. den Tag der Rückengesundheit.
Dazu fi nden sowohl regional als auch online viele Veranstaltungen und Aktionen statt, in denen Ihr Rücken im Mittelpunkt steht. Alle weiteren Informationen fi nden Sie auf www.agr-ev.de/tdr


Hasta la vista, Rückenschmerzen!
Unsere Arbeitswelt findet sich häufig sitzend, meist vor dem Bildschirm oder in Zwangshaltungen in Produktion oder Dienstleistung wieder. Dies führt zu typischen Beschwerdebildern im Bereich der Wirbelsäule, den Extremitäten, zu Kopfschmerzen sowie zu Schlafstörungen.
Studien zeigen, dass 6 von 10 der Mitarbeiter:innen ein bis mehrmals pro Woche an Verspannungen leiden, mit negativen Auswirkungen auf Lebensqualität und Leistungsfähigkeit. Rückenschmerzen sind bereits Ursache für fast jeden vierten Krankenstandstag und die zweithäufigste Einzeldiagnose für Krankschreibungen.
Verspannungsschmerzen – Was verursacht sie?
Die Antwort liegt in den Faszien: Sie verfilzen, ähnlich Haaren, die nicht regelmäßig gebürstet werden. Faszien sind ein komplexes Netzwerk in unserem Körper und spielen bei der Schmerzentstehung eine zentrale Rolle. Durch Stress, eine falsche Körperhaltung oder mangelnde Bewegung verlieren Faszien an Elastizität und verkleben. Dies kann zu komplexen inneren Verspannungen bis hin zu chronischen Schmerzen führen.
Um dem entgegen zu wirken hat ErgoPhysion das Rückentherapiegerät „TensionTerminator“ evidenzbasiert aus dem Praxisalltag der Physiotherapie heraus entwickelt. Dieses zertifizierte Medizinprodukt ermöglicht die Anwendung der effektivsten Therapietechniken direkt am Arbeitsplatz und beugt so Rückenschmerzen vor.

Faszienpflege ist das neue Zauberwort
Auch Faszien brauchen Pflege. Der Triggerpunkthebel des „TensionTerminator“ ermöglicht eine therapeutische Intervention und löst Verspannungen mit dem nötigen punktuellen Druck auf. Die höhenverstellbaren DuoBälle sind ideal zum Lösen flächiger Verklebungen. So bleiben die Faszien geschmeidig, die Nährstoffzufuhr und das Ausleiten von Schlackenstoffen werden optimiert.
Die Verspannungsschmerzen und deren Folgeerscheinungen verbessern sich in kürzester Zeit signifikant.
Entspannt in den Feierabend Selbsterklärend und sicher in der Anwendung können Rückenschmerzen unmittelbar gelindert werden. Bei niederschwelligem Zugang wird der „TensionTerminator“ dankbar angenommen. Wohlbefinden, Lebensqualität und Arbeitsleistung steigen nachhaltig.
Die Ergebnisse1 zeigen: „Rückenschmerzen muss nicht sein“
RÜCKENGESUNDHEIT Eine unabhängige Kampagne von Contentway 50
1Studie: Tirol Institut für Qualität im Gesundheitswesen 2020-21 (N=300)
auch Sie aktiv zur Rückengesundheit bei: www.ergophysion.com/tt ADVERTORIAL
Das Bild der Painmap zeigt die Hauptschmerzzonen. Es stammt aus der Anwendungsstudie1 TiQG 2020-21, in der über 300 Personen angegeben haben wo sie Verspannungsschmerzen haben.
Tragen
TensionTerminator
„TensionTerminator“, der Verspannungs-Befreiungs-Assistent für den Einsatz in Unternehmen, Hotels und Zuhause.
„Wie Sie durch einen Fitnesspark auf dem Betriebsgelände Mitarbeiter binden und sich durch gezieltes Employer Branding als attraktiver Arbeitgeber auf dem Markt platzieren!“

CustomBars® GmbH
Cirksena Straße 46 26723 Emden
Telefon: 04921/ 906 2653
E-Mail Adresse: info@custombars.de

Fitnessparks für Unternehmen: nicht von der Stange www.custombars.de

Jetzt hier einen kostenlosen Erstberatungstermin sichern!

Der Weg ist das Ziel
fahrradfahren
Ursprünglich wurde das Fahrrad als Fortbewegungsmittel erfunden, doch mittlerweile hat man so viele positive Eigenschaften beim Gebrauch entdeckt, dass es auch ein ideales Fitness-Gerät geworden ist.
Besonders für die vielen ‚Dauersitzer‘ ist das Fahrradfahren ein idealer Ausgleich. Denn das ‚Dynamische Sitzen‘ stimuliert nicht nur die Rückenmuskulatur, sondern hält den ganzen Körper in Bewegung. Neben hauptsächlich der Beinmuskulatur werden die kleinen tiefliegenden Muskeln um die Wirbelkörper trainiert. Die rhythmischen Bewegungen der Beine stärken die Muskulatur im Rumpfbereich. Die Schulterpartie sowie die Arme arbeiten beim Lenken und Ausbalancieren ständig mit. Darüber hinaus helfen die asymmetrischen Bewegungen im gesamten Rücken, Verspannungen zu lösen.
Rund 70 % des Körpergewichtes werden vom Rad getragen, das heißt Gelenkschonung pur. Gerade bei übergewichtigen Menschen ist das ein idealer sportlicher Einstieg zur gelenkschonenden Gewichtsreduktion. Gerade die belasteten Knie- und Hüftgelenke sind beim Treten nur sanft gefordert. Dennoch werden bei jeder Bewegung die Gelenkknorpel zusammengepresst und über die Gelenkflüssigkeit mit Nährstoffen
versorgt. Bei nachlassendem Druck fließen die Abbauprodukte aus den Knorpeln ab. Durch diese zyklische Be- und Entlastung werden die Gelenke optimal versorgt und gegen Arthrose vorgebeugt. Von diesen Zug- und Druckbelastungen profitieren genauso die Bandscheiben, die damit gut genährt ihre Pufferfunktion in der Wirbelsäule weiter aufrechterhalten können.
Allerdings entscheidet die richtige Sitzhaltung über rückengesundes Fahren. Selbstverständlich müssen Rahmengröße, Lenker- und Satteleinstellungen ganz individuell auf die Fahrer eingestellt sein. Beim Radeln sollte man den Oberkörper so weit nach vorne neigen, dass der Körperschwerpunkt über den Pedalen liegt. Wird sich zu weit nach vorne gelehnt, bringt das eine Überdehnung der Lendenwirbelsäule mit sich und der Kopf muss zu stark angehoben werden, was den Nacken überlastet. Hingegen in einer extrem geraden Sitzposition geraten die Bandscheiben zu sehr unter Druck. Im Weiteren muss man darauf achten, dass die Handgelenke am Lenker nicht abknicken. Ansonsten überdehnen sich Muskeln und Nerven, was ein unangenehmes Kribbeln hervorrufen kann.
Grundsätzlich ist das Fahrradfahren für jedes Alter ein ideales Herz-Kreislauf-Training, was die Durchblutung und damit das allgemeine Wohlbefinden fördert. Zudem macht es als Gruppensport noch mehr Spaß und bringt Einen auf jeden Fall in mehrfacher Hinsicht weiter.

training
Der Weltmeister im Kunstturnen
Fabian Hambüchen gibt Tipps für einen gesunden Rücken.
Text: Silja Ahlemeyer Foto: Sebastian Spies
Herr Hambüchen, jeder dritte Deutsche klagt über Rückenschmerzen. Was können Betroffene tun?
Das Wichtigste ist die regelmäßige Bewegung, und zwar schon, bevor die Schmerzen auftreten. Wenn man akut betroffen ist, sollte man nicht ruhen, sondern zum Beispiel spazieren gehen. Eine einfache Stabilisationsübung ist eine Plank auf den Knien. Dabei stützt man sich auf die Unterarme, legt die Knie auf der Matte ab und schiebt den Po hoch.
Der Körper bleibt in der Mitte gerade und fest, das trainiert alle relevanten Muskelgruppen. Darauf muss man achten, dass nicht nur der Rücken gekräftigt wird, sondern auch andere Bereiche.
Welche sind das?
In erster Linie die Gesäßmuskeln. Je mehr der Po gestärkt wird, desto besser ist der untere Rücken geschützt. Zudem sind die geraden und seitlichen Bauchmuskeln wichtig.
Worauf ist beim vorbeugenden Rückentraining besonderer Wert zu legen?
Gerade Einsteiger sollten sich zuerst alle Übungen von einem ausgebildeten Trainer zeigen lassen, etwa im Fitnessstudio. Es ist wichtig, Rückenübungen immer sauber und korrekt auszuführen.

Was sind weitere Alltagstipps für einen fitten Rücken?
Setzen Sie sich doch beim Zähneputzen mal in die Kniebeuge; oder stehen Sie währenddessen nur auf einem Bein. Beides ist super für die Balance und stärkt die Körperhaltung.
Sie sind im Musikvideo „Süchtig nach Schmerz“ von Thomas Godoj zu sehen. Das wirft die Frage auf: Darf Rückentraining wehtun oder darf es das gerade nicht?
Was nicht sein soll, ist ein stechender oder beißender Schmerz. Wenn der auftritt, ist das nie gut. Was allerdings schon sein darf, ist, dass die Muskeln während einer Übung ein bisschen brennen. Das gehört dazu.
RÜCKENGESUNDHEIT Eine unabhängige Kampagne von Contentway 52
„Bewegung ist das A und O“
Text: Silja Ahlemeyer Foto: Coen van de Broek/unsplash
Fabian Hambüchen, ehemaliger deutscher Kunstturner, Autor und Keynote-Speaker .
Radfahren ist gelenkschonend, hilft beim Abnehmen und reduziert Stress.
„Je mehr der Po gestärkt wird, desto besser ist der untere Rücken geschützt.“
Der Sattel mit dämpfendem Kern. Gegen Sitzschmerz.
SC Core Prime
Der Komfort-Tourensattel überzeugt durch die patentierte 3D-Bewegungsunterstützung und die geprüft rückenschonende Wirkung des ergonomischen Kerns aus Infinergy®. Erhältlich für Frauen oder Männer gegen Taubheitsgefühle und Sitzdruck. Ergon CORE 3D® – Die Anti-Sitzschmerz-Formel.



SC Core Prime



ergonbike.com
Die Welt_Ergon_SC_Core_248x370_20230309.indd 1 13.03.23 17:07
„Medizin verändern: Heilung braucht Zuwendung, Vertrauen und Mut zu neuen Wegen.“ Dietrich Grönemeyer beschreibt anhand bewegender persönlicher Erlebnisse, was sein Verständnis als Arzt geprägt hat – und was wir tun müssen, um als Gesellschaft zu guter Gesundheit zu fi nden. 288 Seiten, ISBN: 978-3453281561

Prof. Dr. Dietrich Grönemeyer:
großes interview
Der Rückenspezialist Prof. Dr. Dietrich Grönemeyer spricht im Interview darüber, wie man im Homeo� ce Rückenschmerzen vermeiden kann.

Text: Silja Ahlemeyer, Foto: Laura Möllemann Professor Grönemeyer, halten Sie das Homeo� ce aus gesundheitlicher Sicht für Fluch oder Segen?
Die meisten provisorisch eingerichteten Arbeitsplätze zuhause sind ergonomisch schlechter als im Büro, daher ist es häufiger Fluch als Segen. Zuhause neigt man auch eher dazu, Pausen wegzulassen und so regelrecht in der Arbeit zu verkrampfen. Dazu kommt, dass der Arbeitsweg wegfällt. Kein Sprint zum Bus, keine Radtour ins Büro – damit fehlt den meisten selbst dieses bisschen Bewegung am Tag.
Darf man am Schreibtisch auch mal „fl äzen“ statt Geradesitzen?

An sich gibt es kein „falsches Sitzen“, sondern vielmehr zu langes Sitzen in der gleichen, zusammengekrümmten Position – das ist schlecht für den Rücken. Wer langes Sitzen nicht vermeiden kann, sollte wenigstens auf regelmäßige Lockerungsübungen achten und seine Haltung häufi ger korrigieren.
Wie muss ein rückenfreundlicher Stuhl beschaff en sein?

Die Faustregel für Bürostühle: Die Sitzhöhe sollte zwischen 42 und 50 Zentimeter liegen. Das passt für den Großteil der Bevölkerung. Die Rückenlehne sollte außerdem mindestens 50 Zentimeter hoch sein und die Lenden stützen.

Auf welche ergonomischen Gegebenheiten sollte man sonst achten, wenn man im Homeoffice arbeitet?
Richtig sitzt, wer Knie und Ellbogen im rechten Winkel beugt, mit den Fußsohlen auf dem Boden. Für die meisten ist dafür eine Tischhöhe von 72 Zentimetern ideal. Und der Computerbildschirm sollte bei aufrechter Haltung direkt auf Augenhöhe stehen.
Wenn es den Heimarbeiter doch erwischt hat: Was sind die wichtigsten Sofortmaßnahmen gegen Beschwerden im Schulter- und Nackenbereich?
Wenn Entspannungsübungen die Beschwerden nicht lösen, kann Wärme helfen: Kirschkernkissen, Salben, Wickel oder Bäder. Mein Tipp: Rosmarinöl als Badezusatz hilft zusätzlich gegen Muskelverspannungen.
Wie kann man Schmerzen im unteren Rücken lindern, besonders dann, wenn man trotzdem viel am Computer arbeiten muss?
Wärme oder Kälte können lindern, aber besser ist es, diesen Bereich gezielt zu trainieren. In meinem „Großen Rückenbuch“ habe ich eine passen-
sein. So ändert man seine Haltung und lockert Muskeln und Gelenke.“
de Übung: Für den „Rückenkrauler“ braucht man nur eine Sportrolle und eine Wand zum „Kraulen“. Grundsätzlich empfehle ich aber einen ergonomischen Arbeitsplatz, damit es gar nicht erst zu Schmerzen kommt.
Wann sollte man mit Rückenschmerzen zum Arzt?


Bleiben die Schmerzen trotz mehr Bewegung, veränderter Körperhaltung und Massagen unverändert stark, sollte man zum Arzt gehen. Auch akute Beschwerden wie Taubheitsgefühle oder Muskelschwäche müssen sofort abgeklärt werden. Operationen können in vielen Fällen bei leichten Bandscheibenvorfällen durch eine Kombination von Mikrotherapie mit Krankengymnastik und Osteopathie vermieden werden.
Auf der anderen Seite bitte nie vergessen: Mit gezielten Dehnübungen lassen sich viele Schmerzen beheben – denn 80 Prozent der Rückenbeschwerden sind auf Verspannungen der Muskeln und Faszien zurückzuführen.
Für viele heißt Homeoffice auch: mit dem Laptop auf der Couch arbeiten. Was ist daran problematisch und was wäre eine gesündere Alternative? Laptops eignen sich weniger fürs Homeoffi ce – durch sie krümmt man sich schnell. Ein Wechsel auf die Couch dagegen kann zwischendurch sogar gut sein. So ändert man seine Haltung und lockert Muskeln und Gelenke. Doch dauerhaft ist das keine geeignete Alternative, besonders wenn am Laptop getippt wird.
Die Menschen nutzen auch ihr Handy immer mehr zum Arbeiten. Dabei kann es zum sogenannten „Smartphone-Nacken“ kommen. Was ist das? Neueste Technik beeinflusst uns nicht immer zu unserem Vorteil. Smartphones und Tablets verleiten zu einer Fehlhaltung: Ständig steht oder sitzt man mit gesenktem Kopf da. Das kann zu Rücken- und Kopfschmerzen oder Nackenproblemen führen, denn schon eine leichte Beugung des Kopfes kann den Nacken mit 20 Kilogramm belasten. Was können Handynutzer dagegen tun?
Eine möglichst neutrale Haltung einnehmen – sprich: das Smartphone auf Augenhöhe bringen und lieber die Augen als den Kopf bewegen. Wie bei der Arbeit im Homeoffi ce gilt außerdem auch bei Smartphones: Regelmäßig kurze Pausen vom Bildschirm einlegen und zwischendurch Lockerungsübungen für Schultern und Hals machen. Und öfter in die Ferne schauen – das entspannt Augen- und Nackenmuskulatur.
„Operationen können in vielen Fällen bei leichten Bandscheibenvorfällen durch eine Kombination von Mikrotherapie mit Krankengymnastik und Osteopathie vermieden werden.“
RÜCKENGESUNDHEIT Eine unabhängige Kampagne von Contentway 54
„Ein Wechsel auf die Couch dagegen kann zwischendurch sogar gut
Homeo�ce: Locker bleiben statt steif sitzen
Frühe Korrekturen
vorbeugen
Warum Wirbelsäulenverformungen wie Skoliose und Kyphose so früh wie möglich korrigiert werden sollten, erklärt die Orthopädin

 Dr. Anna Katharina Doepfer.
Dr. Anna Katharina Doepfer.


idiopathische Skoliose, also ohne bekannte Grunderkrankung entstanden, verschwindet nicht von selbst. Dasselbe gilt auch für Kyphosen. Aber: Beide Fehlstellungen lassen sich im jungen Alter gut behandeln. Deswegen ist Früherkennung so wichtig!
Also besteht eher die Gefahr der Verschleppung?
Gibt es eigentlich ideal geformte Wirbelsäulen beziehungsweise ab wann sind Verformungen krankhaft?
Ja, es gibt schön geformte, gerade Wirbelsäulen. Die meisten Wirbelsäulen weisen jedoch kleinere, meist unbedenkliche Abweichungen auf. Ist die Wirbelsäule zur Seite hin „verbogen und verdreht“, spricht man ab einem Verkrümmungsgrad von 10 Grad von einer Skoliose. Eine unnatürliche Krümmung der Wirbelsäule nach vorne wird Kyphose (Rundrücken) genannt. Eine Röntgenuntersuchung gibt Aufschluss über die konkrete Diagnose.
Wie groß ist die Chance, dass sich Verformungen bei Kindern wieder verwachsen?
Das ist sehr abhängig von der Ursache. Mögliche Beinlängendifferenzen als Ursache können korrigiert werden. Skoliotische Fehlhaltungen unter 10 Grad können beobachtet werden und erfordern meist keine Intervention. Eine diagnostizierte
Ja. Leider klafft zwischen der letzten U10/11-Kinderuntersuchung und der J1 eine Lücke von zwei bis vier Jahren. Eine Skoliose entsteht meist während Wachstumsphasen. Mädchen, welche deutlich häufiger von idiopathischer Skoliose betroffen sind, erleben kurz vor ihrer ersten Periode einen besonders großen Wachstumsschub. Ich habe schon ausgewachsene 14-jährige Mädchen in meiner Praxis gehabt – aus therapeutischer Sicht fast schon tragisch, denn je mehr Behandlungszeit bis zum Wachstumsabschluss existiert, desto erfolgversprechender ist die Therapie. Deren oberstes Ziel ist, die Krümmung bei Wachstumsabschluss so gering wie möglich zu halten.
Welche Therapiemöglichkeiten gibt es?

Die Wahl der geeigneten Therapieform hängt, neben der Ursache und dem Schweregrad, vom Patientenalter und dem wahrscheinlichen Krankheitsverlauf ab. Bei milden Formen von Skoliose und Kyphose erzielt Physiotherapie gute Ergebnisse. Oft ist ab einem Krümmungswinkel von 20 Grad das Tragen eines Korsetts indiziert. Mit diesen beiden konservativen Methoden sollen Operationen primär vermieden werden. In manchen Fällen ist eine OP jedoch dennoch angeraten, um Folgeschäden oder Schmerzen zu reduzieren – auch bei Jugendlichen.
Was ist mit erwachsenen Patienten?

Wenn keine Grunderkrankungen die Verformung verursacht haben, leiden diese entweder unter den Folgen nicht
korrigierter Verformungen im Kindesalter oder unter Verformungen aufgrund von altersbedingter Abnutzung, beziehungsweise einer Kombination von beiden. Ein Korsett (gebaut wie bei den Jugendlichen) macht bei dieser Patientengruppe keinen Sinn mehr. Hier kann Physiotherapie oft helfen, ggf. auch eine Operation. Sollten andere Ursachen eine Rolle spielen, wie z. B. eine Osteoporose, müssen diese ursächlich therapiert werden.
Welche Rolle spielen Matratzen für den Rücken?

Vorbeugen lassen sich Verformungen also nicht?
Dass Vitamin D und Sport Skoliosen oder Kyphosen verhindern können, würde niemand behaupten. Allerdings machen eine knochengesunde Ernährung und Muskeltraining ein Leben lang Sinn, da sie die Rückengesundheit und zumindest das Ausmaß von Verformungen immer positiv beeinflussen.


fakten Mittels Röntgenaufnahme der Hand lässt sich das tatsächliche Knochenalter bestimmen , welches vom biologischen Alter abweichen und Rückschlüsse über das Ende der Wachstumsphase geben kann. Zur Kontrolle des Therapieverlaufs kann mittlerweile auf andere Messverfahren zurückgegriff en werden, um die Strahlung so gering wie möglich zu halten.
Rückenschmerzen?
Entdecken Sie unsere JuzoPro Lumbalorthesen
Um den Körper beim Schlafen vollständig zu entspannen, sollte die Wirbelsäule – in der Seitenlage auf der Matratze – vom Hals bis zum Steißbein waagerecht ausgerichtet sein. Mit der richtigen Matratze sinken Schultern und Hüften ein, während die Taille gestützt wird. Auch die Wahl des Kopfkissens ist entscheidend, da es die Halswirbelsäule zusätzlich stützt und somit ergonomisches Schlafen ermöglicht.
Worauf sollte beim Kauf eines Bettes geachtet werden?
Ein qualitativ hochwertiges Bett sollte immer auf die individuellen Bedürfnisse des Körpers ausgelegt sein. Für die richtige Ergonomie und ein perfektes Liegegefühl sollten Lattenrost oder Unterfederung sowie Matratze und Kopfkissen auf den Körpertyp abgestimmt sein.
Wie sollten die Lagen eines Boxspringbettes aufgebaut sein? Ein Boxspringbett besteht aus Box, Matratze und Topper. Die ersten beiden Ebenen unterstützen und entlasten den Körper und sollten unter anderem aus Taschenfederkernen bestehen. Der Topper sorgt für ein besonders gemütliches Liegegefühl.
Text: Katja Deutsch, Foto: Presse
ANZEIGE
Ursachen und was dagegen hilft. Lebensfreude in Bewegung
55 RÜCKENGESUNDHEIT Eine unabhängige Kampagne von Contentway
Text: Kirsten Schwieger
Foto: Doepfer
Wer ergonomisch gesund schläft, schläft richtig gut!
„Eine knochengesunde Ernährung und Muskeltraining machen ein Leben lang Sinn, da sie die Rückengesundheit und zumindest das Ausmaß von Verformungen immer positiv beeinflussen.“
Dr. Anna Katharina Doepfer, Orthopädin
Anna Havermann, Senior Marketing & Communications Manager bei Auping
Ergonomie im Haus beginnt schon bei der Partnerwahl

ergonomisches zuhause


Eine rückenschonende Einrichtung verhindert die Entstehung von Schmerzen. In der Küche und am Esstisch lässt es sich leichter ergonomisch planen, wenn die Partner ähnlich groß sind.
Im Arbeitsumfeld wird Ergonomie, also die Anpassung der Arbeitsumgebung an menschliche Bedürfnisse, schon seit vielen Jahren erforscht, zuhause achten wir dagegen oftmals spürbar zu wenig darauf. Ob in der Küche, im Badezimmer, im Wohnzimmer oder beim Schlafen, die Auswirkungen ergonomisch ungünstig gestalteter Umgebung lässt sich tatsächlich schnell spüren – in Form von Schmerzen an Rücken, Hals, Hüfte und Knie.




Man könnte sagen, Ergonomie beginnt sozusagen bereits vor dem Einzug in eine gemeinsame Wohnung, nämlich mit der Auswahl des Partners: Wenn der Partner oder die Partnerin in etwa die gleiche Größe hat wie man selbst, lässt sich die Einrichtung und Gestaltung der Wohnung viel leichter planen als bei 30 Zentimeter Größenunterschied. Dieser Größenunterschied spielt eine wichtige Rolle bei der Höhe der Arbeitsplatte in der Küche, die Höhe der Spüle und die Höhe der Oberschränke. Denn zum Kochen und Abspülen soll man weder ständig die Schultern hochziehen müssen, weil Arbeitsplatte und Kochfeld zu hoch angebracht sind, noch soll man sich ständig nach unten bücken, weil man zu groß dafür ist. Dasselbe gilt für den Esstisch: Gut zu sitzen bedeutet, mit geradem Rücken bequem auf dem Stuhl zu sitzen, der den Rücken stützt und es ermöglicht, mit den Beinen bequem im 90-Grad-Winkel den Boden zu errei-
chen. Die Stuhlkante soll dabei nicht in die Kniekehle drücken. Kann man seine Arme bequem in einer 90-Grad-Abwinkelung auf der Tischplatte ablegen und ohne Anstrengung das Besteck greifen,
Schlafexperten und Physiotherapeuten raten dazu, möglichst flach auf dem Rücken zu schlafen und eher eine härtere Matratze zu wählen.
sitzt man richtig. Wer den Herd unter der Arbeitsplatte eingebaut hat, tut gut daran, auf richtiges Bücken achten: Aus den Knien hebt man schonender als aus dem Rücken, deshalb lieber Kniebeugen machen beim Heben des schweren Bräters als einen Rundrücken. Dasselbe gilt für das Tragen von Wasserkästen.
Die zur Körpergröße passende Höhe betrifft noch weitere Punkte: Auch Waschbecken im Badezimmer und die Anbringung der Waschmaschine spielen eine wichtige Rolle hinsichtlich ergonomischer Faktoren.
Ab in die Kiste
Da wir etwa ein Drittel unseres Lebens im Bett verbringen, macht es durchaus Sinn, hier auf ein gutes Zusammenspiel von Bettgestell, Lattenrost und Matratze zu achten. Die teuerste Matratze bringt nichts, wenn der darunterliegende Lattenrost nicht dazu passt. Härte- und Wärmegrad lassen sich individuell an jedes Bedürfnis anpassen. Auch die Schlafposition ist wichtig, doch diese lässt sich leider nicht erwerben, muss man sie sich angewöhnen. Viele Menschen, die den ganzen Tag in sitzender Haltung am Schreibtisch verbringen, nehmen diese Haltung dann auch liegend ein und schlafen auf der Seite, mit angewinkelten Beinen und rundem Rücken und am besten noch mit dickem Kopfkissen – ein Garant für Schmerzen.

Schlafexperten und Physiotherapeuten raten dazu, möglichst flach auf dem Rücken zu schlafen und eher eine härtere Matratze zu wählen. Auch hier sind die Paare mit ähnlicher Statur deutlich im Vorteil. Um Schmerzen vorzubeugen, tut es gut, stündlich aufzustehen und sich zu strecken und regelmäßig den Kopf von rechts nach links zu drehen. Auch tägliche Bewegung (es muss nicht unbedingt schweißtreibender Sport sein, rasches Spazierengehen reicht auch!) ist sehr ergonomisch und erhält einen gesunden Körper.

Gut zu sitzen bedeutet, mit geradem Rücken bequem auf dem Stuhl zu sitzen,der den Rücken stützt und es ermöglicht,mit den Beinen bequem im 90-Grad-Winkel den Boden zu erreichen. ANZEIGE

RÜCKENGESUNDHEIT Eine unabhängige Kampagne von Contentway 56
Text: Katja Deutsch Foto: Susanna Marsiglia/unsplash
Tipps für besseren Schlaf
Wer im Homeoffice arbeitet, sollte eine separate Maus und Tastatur nutzen, um eine ergonomischere Arbeitshaltung zu ermöglichen.
Ausgeschlafen mit Auping
Wer gut sitzt, kündigt seltener
ergonomisch arbeiten Nicht nur cholerische Chefs, auch körperliche Schmerzen können ein Kündigungsgrund sein – nämlich dann, wenn sie ihren Ursprung in nicht-ergonomisch gestalteten Arbeitsplätzen haben.

Man kündigt nicht einem Unternehmen, sondern einem Chef“, heißt es oft. Manchmal sollte man jedoch auch einem schlecht gestalteten Arbeitsplatz kündigen. Wenn das Unternehmen zu wenig Wert auf Ergonomie am Arbeitsplatz, auf Werkzeuge und Arbeitsabläufe legt, riskiert es, Gesundheit, Sicherheit und Leistungsfähigkeit seiner Mitarbeiter zu gefährden.
Wer als Arbeitgeber hier spart, spart am falschen Ende, denn eine nicht nach ergonomischen Gesichtspunkten gestaltete Arbeitsumgebung verursacht schnell (Rücken-)schmerzen. Geht man jetzt der Ursache nicht auf den Grund, können sie
unerträglich werden und das Arbeiten unmöglich machen: Rückenschmerzen haben im letzten Jahr zu 354 Fehltagen je 100 Versicherte geführt – ein neuer Rekord.
Ob im Krankenhaus oder Pflegeheim, im Friseursalon oder der Hotelküche, in jedem Berufsumfeld kann gute Ergonomie dabei helfen, Muskel-Skelett-Erkrankungen, Augenbelastungen und anderen gesundheitlichen Problemen vorzubeugen.
Doch nicht nur in körperlich anstrengenden Berufen profitieren die Mitarbeiter von guter ergonomischer Ausstattung, auch Büroarbeitsplätze sollten nach ergonomischen Gesichtspunkten gebaut und eingerichtet werden.
Vor allem das Zusammenspiel aus Tisch und Stuhl spielt hierbei eine wichtige Rolle, denn ein Arbeitstisch in falscher Höhe verursacht Schmerzen. Ist er zu hoch, sodass die Arme nicht bequem im rechten Winkel auf der Tischplatte liegen können, ziehen viele Menschen automatisch die Schultern hoch, um die unpassende Höhe
zu kompensieren. Ist er zu niedrig, besteht die Gefahr, den ganzen Tag mit Buckel zu arbeiten. Um in Bewegung zu bleiben, hat sich ein zusätzliches Stehpult, beispielsweise zum Telefonieren, als sehr positiv erwiesen.
Ein in der Höhe, nach hinten und zur Seite unflexibler Bürostuhl verursacht ebenfalls Schmerzen, da der Körperbau von uns Menschen nicht für langes, starres Sitzen gemacht ist. Auch ein Bildschirm in falscher Höhe und Neigung führt zu Schmerzen und strengt zudem die Augen übermäßig an. Die Platzierung des Monitors sollte so erfolgen, dass die Augen des Mitarbeiters auf die oberste Zeile des Monitors blicken, ohne den Kopf in eine unbequeme Position zu zwingen. Ein ausreichend großes Display und eine klare Schriftgröße tragen dazu bei, die Belastung der Augen zu minimieren, eine externe Tastatur bei Laptops sorgt für unverkrampftere Handhaltung. Tische, Stühle, Tastatur, Maus und auch das Licht sollten also flexibel und individuell einzustellen sein. Ein Linkshänder benötigt das Licht von rechts, ein Rechtshänder von links.
Ein weiterer wichtiger Aspekt sind neben der Reduzierung von Lärm und Stressfaktoren eine angenehme Raumtemperatur mit der Möglichkeit, im Winter ausreichend zu heizen und im Sommer zu verschatten.
Ein weit entfernter Raum für den Drucker und eine Kantine, die sich außerhalb des Bürogebäudes befindet und nur mit einem Gang an der frischen Luft erreichen lässt, zwingt die Angestellten übrigens ganz selbstverständlich zu mehr Bewegung. Unternehmen sollten sich daher bemühen, ergonomische Arbeitsplätze und Arbeitsbedingungen zu schaffen und ihre Mitarbeiter in Sachen Ergonomie zu schulen, um sie gesund und zufrieden zu halten – und sie somit zu behalten.
Exoskelette im Einsatz gegen Rückenschmerzen

Muskel-Skelett-Erkrankungen sind bei den Mitarbeitern in Fertigung und Logistik leider an der Tagesordnung. Das Fraunhofer-Institut für Produktionstechnik und Automatisierung sieht als Hauptursache unergonomische Arbeitsbedingungen, wie das Arbeiten in anstrengenden Haltungen oder das Heben und Tragen von schweren Gegenständen. Doch es gibt Lösungsansätze, etwa durch Exoskelette.
Ein Exoskelett ist eine äußere Stützstruktur ähnlich einer abnehmbaren Orthese. Es dient zum Heben schwerer Lasten. Ein Exoskelett unterstützt und verstärkt die Bewegungen des Trägers, indem zum Beispiel Servomotoren die Gelenke des Roboteranzugs antreiben. So werden Teile der aktiven Muskelarbeit übernommen. Damit sollen Belastungsverletzungen und Schmerzen, insbesondere am Rücken, vermieden werden. Die Leitlinie „Einsatz von Exoskeletten im beruflichen Kontext zur Primär-, Sekundär-, und Tertiärprävention von arbeitsassoziierten muskuloskelettalen Beschwerden“ gibt eine sicherheitstechnische Beurteilung dieser Hilfsmittel.
Text: Silja Ahlemeyer, Foto: Anna Shvets/pexels
ANZEIGE
BionicBack
Das Exoskelett für Deinen Arbeitsalltag

57 RÜCKENGESUNDHEIT Eine unabhängige Kampagne von Contentway
Text: Katja Deutsch
Foto: Andrea Piacquadio/pexels
„
SIE BIETEN
DIEJENIGEN, DIE TÄGLICH SCHWERSTARBEIT LEISTEN. UNSER TECHNISCHER BEITRAG DIENT ZUR ERFÜLLUNG EINER GROßEN ERLEICHTERUNG. WIR LIEBEN ZUKUNFTSTECHNOLOGIE UND STREBEN TECHNISCHE ERLEICHTERUNG FÜR JEDEN AN. www.htrius.com
Schlecht ausgestattete Bildschirmarbeitsplätze verursachen Muskel- und Skeletterkrankungen.
UNSERE SYSTEME HELFEN MENSCHEN!
EINEN MEHRWERT FÜR ALL
Abwechslung tut dem Rücken gut
prävention

Universitätsprofessor Ingo Froböse von der Deutschen Sporthochschule Köln gibt Tipps, um Schmerzen im Rücken zu vermeiden und im Alltag aktiv zu werden.

Text: Silja Ahlemeyer
Foto: Presse, Ingo Froböse, Rückenschmerzen kennen die meisten Menschen. Was sind die häufigsten Ursachen dafür?
Die Ursache Nummer 1 ist sicherlich die körperliche Inaktivität, das Nicht-Beachten der eigenen Bedürfnisse. Wir schenken unserem Rücken oft viel zu wenig Aufmerksamkeit. 90 Prozent der Rückenschmerzen etwa stammen aus Unterforderung; nur zehn Prozent der Patienten haben Schmerzen durch eine Überforderung, zum Beispiel im Job.
Dass man mit Bewegung diesen Rückenschmerzen vorbeugen kann, liegt also auf der Hand. Doch welche Sportarten eignen sich dafür am besten?
Jede Bewegung ist besser als keine. Gut ist es, zwischen Ausdauersportarten und Muskeltraining abzuwechseln. Man kann Fahrrad fahren, schwimmen oder walken kombinieren mit Körperübungen zuhause oder im Fitnessstudio. Meine Lieblings-
übung für die Lendenwirbelsäule beispielsweise ist der „Hacker“. Da legen Sie die Oberarme an, bilden mit den Unterarmen einen 90-Grad-Winkel nach vorne, Daumen zeigen nach oben. Dann führen Sie blitzschnell kleine Hackbewegungen aus, wie beim Zwiebelhacken. Zweimal 30 Sekunden lang, das stärkt die wichtige Tiefenmuskulatur. Was auch gut ist: Auf dem Stuhl zu pendeln. Besonders, wenn man viel vor dem Computer sitzt. Also mal den Kopf auf den Oberschenkeln ablegen, dann wieder nach oben hinten durchstrecken, sich nach rechts und links zur Seite neigen. Ganz einfach.
Wie oft in der Woche sollte man trainieren?
Ich empfehle ein tägliches Muskeltraining und zwei bis drei Stunden Ausdauersport wöchentlich. Dabei ist die Variation wichtig, man sollte also nicht immer nur das Gleiche machen, sondern zwischen den Sportarten wechseln. Für Beschwerden im Schulter-Nacken-Bereich müssen Betroffene auch auf eine Abwechslung zwischen Dehnen und Anspannen achten.
Welchen Tipp geben Sie Leuten, die wenig Zeit für den Sport haben?
Ach, wenn man sagt, man hätte keine Zeit, hat man doch eigentlich keine Lust! Schließlich hat die Woche 168 Stunden,
da wird man doch zwei bis drei fi nden, in denen man sich bewegen kann. Und gegen die Unlust hilft es, sich selbst positive Erlebnisse zu schaffen. Man sollte sich zuerst einmal kleine Ziele setzen und sich belohnen, wenn man diese erreicht hat. Eine Motivation zirka alle sechs bis acht Wochen tut gut. Denn wir wissen durch Studien, dass nach zwei Monaten bei vielen Menschen ein Motivationstief ins Haus steht. Dann kann man sich als Belohnung für das Durchhalten zum Beispiel ein neues Paar Turnschuhe gönnen oder ein schönes Abendessen im Restaurant. Und: Bewegung kann man doch ganz einfach in den Alltag integrieren, etwa morgens zur Arbeit spazieren oder Radfahren, statt immer das Auto zu nehmen.
Bald beginnt die Gartensaison. Welche Tipps haben Sie für Unkrautjäter und Menschen, die gern im Garten buddeln, um Rückenschmerzen zu vermeiden?
Wer bei der Gartenarbeit Rückenschmerzen hat, der hat den ganzen Winter lang nichts getan. Deshalb heißt es jetzt: Den Körper vorbereiten. Sie gehen ja auch nicht ohne Vorbereitung zum Skifahren. Machen Sie auch vor dem Unkrautzupfen Ihre Muskelübungen. Die Gartenarbeit ist eine ungewohnte Belastung. Deswegen sollte man auch erst
langsam einsteigen und nicht sofort den ganzen Garten auf einmal umgraben.
9 Regeln für einen optimalen Sto� wechsel

In diesem Workbook fasst Ingo Froböse die wichtigsten Regeln für alle Über-40-Jährigen zusammen, die ihren Stoff wechsel verbessern wollen. Der alltagstaugliche Ratgeber deckt die wichtigen Lebensbereiche Ernährung, Bewegung und Regeneration ab.
500 Millionen Menschen werden nach Befürchtungen der Weltgesundheitsorganisation WHO bis zum Jahr 2030 an den Folgen von Bewegungsmangel erkranken. Die Empfehlung der WHO: Mindestens 150 Minuten sollten sich Erwachsene pro Woche körperlich betätigen. Dabei weisen die Experten der Fitnessbranche eine Schlüsselrolle zu. Diesen Auftrag nimmt die FIBO an und treibt mit neuen Initiativen und Formaten den Trend von gesundheitsorientiertem Fitnesstraining substanziell weiter. Mit ihrem neuen „Health Ambassador“, dem renommierten Sportwissenschaftler Ingo Froböse, Professor für Rehabilitation und Prävention an der Sporthochschule Köln, macht die FIBO den Wert von Fitness für die Gesundheit zudem für die breite Masse sichtbar und erlebbar.
„Fitness und Bewegung schaffen die Grundlage für körperliche Gesundheit. Uns ist es wichtig, die Schlüssel- und Vorreiterrolle der Fitnessbranche für die Gesundheit der Menschen deutlich darzustellen und
die Akteure der Branchen auf der Messe zusammenzubringen“, so Silke Frank, Event Director der FIBO. „Unsere Mission ist es, die breite Öffentlichkeit für einen gesunden, aktiven Lebensstil zu sensibilisieren, zu begeistern und aufzuzeigen, wie es geht.“
Die größten Trends live zum Ausprobieren Begeistern wird die FIBO ihre Besucher u.a. mit den größten Fitnesstrends zum Mitmachen und der Möglichkeit, sich mit Stars und Athleten auszutauschen. Sie können sich beim Cycling, Hula Hoop und Step Dance auspowern oder die neusten Yoga- und Pilates Sessions für sich entdecken. Kraftvoll wird es mit dem größten Trend des Jahres: HYROX. Die weltweite Challenge vereint mit Functional Training, HIIT und Running gleich drei Trainingsmethoden in einem und bietet auf der FIBO erstmals einen Wettkampf für jedermann. Ganz neu in diesem Jahr widmet sich die Messe auch verstärkt den Themenfeldern eSports und Gaming und zeigt: Fitness und Gaming gehören zusammen. Besucher können mit beliebten Gamern an der Konsole konkurrieren und bekannte Creator kennenlernen.

Fachexperten bieten außerdem hilfreiche Tipps, wie die Gesamtperformance durch entsprechende Ernährung verbessert werden kann, und welche Rolle die Regeneration im ambitionierten eSport spielt.
Fortbildungen und Expertentalks auf Top Niveau Ihr Weiterbildungsangebot für Fachbesucher baut die FIBO weiter aus und verzahnt Theorie und Praxis noch
enger miteinander. Dabei liefern renommierte Fachreferenten in zahlreichen Vorträgen und Diskussionsrunden innovative Impulse für den Berufsalltag und das eigene Business. Die Themen Gesundheitsprävention und Ernährung, mentale Fitness und das Management von Gesundheits- und Fitnesseinrichtungen deckt u.a. der FIBO Congress ab, der von Experten der BSA-Akademie und der Deutschen Hochschule für Gesundheit & Prävention (DHfPG) gestaltet wird. Das neue Sports Medicine und Physiotherapy Symposium von Thieme und der sportärztezeitung bringt wiederum Sportmediziner und Physiotherapeuten zusammen, bündelt ihre Kompetenzen und liefert innovative Diagnostik-, Therapie- und Trainingsmethoden.
Sichern Sie sich jetzt Ihr Ticket: www.fibo.com


RÜCKENGESUNDHEIT Eine unabhängige Kampagne von Contentway 58
Ingo Froböse, Universitätsprofessor an der Deutschen Sporthochschule Köln
ADVERTORIAL
© FIBO RX
&
Fotos:
Austria
Germany
Aktiv und gesund: Weltweit größte Messe für Fitness, Wellness und Gesundheit zeigt wie
Unsere Aufsteh- und Pflegesessel zeichnen sich durch hervorragende Ergonomie, besten Sitzkomfort und vielfältige Verstellmöglichkeiten aus. Vertrauen Sie auf TOP-Qualität aus dem Saarland.
























Wir













ENZYMAX® K























Mit Papaya, Ananas, Citrus-Bioflavonoiden, Selen, Mangan, Vitamin C und Biotin + Vitamin K2 und Zink tragen zur Erhaltung

ANZEIGE orthim GmbH & Co. KG Otto-Hahn-Straße 17 – 19 33442 Herzebrock-Clarholz www.orthim.de Nahrungsergänzungsmittel sind kein Ersatz für eine ausgewogene, abwechslungsreiche Ernährung und eine gesunde Lebensweise. „Ich bleib̓ beweglich“ ©ViDi Studiostock.adobe.com
normaler
Vitamin
einer
Mehr Infos auf: www.orthim.de oder unter 0 52 45 . 92 01 00
Werktage
Beratung Nachhaltig und fair Großer Onlineshop
Knochen bei +
D3 trägt zur Erhaltung
normalen Muskelfunktion bei
Made in Germany Lieferzeit 2-4
Persönliche
zu
beraten Sie gerne persönlich
dem für Sie ideal geeigneten Sessel: Tel. 06854 803081
Tun Sie Ihrem Rücken auch beim Sitzen Gutes. Mit einem Sessel von Devita.
Höchster Komfort beim Sitzen www.devita-online.de
KostenloseProbeSoli-Öl erhältlichdirektvomHerstellergegen Einsendungdieses Original-Coupons


Naturreine ätherische Öle


sind das flüssige Gold der Pflanzen – sie konzentrieren i n sich die Kraft der Sonne, des Lichts und der Natur.








Diese













Kraft wird gebündelt in einer altbewährten Mischung der wertvollsten naturreinen ätherischen Öle: Soli-Chlorophyll-Öl S 21.

Vor über 80 Jahren schon entwickelte der Heilkundige Erich Reinecke diese wirkungsvolle Kräuterölmischung, die Selbstheilungskräfte anregt und entspannend und ausgleichend auf den ganzen Organismus wirkt. Energiebahnen werden geöffnet, energetische Blockaden gelöst. Damit wird das Öl zu einem unverzichtbaren Begleiter bei inneren und äußeren Verspannungen. Es lockert und löst von innen heraus und intensiviert Massage-Behandlungen.
Soli-Chlorophyll-Öl S 21






Das Soli-Öl ist durch seine engergetische Wirkung ein wertvoller Begleiter durch den ganzen Tag und bei vielen Unpässlichkeiten des Alltags wie Verspannung, Erschöpfung, Konzentrationsschwäche oder Erkältungsgefahr. Man kann es einreiben, einatmen, als Badezusatz und Saunaaufguss verwenden oder auch im Raum verdampfen.

Bei Erschöpfung und Konzentrationsproblemen können Sie Ihre Lebensgeister wieder wecken, indem Sie sich Stirn, Schläfen und Nacken mit Soli-Chlorophyll-Öl S 21 einreiben.


Stärken Sie Ihre Vitalkräfte, indem Sie jeden Morgen einen Tropfen Soli-Chlorphyll-Öl S 21 in Ihren Händen verreiben und das Öl in 10 bewussten Atemzügen direkt aus Ihren Händen tief einatmen.
Sitzende Tätigkeiten und Computer-Arbeit Ver bele
Sitzende Tätigkeiten und Computer-Arbeit führen bei immer mehr Menschen zu Verspannungen von Schultern, Nacken und Rücken. Eine ausgleichende Gymnastik ist wichtig. Zusätzlich kann Soli-Chlorophyll-Öl S 21 die betroffene Muskulatur durch seine Tiefenwirkung erfrischen, lockern und beleben.
Massieren Sie das Öl mehrmals täglich sanft ein und, wenn möglich, halten Sie die betroffenen Stellen anschließend warm. Besonders effektiv ist die regelmäßige Anwendung vor dem Schlafengehen, weil die Bettwärme die Wirkung des Öls intensiviert.
Gönnen Sie sich Verschnaufpausen, in denen Sie Körper, Geist und Seele z. B. mit Meditation oder Yoga wieder zueinander führen. Soli-Chlorophyll-Öl S 21 unterstützt Sie dabei, indem es Energien leichter fließen lässt. Verdampfen Sie dazu das Öl im Raum oder geben Sie einen Tropfen auf Stirn und Brust.


Viel Freude und Entspannung mit dieser wundervollen Kräuterölmischung wünscht Ihnen
Karin Ziegler
SOLIFORM Erich Reinecke GmbH
Oberstr. 73 a 45134 Essen Tel.: 0049-(0)201-473626 www.soliform.de info@soliform.de
betrof
BESUCHEN SIE UNS ONLINE















 Großes Interview | Anna Adamyan
Großes Interview | Susanne Klehn
Großes Interview | Anna Adamyan
Großes Interview | Susanne Klehn

Dr. Anna Katharina Doepfer.
Dr. Anna Katharina Doepfer.

































































